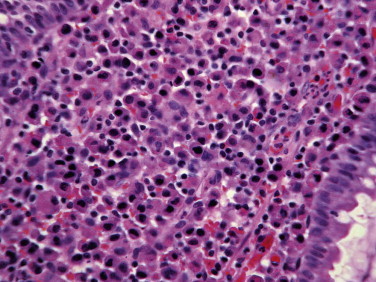
Figure 29-41

Stomach
Brian Wilcock
Like other portions of the gastrointestinal (GI) tract with which it shares embryologic origin, the stomach consists of a tunica muscularis, submucosa, muscularis mucosa, and an innermost mucosa. Almost all of the histologic lesions of clinical significance arise within the mucosa, so endoscopic biopsies are preferred to full thickness biopsies for investigation of almost all gastric diseases. The only exceptions are those that seem restricted to the submucosa or tunica muscularis based on ultrasonographic evaluation (i.e., suspected smooth muscle tumors, pythiosis, and pyloric muscular hypertrophy). The advantages of endoscopic biopsies over full thickness samples have been described elsewhere, but from the perspective of the pathologist the advantages are the greater number of samples that can be taken and the ability to specifically sample abnormal mucosa. The small size and limited depth of the samples are not usually problematic.
Gastric mucosa is similar to that of other portions of the GI tract in that it has a luminal surface of columnar epithelium rich in goblet cells, branched or coiled glands embedded in a fibrovascular lamina propria, and a population of resident leukocytes within the lamina propria. Because the stomach is adapted primarily for secretion rather than absorption, and because its acid environment does not permit much of a resident bacterial population, the leukocyte population is less than is found in the more distal portions of the GI tract. That should make detection of changes in leukocyte numbers easier than elsewhere in the GI tract. That same inhospitable environment also means that there are few infectious causes of gastritis compared with the numerous viral, bacterial, and protozoal diseases of the small and large intestine.
The stomach is divided into several anatomic regions that differ in histologic character and function. Most proximal is the cardia, which surrounds the entry of the esophagus into the stomach, and most distal is the pyloric antrum leading to the sphincter that separates the stomach from the duodenum. In between, and occupying about two-thirds of the stomach, is the gastric body. The gastric fundus is an outpouching of the gastric body at its proximal end where it joins the cardia. This nomenclature is not absolutely standardized, and many authors refer to the combined fundus and body as the “fundic region” and habitually refer to biopsies from this region as being from “fundic mucosa.”1, 2 Each of these regions has distinctive histologic appearance, but the transition from one portion to the other is not abrupt and in some biopsies the mucosa has an appearance intermediate between one region and the other.
Almost all gastric biopsies, whether endoscopic or full thickness, are taken from the fundic mucosa and from the pyloric antrum. In all regions, the mucosa is divided into three horizontal zones. In the fundic/body region, the deepest 60% to 80% of the mucosa is occupied by densely packed branched glands consisting of mucus-producing cells and a variety of secretory cells. The glands are connected to the luminal surface by a narrow neck known as the foveola. In contrast to the more distal portions of intestine, the germinal population for all of the gastric epithelium lies at the junction between the glands and the foveolae, a region known as the isthmus, rather than at the base of the glands (Fig. 29-1 ). These germinal cells migrate upward to replenish the mucus neck cells and surface epithelium, and downward to repopulate the glands as part of normal mucosal turnover and in the event of unexpected epithelial loss. The overall mucosal turnover time is 4 to 5 days—a time that dictates the speed of wound healing, and the rate at which shallow ulcers disappear. The risk of a false-negative biopsy result when investigating episodic gastric disease has not been sufficiently emphasized.
Figure 29-1.

Normal canine fundic mucosa. The glands occupy 80% of the mucosal thickness and are densely packed with almost no intervening connective tissue and very few leukocytes. The inconspicuous germinal population lies at the junction between the glands and the foveolae, a region known as the isthmus.
The glands are populated by a mixture of pyramidal, brightly eosinophilic cells that produce hydrochloric acid and cuboidal chief cells with a more basophilic, foamy cytoplasm containing secretory granules of various types including precursors of pepsin and zymogen. Chief cells predominate in the deeper two-thirds of the fundic glands. Mucus-filled columnar cells similar to mucus neck cells persist throughout the full length of the glands. The fourth and final cellular constituent of the epithelium consists of neuroendocrine cells that are inconspicuous in routine histologic preparations.
The glands are separated from the underlying muscularis mucosa by a layer of dense fibrous tissue that varies substantially in thickness. They are separated from one another by a very small amount of fibrovascular lamina propria containing a mixture of lymphocytes, plasma cells, mast cells, and eosinophils. In the normal fundic stomach, the fibrous tissue and the leukocytes are most visible in the superficial 20% of the mucosa. The deeper glands are packed against each other with essentially no intervening lamina propria (Fig. 29-2 ). Defining the normal reference range for the fibrous tissue and for each cell population is essential to the proper identification and classification of gastric inflammatory disease—a goal that remains elusive.
Figure 29-2.

Persistent shallow gastric ulceration, with flattening and basophilia of the surface epithelium combined with loss of the foveolar mucus neck cells in favor of an expanding population of hyperchromatic germinal cells. As is typical for chemical or mechanical gastric ulceration, there is very little recruitment of leukocytes.
Within the pyloric antrum, the glandular volume is substantially less, occupying less than 50% of the mucosal thickness. The glands are less branched than those of the fundic mucosa and are populated primarily by mucus-producing cells. They are separated from one another by more fibrous lamina propria than in the fundic mucosa, and leukocytes are about twice as numerous as in fundic stomach. Failure to recognize the differences in normal histologic structure between fundic and pyloric mucosa can result in incorrect diagnoses of inflammation, fibrosis, and/or glandular atrophy in samples of pyloric stomach.
Histologic Classification of Gastric Disease
The most useful classification of gastric disease is based on histologic character, as there is rarely sufficient insight into etiology or pathogenesis to propose any other basis. Gastric lesions are classified as:
-
•
Gastric ulceration
-
•
Mucosal atrophy and fibrosis
-
•
Mucosal inflammation and its consequences
-
•
Proliferative disease including neoplasia
These lesions are not mutually exclusive, but most examples of gastric ulceration have surprisingly little inflammation, and most examples of gastritis do not have ulceration. It is worth emphasizing that gastric lesions are common in dogs and cats even when there are no clinical signs. This is particularly true of mucosal fibrosis and atrophy.
Gastric Ulceration
The stomach is surprisingly susceptible to transient shallow ulceration caused by ingested materials ranging from abrasive foods to household chemicals, numerous common garden and woodland plants, an endless variety of clothing items or household decorations, and hairballs. Although one would assume that the abundant mucus lining the stomach would protect it from abrasion, such is not the case. The mucus is probably more important for protection against endogenous acid.
Ulceration caused by mechanical abrasion is usually shallow and transient. Like other portions of the alimentary system, shallow ulcers heal within hours by flattening and sliding of adjacent epithelium followed by replacement of mucus cells generated by a transient increase in mitotic activity within the isthmus zone at the base of the foveolae. The regenerating epithelium is flatter and more basophilic, with little mucus and slight irregularity in orientation of the nucleus (Fig. 29-3 ). Shallow ulcers heal completely within just a few hours. The adjacent superficial lamina propria will usually have at least some edema and perhaps even hemorrhage, but the leukocytic reaction is usually minimal. A few neutrophils may be found in the very superficial lamina propria or intermingled with some fibrin and mucus filling in the ulcer. The paucity of leukocytes is in part because the injured tissue is sloughed into the intestinal lumen so that there is little chemical stimulus for leukocyte recruitment, and partly because the stomach has almost no resident bacteria to contaminate the wounds. With deeper or more persistent ulceration, there will be more obvious hyperplasia and basophilia within the isthmus region reflecting a greater need for mitotic replacement of injured epithelium. Deeper ulcers that have destroyed the isthmus and portions of the lamina propria will take longer to heal and will require stromal proliferation to build a scaffold for effective epithelial healing, but remodeling is extremely effective and it is rare to see any permanent residual scarring. Regardless of the severity of the original lesion, the usual outcome is histologic normalization (Fig. 29-4 ).
Figure 29-3.

Uremic gastropathy, dog. Note the typical horizontal band of acute epithelial necrosis affecting mostly the parietal cells in the middle third of the mucosa. In severe cases there is mineralization of degenerate smooth muscle in the muscularis mucosa and submucosal blood vessels.
Figure 29-4.

Normal feline stomach with a substantial amount of fibrous tissue between the base of the glands and the muscularis mucosa, including the very distinctive lamina densa (arrow).
Causes of ulceration other than mechanical abrasion are numerous and include histamine-induced ulceration in dogs with mast cell tumor,3, 4 accidental chemical ingestion, ulcers caused by steroidal and nonsteroidal antiinflammatory (and occasionally other) drugs,5, 6, 7 and exercise-induced ulcers that are best documented in racing sled dogs.8 In general, the histologic character of the ulceration provides no clue as to the pathogenesis. Careful estimation of the age of the lesions (distance of epithelial sliding, restoration of the normal columnar epithelial shape and normal cytoplasmic eosinophilia, and the maturity of subepithelial fibrosis) will often allow the clinician to identify the causative drug or event. Progression to perforation is rare and usually requires continued application of the injurious stimulus (e.g., continued administration of ulcerogenic drugs or persistent histamine production by a mast cell tumor).
Gastric Necrosis Other Than Ulceration
Epithelial necrosis not typically associated with superficial ulceration is seen with uremia and sometimes with mucosal ischemia secondary to thromboembolic disease, submucosal vasculitis, or gastric dilation/volvulus.
Uremic gastropathy occurs almost exclusively in dogs and its exact pathogenesis remains unknown. The distinctive lesions include mineralization and necrosis of the parietal cells occupying the middle third of the gastric mucosa, mineralization of basement membranes of the glands and of the submucosal blood vessels, and mineralization of degenerate smooth muscle within the muscularis mucosa or even tunica muscularis (Fig. 29-5 ). Mineralization of submucosal blood vessels may become extensive, involving the full thickness of the vessel wall and accompanied by medial necrosis and endothelial destruction.9
Figure 29-5.

Canine fundic stomach with glandular atrophy, glandular nesting, and lamina propria in the absence of any significant infiltration of leukocytes. This is a common lesion, but with no proof that it is medically significant.
With ischemic injury related to vasculitis or vascular occlusion, the character of the lesion depends on the duration and completeness of obstruction. In gastric volvulus, venous obstruction is complete and the intensely congested gastric wall dies following infarction. The mucosa dies first, undergoing coagulation necrosis that quickly becomes lost amid diffuse hemorrhage. In cats with vasculitis caused by feline infectious peritonitis (FIP) or in dogs with disseminated intravascular coagulation (DIC), the necrosis is often patchy.
Gastric Mucosal Fibrosis and Atrophy
Varying degrees of mucosal fibrosis and glandular atrophy are common in biopsy samples of the gastric mucosa. Such lesions have received almost no attention in the veterinary literature, but are common sources of confusion for pathologists attempting to interpret endoscopic biopsies. Some have referred to this as “atrophic gastritis,” with no proof that the pathogenesis of the fibrosis is linked to previous inflammatory disease. In the only study to specifically address this question, noninflammatory atrophy and/or fibrosis was seen in 128 of 482 vomiting dogs. Similar lesions were also seen in five of 19 clinically healthy dogs.10 It is not clear whether the fibrous tissue represents a true increase in the volume of collagen or simply a condensation of resident collagen subsequent to glandular atrophy. The two lesions (mucosal fibrosis and glandular atrophy) are almost always concurrent.
There remain numerous questions related to gastric atrophy and fibrosis, including these:
-
1
What is the normal amount of fibrous tissue within the lamina propria in different portions of the stomach?
-
2
Does it increase with age?
-
3
How commonly is such fibrosis a marker of previous inflammatory disease?
-
4
Is it permanent?
-
5
Is it functionally significant, significant only as a diagnostic marker, or not significant at all?
Normally, the glands within the fundic mucosa lie against each other with almost no intervening fibrous tissue. There is a small amount of loose connective tissue among the foveolae, and there can be substantial fibrous tissue separating the base of the glands from the muscularis mucosa. The amount of fibrous tissue in this deep location is greater in cats than in dogs. In cats there is also a distinct, very dense band of hyalinized fibrous tissue just superficial to the muscularis mucosa, known as the lamina densa (Fig. 29-6 ). Within the pyloric antrum there is substantially more fibrous tissue throughout the lamina propria, so any diagnosis of mucosal fibrosis in the pyloric stomach should be viewed with skepticism.
Figure 29-6.

Superficial mucosal eosinophilic gastritis, dog. This microscopic field corresponds to Southorn's “mucosal unit.” In this instance, it has approximately twice the allowable number of leukocytes, and five times the normal number of eosinophils. Despite the severity of the infiltration, note that the overlying epithelium (as usual) remains virtually normal.
Dogs and cats with chronic gastritis often have persistent mucosal edema that matures into fibrosis. Concurrent inflammatory injury to the gastric glands is followed by regeneration that creates “nests” of hyperplastic glands embedded within the fibrous tissue (see “Atrophic Gastritis” section). It is also common to see the combination of fibrosis and glandular nesting with no evidence of active inflammation and no clinical history of gastric disease (Fig. 29-7 ). The glands within these nests usually have at least some degree of atrophy of the parietal cell mass with a relative increase in the prominence of the columnar mucus-producing epithelial cells. The combination of glandular atrophy, dysplastic repair, and mucus (intestinal) metaplasia represents a strong risk factor for progression to gastric carcinoma in people,11 an association that has not been proven in dogs.
Figure 29-7.

Transmucosal gastritis, dog. There is a threefold increase in mononuclear leukocytes throughout the lamina propria, with some mild glandular nesting accentuated by the inflammatory edema and fibrosis. The lack of architectural effacement distinguishes this, even at low magnification, from lymphoma.
Gastritis
The gold standard for the histologic diagnosis of gastritis is an increase in mucosal leukocytes accompanied by other evidence of inflammation such as hyperemia, edema, and bystander injury to the adjacent structural components of the mucosa (e.g., epithelial injury or reparative fibrosis). That gold standard is met in a proportion of the cases, but not in all. The lack of uniformity in the criteria used to diagnose gastritis impacts on the credibility of virtually all of the published literature on the prevalence, classification, etiology, and treatment of gastric inflammatory disease. To many, gastritis is defined simply as an increase in the number of leukocytes within the lamina propria beyond the normal range. The most obvious problem with this definition is that we do not know the normal range. Less obvious but even more fundamental is the question of whether an increase in leukocytes within a tissue designed to respond to antigenic challenge by increasing the number and activity of resident leukocytes should be interpreted as “inflammation.” An increase in lymphocytes or plasma cells in a lymph node is usually assumed to reflect an appropriate and purposeful response to antigenic stimulation. In the intestinal lamina propria, the largest lymphoid organ in the body, a similar increase in lymphocytes and plasma cells is generally viewed as pathologic and therefore deserving of therapeutic intervention. The distinction between adaptive and pathologic lymphoid proliferation lies not just in the number of leukocytes, but also in the phenotype and cytokine production profile of the cells. These complexities are beyond routine histopathology and immunohistochemistry, but should not be ignored.
Normal Gastric Mucosal Cellularity
Only three studies address the critical question of the reference range for leukocyte types in the normal canine gastric mucosa. The first reports findings from examination of endoscopic biopsies from 20 clinically normal young adult dogs (Table 29-1 ).12 These dogs had no history of vomiting or diarrhea for at least 2 months prior to entering the study, and were all fed a standardized diet and had the same husbandry conditions. Leukocytes were identified with light microscopy and immunohistochemistry, and were counted separately in both superficial and deep lamina propria in “mucosal units” of 250 µm2 (corresponding to approximately one-half of a ×40 microscopic field). Within the superficial lamina propria of the fundic mucosa, this corresponds to a rectangle of tissue incorporating three adjacent foveolae and the associated lamina propria, and extending vertically to the level of the first parietal cell. Within the pyloric antrum, the “mucosal unit” corresponds to an area of lamina propria bordered by two adjacent foveolae, with its deep border capturing the most superficial portion of the gastric glands.
Table 29-1.
Leukocyte Numbers in the Superficial Gastric Mucosa of Healthy Dogs
| Cell Type | Superficial Fundic* | Superficial Pyloric† |
|---|---|---|
| Lymphocytes (CD3 and CD79) | 8.4 (1.5-27.0)‡ | 22.9 (11.5-32.0)§ |
| Plasma cells | 1.6 (0-5.8)‡ | 6.8 (0.5-15.5)§ |
| Eosinophils | 0.5 (0-2.0)‡ | 2.7 (0-6.0)§ |
| Total leukocytes** | 10.4 (3.6-26.2)‡ | 32.6 (20.0-46.5)§ |
Number of cells within a rectangle of lamina propria encompassed horizontally by three foveolae, and vertically to the level of the first parietal cell.
Number of cells in a square of lamina propria encompassed by two adjacent foveolae with the deep border at the foveolar–glandular junction.
Mean (range) of three cell counts in each of 20 dogs.
Mean (range) of two cell counts in each of 8 dogs.
Sum of CD3+ and CD79+ lymphocytes, plasma cells, and eosinophils, but excluding mast cells and unidentified cells.
Source: Adapted with permission from Southorn EP. An improved approach to the histologic assessment of canine chronic gastritis. DVSc Thesis, University of Guelph, Ontario, Canada, 2004.
The other two studies were not specifically designed to provide data about normal gastric mucosal cellularity or other features relevant to the diagnosis of gastritis. Nonetheless, both provide a series of pictorial templates of normal and diseased stomachs in an attempt to reduce interobserver variation in interpretation of gastric histopathology. Neither study provided any information about how the photographic templates identified as “normal” were selected.
The first of these studies was based on 18 client-owned dogs with GI disease and eight dogs euthanized for nonenteric disease. None of the dogs had been treated with antibiotics, corticosteroids, or antacids in the months prior to sampling. Lesions within the fundic mucosa alone were graded by two pathologists using pictorial templates adapted from the human Sydney system that depicts various severities of atrophy, fibrosis, and cellular infiltration. The results from the eight “normal” dogs were not separately identified when tabulating the results (presented as the mean grading results from all 26 dogs).13
The second and much larger study provided not only a series of pictorial templates, but also a brief text to guide the grading of GI biopsies, including those from stomach. It included pictorial templates for leukocyte accumulations, fibrosis, ulceration, and other parameters within the fundic and antral mucosa.14
In both of these latter studies in which the pictorial templates were specifically designed to reduce interobserver variation, the results showed poor correlation among grading scores assigned by different pathologists. Painful though it is, we must collectively confront the reality that it is essentially impossible to compare results from different studies claiming to evaluate causation or therapy of “gastritis.” In most published studies of gastritis in either dogs or cats, the descriptions of leukocyte numbers or the published photographs of lesions claimed to represent mild and even moderate gastritis would be considered “normal” using criteria in the three studies listed previously. This is particularly true of the many studies attempting to establish the pathogenicity of Helicobacter spp. for dogs and cats in which any histologic changes were described as mild increases in superficial mucosal cellularity.15, 16, 17, 18, 19, 20, 21, 22, 23
Histologic Classification of Gastritis
The previously mentioned problems notwithstanding, there is no doubt that genuine gastritis does exist and is quite common. Most cases are part of more generalized GI inflammatory disease,24 but some are purely or predominantly gastric. There is no evidence that histologic classification based on the distribution or type of leukocytes has relevance to pathogenesis, treatment, or prognosis, nor is there evidence to the contrary. Thus it is appropriate to use (at least for the moment) a classification system that reflects histologic changes, with the expectation that at least some of these differences will eventually prove to have etiologic, therapeutic, or prognostic significance.
Superficial Mucosal Gastritis
Most examples of gastritis in dogs and cats involve leukocyte infiltration of the superficial 20% of the mucosa. In almost all cases, the surface epithelium remains normal. In most cases, lymphocytes and plasma cells predominate, but there are almost always at least some eosinophils. Neutrophils are rarely present, but their presence almost always means nearby or recent ulceration. There may be a concurrent increase in intraepithelial lymphocytes, and in cats there can be an increase in intraepithelial large granular lymphocytes (formally known as globular leukocytes) that are of unknown significance. Edema accompanies the leukocytes and there is often activation of resident fibroblasts and blood vessels (Figure 29-8, Figure 29-9 ).
Figure 29-8.

Focal gastric pyloric mucosal hypertrophy, dog. The hypertrophy is limited to the foveolae and surface epithelium. The elongation of the foveolae may be so marked that a routine endoscopic biopsy will capture only the surface and foveolar epithelium and none of the underlying pyloric glands. This justifies a presumptive diagnosis of mucosal hypertrophy in an endoscopic biopsy.
Figure 29-9.

Gastric polyp within the fundic mucosa, cat. In contrast to pyloric mucosal hypertrophy, the proliferation here is by hyperchromatic germinal epithelium with a little mucus production and parietal cell differentiation. Cystic glandular dilation is common. The lack of invasion into the lamina propria distinguishes this from papillary gastric carcinoma (which would be exceedingly rare in a cat).
It has been traditional to describe the predominant cell type (lymphocytic, plasmacytic, eosinophilic) as part of the classification system, but there is no evidence that this is useful.7, 14, 24 First, there is no uniformity between laboratories in how well eosinophils, mast cells, or even plasma cells are stained. Second, pathologists differ in defining what proportion of cells is required before that cell type is considered “predominant.” Some will diagnose a lesion as “eosinophilic” if they believe that the eosinophils are the most numerous cells entering the tissue on an hourly basis, even if they are outnumbered by lymphocytes or plasma cells that have accumulated over weeks and months. Others use a more traditional approach and name the lesion based on the cell type that is most numerous within the tissue at the time of assessment. That means that almost any chronic gastritis will be classified as “lymphoplasmacytic.” Until everyone uses the same convention for naming such lesions, subclassification based on the predominant cell type will remain unreliable. It makes more sense to simply list each identifiable cell type as a percentage of the total infiltrate, so that such information can later be analyzed to see if it influences therapeutic response or other clinical parameters.
Transmucosal Gastritis
Approximately 30% of samples identified as having gastritis by conservative histologic criteria have an increase in leukocytes with variable degrees of edema and/or fibrosis throughout the full thickness of the lamina propria, causing separation of the gastric glands from each other and from the underlying muscularis mucosa (Figure 29-10, Figure 29-11 ). There usually is no obvious necrosis within the glands or along the surface. Lymphocytes and plasma cells predominate, but eosinophils are often conspicuous and sometimes even predominant.
Figure 29-10.

Early gastric carcinoma in the fundic mucosa, dog. In early cases, the diagnosis can be difficult and is based on detecting invasion and replacement of lamina propria by monotypic mucus-producing epithelial cells. Formation of tubules is not common within the intramucosal portion of such tumors.
Figure 29-11.

Gastric carcinoma, dog. There is abundant reactive fibrosis induced by transmural invasion of a mucus-producing tubular carcinoma. The large lakes of mucin within the tunica muscularis are often more obvious than the tumor cells themselves.
Even though it is unusual to see actual necrosis, there often is some glandular atrophy so that the glands appear in isolated nests separated by a mixture of leukocytes, edema, and fibrosis. This is probably the precursor for the lesion usually referred to as atrophic gastritis, an extremely frequent but controversial microscopic entity that usually has no clinical counterpart.
Atrophic Gastritis
Atrophic gastritis is a purely descriptive name for chronic gastritis that combines the elements of chronic inflammation, glandular atrophy, regenerative glandular nesting, and mucosal fibrosis. Lymphofollicular hyperplasia may accompany these changes. There is reduction in overall mucosal thickness and in most cases an obvious reduction in the number of parietal cells with a corresponding absolute or relative increase in the proportion of mucus-producing epithelial cells within the glands. If there are functional consequences to the reduction in glandular mass, they are rarely recognized clinically. Pathologists are not uniform in the criteria used to make this diagnosis, so it is difficult to assess the scattered literature related to pathogenesis and clinical significance. Atrophic gastritis may be just the residual lesion of transmucosal gastritis described previously. Atrophic gastritis has also been used as the name for the parietal cell atrophy and neuroendocrine cell hyperplasia that precedes the development of anaplastic and neuroendocrine gastric carcinomas in Norwegian Lundehund dogs with a distinctive, familial protein-losing enteropathy.25
Etiologic Classification of Gastritis
The majority of cases classified as gastritis by histologic criteria have no identified cause. The list of potential causes includes infectious agents, chemical irritants, toxic plants, and immune-mediated diseases.7 Most of the chemical and plant irritants cause transient gastric ulceration rather than true gastritis, and the inclusion of various allergic or other immune-mediated pathogeneses is based on assumptions rather than proof. Because the stomach is not a site of any significant protein absorption, assumptions of immune-mediated disease may be more appropriate for small intestine than stomach.
Instances of gastritis with a known cause are almost always related to specific infections. These represent a very small proportion of all examples of gastritis, and for most of these agents infection is not usually linked to clinical signs of gastritis or to significant histologic lesions. Parasitic agents include the nematodes Physaloptera, Gnathostoma, and Cylicospirura in dogs and cats, and Ollulanus in cats alone. Infrequent but devastating examples of infection with the fungus Pythium insidiosum cause mucosal and submucosal suppurating granulomas in the stomach and elsewhere in the GI tract of dogs. The stomach is an occasional victim in the course of systemic fungal diseases (e.g., blastomycosis, cryptococcosis). Finally, the crusade to establish Helicobacter as a cause for clinically significant gastritis or gastric ulceration in dogs or cats has triggered more descriptions of alleged gastric lesions than has any other proposed agent of gastric disease.
Parasitic Gastritis
Among the nematode parasites that may infect the stomach and cause histologic lesions, the only ones usually considered of potential significance are Physaloptera and Ollulanus. Gnathostoma and Cylicospirura may cause small submucosal suppurating granulomas, but they do not cause clinical signs. Infection with Physaloptera has been reported to cause persistent vomiting in dogs, and elimination of the worms following treatment resulted in reversal of clinical signs.26 Descriptions of histologic lesions are few and vague.
Ollulanus is sometimes listed as a cause of vomiting in cats. It has been described as a cause for fibrosis, lymphofollicular hyperplasia, and increased intraepithelial large granular lymphocytes in cats, but in the original report there was no clinical disease associated with the infection.27 In some cats the worms can be seen embedded within the foveolae, with no histologic changes. The association between Ollulanus infection and apparent increases in intraepithelial large granular lymphocytes remains unproven. The latter is a frequent observation in the stomach and small intestine of cats with GI disease and is of unknown significance.
Cryptosporidiosis has been reported in the stomach of cats and dogs, but with no proof of pathogenicity.28
Pythiosis
P. insidiosum is an aquatic oomycete fungus found primarily in tropical and warm temperate climates. Most reported cases in dogs have been from the southeast United States, but the disease is seen worldwide. Lesions in the stomach have the same histologic character as those seen elsewhere: destructive coalescing necrotizing granulomas found randomly within submucosa, tunica muscularis, or within the serosa.29, 30 The diagnosis depends on identifying characteristic fungal hyphae. These are often difficult to see without special stains (e.g., periodic acid-Schiff [PAS] or silver stain), but the necrotizing lesions throughout the stomach wall are not easily mistaken for anything else.
Helicobacteriosis
Helicobacter spp. are normal inhabitants of the surface and foveolae of dogs and cats. In dogs, most infections are with Helicobacter bizzozeronii or Helicobacter heilmannii, while in cats H. heilmannii and Helicobacter felis predominate. These large spiral bacteria are easily seen in routine endoscopic biopsies, and their detection is enhanced by the use of silver stains. More elaborate and sensitive detection methods (e.g., polymerase chain reaction [PCR] or tissue urease activity) are research tools rarely if ever used in a diagnostic setting. In the past 15 years, there have been at least nine studies specifically examining the relationship between Helicobacter infection, development of histologic lesions, and clinical disease. None of these studies has proven any causal relationship between infection and disease.13, 15, 16, 17, 18, 19, 20 All but one, however, have claimed that infection is associated with an increase in gastric mucosal leukocytes, fibrosis, and lymphoid follicles. The problem is that the increased leukocytes claimed to represent “gastritis” invariably fall within the normal range for gastric mucosal cellularity as established by Southorn and as subsequently adopted by the World Small Animal Veterinary Association (WSAVA) Gastrointestinal Standardization Group.12, 14 Most of those studies had no uninfected control against which to measure the claims for increased cellularity. Even if one were to accept the hypothesis that colonization by Helicobacter causes a small increase in mucosal leukocytes (including lymphofollicular hyperplasia), the most plausible explanation is that the Helicobacter simply represent an increased antigenic challenge to the resident mucosal leukocytes that respond in an entirely appropriate fashion, analogous to what occurs when gnotobiotic animals are first introduced to a “normal” bacterial flora.31
Gastric Proliferative Disease
Proliferative changes within the stomach include focal adenomatous hyperplasia in the form of gastric polyps, more diffuse but rare canine hypertrophic gastropathy, and genuine neoplasms.
Focal Adenomatous Hyperplasia
Focal adenomatous hyperplasia occurs in two forms. The more prevalent is focal pyloric mucosal hypertrophy in which the foveolae of the pyloric antrum become greatly exaggerated and form villus-like protrusions covered by mature and otherwise normal epithelium.32 The lamina propria sometimes contains an increase in eosinophils, but it is unknown whether those examples with eosinophils have a different pathogenesis than those without. It is unknown whether the eosinophils are involved in the development of the lesion, are the result of the lesion, or are unrelated.
The prevalence of these lesions is directly related to the frequency of endoscopy and many are clinically silent. They become significant only if they grow large enough and if they are located where they may cause pyloric obstruction. The diagnosis is difficult to confirm in endoscopic samples. If orientation and depth are both perfect, then the diagnosis is based on seeing the biopsy filled with superficial and foveolar epithelium with no glands because the increased thickness of the foveolar region occupies the entire capacity of the biopsy forceps (Fig. 29-12 ).
Figure 29-12.

Large cell “lymphoblastic” lymphoma, cat. Typically, these form a solitary discrete mass originating within the lamina propria. This is traditional lymphoma with architectural obliteration by a diffuse sheet of large monotypic lymphocytes (in a cat, virtually always B cells), here leaving only a few lingering remnants of preexistent glands.
Less prevalent than pyloric mucosal hypertrophy is focal adenomatous hyperplasia creating polyps in the gastric body or fundus. These are about three times more prevalent in cats than in dogs. In contrast to the proliferation of mucus-laden superficial epithelium typical of pyloric mucosal hypertrophy, these gastric polyps are formed primarily by papillary proliferation of hyperchromatic glandular epithelium forming branching and sometimes cystic tubules. Most of the epithelium is hyperchromatic and primitive columnar epithelium with no mucus production, but with occasional maturation into parietal and chief cells. They differ from papillary adenocarcinomas by not showing any invasion across the basement membrane and into the lamina propria or submucosa. The lack of invasion is the only reliable criterion distinguishing gastric polyp from a well differentiated papillary adenocarcinoma. There is no proof that these lesions progress to neoplasia.
Gastric Neoplasia
Although a wide variety of neoplasms are reported within the stomach,35, 36 the majority fall into one of three groups: gastric carcinoma, lymphoma, and smooth muscle tumors.
Gastric Carcinoma
Mucus-producing, scirrhous tubular adenocarcinoma is the most common tumor of the canine stomach, but gastric carcinomas are almost nonexistent in cats. In dogs, they usually occur as a regional plaque-like thickening with ulceration in the distal body or within the pyloric antrum. Ulcerated tumors may be confused both macroscopically and microscopically with chronic ulcers that have stimulated abundant reactive fibrosis and dysplastic epithelial repair.
The earliest recognizable histologic lesion is focal obliteration of mucosal glandular architecture by proliferating polygonal epithelial cells that violate the basement membrane of the glands/crypts to proliferate as individualized cells within the lamina propria. These cells, which may not be easily recognized as epithelial cells, may be found only deep within the lamina propria. They may be difficult to capture in endoscopic biopsies especially if the tumor is arising in pyloric mucosa (the thickness of the pyloric mucosa makes it difficult to capture the deep third of the mucosa). There will be times in which full-thickness samples are required to confirm the diagnosis, but that is the exception rather than the rule. The tumor cells invade the submucosa and then the tunica muscularis. In most cases, the initial invasion is in the form of slender cords or tubules of mucin-producing epithelium within or surrounding lymphatics. They penetrate the serosa and exfoliate into the peritoneal cavity to seed the omentum and mesentery. In most cases the tumor cells are well differentiated and form easily recognizable tubules, but some examples comprise only lakes of mucin within the tunica muscularis, or nodules of reactive fibrous tissue on the mesentery or omentum. In such cases, the use of a PAS stain will accentuate the mucus within the cytoplasm of the anaplastic epithelial cells that will be around the mucus or buried within the fibrous tissue.
It is traditional to subclassify gastric carcinomas based on histologic pattern (e.g. papillary, tubular, scirrhous),35 but most examples exhibit substantial regional variation that includes more than one subtype. In addition, there is no proven prognostic or therapeutic significance to these patterns so it is difficult to justify subclassification.
Lymphoma
The identification, classification, and treatment of alimentary lymphoma in dogs and cats is a “work in progress,” with dramatic changes in our understanding arising from more widespread use of immunohistochemistry and clonality testing. Most of what was written prior to 2005 is more or less irrelevant and even misleading, especially with respect to cats. Alimentary lymphoma in cats is very different from that in dogs, although the differences are perhaps less obvious in gastric lymphoma than in examples affecting small intestine.
Feline Gastric Lymphoma
Lymphoma in the stomach of cats occurs in two different forms. The first and more prevalent is solitary large B-cell lymphoma that occurs as a space-occupying mass. The second is diffuse infiltrative small T-cell lymphoma that occurs in the stomach only as part of more generalized alimentary lymphoma that affects primarily the small intestine. There are a few cases that conform to neither of those descriptions, including a few large granular cell lymphomas and “mixed” or “histiocytic” lymphomas with intermingled eosinophils, T cells, and B cells.
Small cell lymphocytic (usually T-cell) lymphoma in the stomach is initially detected as an excessive accumulation of monotypic, hyperchromatic small lymphocytes within the superficial lamina propria and the epithelium. The accumulation is usually diffuse and may result in obliteration of the distinction between the lamina propria and the epithelium. As the disease progresses, tumor cells invade deeply into the lamina propria, obliterating glandular architecture, and spread throughout submucosa and tunica muscularis to completely replace the gastric wall. At that stage, the diagnosis is simple, but it is more challenging when dealing with early disease in endoscopic biopsies. The question is always the same: is this severe lymphocytic gastritis or early lymphoma? With inflammatory bowel disease, the increased cells are usually a mixture of lymphocytes and plasma cells, and there is no obliteration of the distinction between epithelium and lamina propria.
Large-cell (lymphoblastic) lymphoma is a more traditional lymphoma in the sense that it creates an unmistakable “mass” with early obliteration of mucosal architecture and invasion across the gastric wall. Perhaps because this disease is typically focal and limited to the stomach rather than being part of a more diffuse GI disease, the lesion is usually advanced at the time of initial diagnosis; consequently, histologic confirmation via endoscopic or ultrasound-guided core biopsies is not usually problematic. Most examples seem to arise from the diffuse lymphoid population in the superficial third of the gastric mucosa. The tumor spreads rapidly to destroy mucosal, submucosal, and muscular architecture, creating a diffuse sheet of monotypic large lymphocytes with nuclei at least twice the diameter of a red blood cell. Epitheliotropic behavior is rarely observed. In a series of 26 sequential examples studied in preparation for this chapter, all were confirmed as B-cell lymphomas. In a recent published study, nine lymphomas limited to the stomach were all immunoblastic B-cell lymphomas.37
Large granular lymphoma is a rapidly progressive transmural lymphoma with a unique histologic and cytologic appearance. The cells are pleomorphic large lymphocytes with distinctive large red cytoplasmic granules. The nuclei are often cleaved or even convoluted. The malignant cells are often accompanied by other cell types, including small benign lymphocytes, eosinophils, and fibroblasts. Most published examples have arisen in distal small intestine, but there are a few that arise in the stomach. At least in the small intestine, almost all are CD3+CD8+ T-cell tumors that probably arise from intraepithelial lymphocytes. Historically, these tumors were mistaken for mixed transmural granulomatous inflammation or mast cell tumors.
Canine Gastric Lymphoma
Approximately 5% of all canine lymphomas arise within the alimentary tract, and only a small percentage of those arise within the stomach. Gastric lymphoma is substantially less prevalent than gastric carcinoma. It is perhaps for this reason that these tumors have received less attention than feline GI lymphomas. There have been no studies specifically of canine gastric lymphomas, and it is necessary to extrapolate from information derived from GI lymphomas in general. In four different published studies, 54 of 65 canine intestinal lymphomas subjected to immunohistochemical characterization were of the T-cell phenotype and the majority of the others were not classifiable.38, 39, 40, 41 There are case reports of epitheliotropic lymphomas and of eosinophil-rich T-cell tumors, but it is not clear whether these are anything other than just variants of “ordinary” T-cell lymphomas.
Leiomyoma and Leiomyosarcoma
Any published estimates of the prevalence of smooth muscle tumors must be viewed with skepticism. In part this is because smooth muscle tumors are usually small and affect tunica muscularis only, so the majority do not cause clinical signs and cannot be detected endoscopically. Estimates of prevalence therefore differ in studies based on clinical signs as contrasted with postmortem studies.42, 43 Further confusion arises from the fact that many of those tumors initially classified as leiomyosarcomas based on traditional histopathology have been reclassified as gastrointestinal stromal tumors (GISTs) on the basis of immunohistochemistry (positive for CD117, negative for smooth muscle actin).44, 45 Those papers addressed small intestinal, cecal, and colonic tumors rather than specifically looking at those in stomach, and in addition specifically addressed smooth muscle tumors initially diagnosed as poorly differentiated leiomyosarcomas rather than more common, mature leiomyomas. It is therefore a mistake to assume that all tumors previously diagnosed as well-differentiated smooth muscle tumors are at risk of having that diagnosis “overturned” by immunohistochemistry.
Smooth muscle tumors usually occur as focal, solitary, discrete masses arising within the tunica muscularis. They represent a continuum from benign to malignant, with no precise histologic division between leiomyoma and leiomyosarcoma. Those with discrete, purely expansile growth and formed of histologically and cytologically mature smooth muscle cells are called leiomyomas. At the other end of the spectrum are primitive stromal tumors with invasive growth, increased mitosis, and only vague resemblance to smooth muscle cells that have traditionally been classified as leiomyosarcomas. Many examples lie in the middle of that continuum, and pathologists are not uniform in how they classify these. Leiomyomas are formed by cells virtually indistinguishable from normal smooth muscle, except that they grow in interlacing bundles to create a disorganized nodule clearly different from the surrounding, laminar arrangement of the tunica muscularis. These tumors may protrude outward through the serosa or inwardly to cause bulging of the mucosa with subsequent ulceration.
The poorly differentiated tumors are comprised of pleomorphic spindle cells with the usual criteria of malignancy, including regional invasion. Any decision to refer to these as smooth muscle tumors rather than GISTs is subjective and should be confirmed with immunohistochemistry.
There is poor correlation between histologic appearance and biologic behavior. As a group, the smooth muscle tumors have a relatively good postoperative prognosis with prolonged postoperative tumor-free intervals and survival times regardless of histologic appearance.45 For those tumors that behave aggressively, the initial histologic appearance (i.e., leiomyoma vs. leiomyosarcoma) is not predictive.
Intestine
Michael Day
Small Intestinal Biopsies
Assessment of tissue pathology has now become a routine component of the clinical evaluation of small intestinal disease. The traditional means of sampling the small intestine is by laparotomy and the collection of full-thickness surgical biopsies of the duodenum, jejunum, and ileum. This method of sample collection provides a greater chance of meaningful diagnostic outcome and it has been suggested that assessment of full-thickness biopsies increases the likelihood of successful diagnosis of alimentary lymphoma.13, 35 Most clinicians are familiar with the benefits of fixing such samples while the tissue is stretched over a cardboard base to avoid artifactual “curling” of the specimen during fixation. The histology laboratory should then be able to prepare a longitudinal section of tissue with well-orientated mucosa through to serosa (Fig. 29-13 ). Laparoscopy may also permit collection of intestinal biopsies, but the diagnostic value of such samples has not been formally evaluated.
Figure 29-13.

A full-thickness biopsy of the canine jejunum. The sample is well-orientated and includes mucosa, submucosa and muscularis. This biopsy has normal histologic microarchitecture. Hematoxylin and eosin stain; bar = 1 mm.
Increasingly, however, both first opinion and referral practitioners have access to flexible endoscopy and this technique has become the preferred means of acquiring small intestinal mucosal biopsies. Although many clinicians will only sample the duodenal mucosa, wherever possible the ileum should also be sampled as there is evidence that many small intestinal diseases may have focal anatomical distribution. The challenges of successful endoscopic biopsy are numerous and are dealt with elsewhere in this text. From the pathologist's perspective, the number, size, and handling of such samples is directly related to outcome (i.e., a meaningful histopathology report). A minimum of six to eight biopsies of duodenal and ileal mucosa should be collected, and these should be sufficiently deep to include the entire mucosa to the level of muscularis mucosa (Fig. 29-14 ). The diagnostic value of biopsies that comprise only individual villi that are “scythed” from the surface is severely limited (Fig. 29-15 ).
Figure 29-14.

An adequate endoscopic biopsy of the feline duodenum. The sample is well-orientated and includes both villus and cryptal mucosa to the level of the muscularis mucosa. This biopsy displays changes consistent with mild lymphoplasmacytic enteritis. Hematoxylin and eosin stain; bar = 500 µm.
Figure 29-15.

An inadequate endoscopic biopsy of the small intestine. The sample comprises individual villi cut in either cross- or longitudinal-section. The villi are fragmented and no cryptal tissue is present for evaluation. Hematoxylin and eosin; bar = 1 mm.
Consideration should also be given to the handling of such samples postcollection.72 For transport, it is often optimal to place these delicate tissues between prewetted purpose-designed plastic “sponges” that can be sandwiched directly into a histologic cassette. This prevents disruption of the tissue following any vigorous agitation that might occur while the samples are in transit. Most histology laboratories are willing to supply these sponges and cassettes. Although it may appear a basic comment, where samples are submitted from different levels of the small intestine they should be sent in separate, clearly labeled, sample pots containing an adequate volume of formalin for rapid fixation. Samples should be submitted as soon as possible after collection as for some specialized (e.g., immunohistochemical) procedures it is optimal to process tissues into paraffin wax within 24 hours of collection.
The skill of the histology technician should not be underestimated in this regard. The process of embedding these minute tissue samples in molten paraffin wax while maintaining correct orientation and alignment within the block is highly demanding, and better results are obtained if the laboratory is well-practiced in these methods.
The clinician should pay particular attention to the history submitted with the samples. The more information that the pathologist has concerning the clinical presentation and suspected differentials, the more likely an informative and helpful report will ensue. A final consideration is that the microscopic interpretation of intestinal biopsies (particularly endoscopic samples) is not a simple procedure. There is considerable interobserver variation in assessment of intestinal biopsies between different pathologists.71 The WSAVA Gastrointestinal Standardization Group has proposed that intestinal biopsies should be evaluated in a systematic way using a “tick-box” list that encourages the pathologist to examine and record all of the salient aspects of the samples.11 In this way, the clinician can be ensured that all relevant components of the tissue were examined, even if they were histologically normal. Most initial microscopic evaluation will be done with sections stained by hematoxylin and eosin (H&E), but the pathologist should be able to follow this up where required with other histochemical stains (e.g., for identification of some infectious agents, for delineation of collagen in fibrosis).10 It is also now generally possible for the pathologist to request immunohistochemical labeling, particularly in the case of phenotypic identification of round cell or stromal tumors. Clinicians should always develop a close working relationship with their pathology laboratory, and feel comfortable about contacting the pathologist to discuss further any particular case.
This section provides an overview of the major histopathologic diagnoses made from small intestinal biopsies collected from dogs and cats. As such, the information is not an exhaustive list of minor disorders, but focuses on those of greatest clinical relevance.
Small Intestinal Histology
The basic tissue microarchitecture of the canine and feline small intestine is similar. The orderly arrangement of villus-crypt units (Fig. 29-16 ) is broken only by the intermittent presence of organized secondary lymphoid aggregates (Peyer's patches or individual lymphoid follicles) with characteristic modified overlying dome-shaped mucosa (Fig. 29-17 ). Morphometric measurements of canine villus length and crypt depth are reported for different ages of dog,47 but such investigations do not appear to have been carried out with feline small intestine. Similarly, parameters such as the mean number of goblet cells per unit of a defined number of enterocytes and the mean lamina propria total cellularity per unit area have been reported for the dog.21
Figure 29-16.

Small intestinal histology. Full-thickness biopsy of canine jejunum showing regular villus and cryptal microarchitecture. There is mild edema of the superficial cryptal lamina and one or two lacteals are mildly dilated. Hematoxylin and eosin stain; bar = 1 mm.
Figure 29-17.

Small intestinal histology. Full-thickness biopsy of canine ileum showing a Peyer's patch lying within the mucosal–submucosal tissue. Note the modified “dome” shape of the villi overlying the lymphoid tissue and the extension of the perifollicular lymphoid population to the base of the enterocyte layer. Hematoxylin and eosin stain; bar = 1 mm.
The mean numbers of major leukocyte subpopulations within the canine duodenum, jejunum, ileum, and Peyer's patches have been defined by immunohistochemistry or flow cytometric assessment of disaggregated mucosal tissue.21, 24, 27, 57 The most interesting of these data report a trend toward an increasing number of lamina propria eosinophils and a decrease in immunoglobulin (Ig) A plasma cells from duodenum to ileum. Data are also available for vertical assessment of the villus and cryptal lamina propria. Plasma cells (of the IgG, IgM, and IgA classes) are enriched toward the base of the villus and cryptal regions, whereas the majority of T lymphocytes are located within the villus tips.
Similar data are reported for the feline small intestine66 but these highlight some interesting differences between the two species. While cats also have more T cells in the villus (compared with cryptal) lamina propria, there is only enrichment of IgM and IgA plasma cells within cryptal lamina propria—with equal numbers of IgG plasma cells in villus and cryptal lamina. Also in contrast to the dog, cats have increasing numbers of T cells from duodenum to ileum, and an increase (as opposed to a decrease) in IgA plasma cells from anterior to distal small intestine. The two most striking differences between these species lies with epithelial expression of class II molecules of the major histocompatibility complex (MHC) and with the numbers of intraepithelial lymphocytes (IELs) (Fig. 29-18 ). Whereas dogs display constitutive epithelial expression of MHC class II, the normal feline enterocyte layer is devoid of this molecule.20, 66 Additionally, cats have significantly more IELs than dogs, with an increasing number of these cells from duodenum to ileum (there is no anatomical difference in the dog). The majority of feline IELs are CD8+ (with an αα homodimer)52 and express the αE integrin that likely mediates their interaction with the epithelium.73 It has been suggested that some of these changes may reflect the relatively greater number of microbial flora that are proposed to lie within the small intestinal lumen of the cat.32, 45
Figure 29-18.


Intraepithelial lymphocytes. Villus epithelium from dog (A) and cat (B) showing the greater number of intraepithelial lymphocytes present in the cat. Hematoxylin and eosin stain; bar = 100 µm.
Inflammatory Disease of the Small Intestine
Noninfectious Inflammatory Disease
Chapter 4 discusses inflammatory disease of the small intestine of the dog and cat. The three major noninfectious inflammatory diseases of the canine small intestine are idiopathic inflammatory bowel disease (IBD), food responsive diarrhea (FRD; also referred to as dietary hypersensitivity or food allergy), and antibiotic-responsive diarrhea (ARD; small intestinal bacterial overgrowth [SIBO]). The first two of these are also well-recognized in the cat. These disorders likely share elements of pathogenesis relating to the interaction between the intestinal immune system and bacterial or food antigens, and there is probably a pathologic continuum with overlap between the three entities.23 A range of canine breed–associated enteropathies (e.g., those affecting Irish Setters,50 soft-coated Wheaten Terriers,61 Norwegian Lundehunds,14 and Basenjis4) also likely fits within this pathologic spectrum. The clinical and pathologic definition of these specific diseases remains problematic, but all may involve a small intestinal mucosal inflammatory response, generally characterized by lymphoplasmacytic and/or eosinophilic infiltration.29, 30, 32, 67, 74 Alternatively, examples of all three disorders are commonly found where there is no clear evidence for intestinal inflammation.
Given these difficulties, the WSAVA Gastrointestinal Standardization Group produced a monograph on the characterization of the small intestinal (specifically duodenal) inflammatory response per se, without relating these changes to any specific disease entity.11 The monograph describes the major morphologic and leukocyte infiltrative changes that might occur in the small intestinal inflammatory response, and proposes descriptions of mild, moderate, and severe inflammatory change. The morphologic criteria that define small intestinal inflammation include villus stunting and fusion (Fig. 29-19 ), epithelial injury, crypt dilation, distention or abscessation (Fig. 29-20 ), lacteal dilation, and fibrosis. The types of inflammatory infiltrate that may occur are lymphoplasmacytic, eosinophilic, or neutrophilic (Fig. 29-21 ). Mixtures of these three types of response may also occur. Additionally, assessment of the IEL count is an important component of such evaluation, as elevation of IELs may occur in these inflammatory disorders.
Figure 29-19.

Villus stunting. Endoscopic biopsy from a dog with lymphoplasmacytic enteritis. In this well-orientated biopsy, the marked reduction in height of the villi may be clearly appreciated. Hematoxylin and eosin stain; bar = 500 µm.
Figure 29-20.

Crypt abscess. This biopsy of small intestinal mucosa has been cross-sectioned through the level of the crypts. Although not the optimum orientation for assessment, the central crypt is clearly dilated and filled by an accumulation of bright eosinophilic secretion and degenerate granulocyte nuclei. Individual “crypt abscesses” are considered an incidental feature within otherwise normal mucosa. Hematoxylin and eosin stain; bar = 500 µm.
Figure 29-21.

Lymphoplasmacytic enteritis. Small intestinal biopsy from a cat with lymphoplasmacytic enteritis. There is marked villus stunting and an infiltrate of predominantly lymphocytes and plasma cells into the lamina propria. Crypts have minimal change in this sample. Hematoxylin and eosin stain; bar = 500 µm.
The utility of examination of intestinal biopsies for the diagnosis and monitoring of these inflammatory enteropathies is widely debated. In some canine studies, histopathologic score correlates with the clinical score31, 41 (the “canine IBD activity index” [CIBDAI]) although this has not been replicated elsewhere.1 Even where histopathologic grade may correlate with clinical severity, repeat biopsy following successful therapy may not necessarily reveal a reduction in the intensity of histopathologic change.19 Histopathology forms one part of a similar proposed composite feline IBD clinical severity scoring system.
Lymphangiectasia
The WSAVA criteria include villus lacteal dilation, which may arise secondary to a mucosal inflammatory response in which there is occlusion of lymphatic outflow. Extensive lacteal dilation is also a hallmark of the entity termed lymphangiectasia, in which there is “ballooning” dilation of the lacteals accompanied by lamina propria edema and loss of lymphatic fluid (and associated cells and protein) into the intestinal lumen (protein-losing enteropathy) (Fig. 29-22 ). Affected villi are generally blunt. Lymphatic vessels in the submucosa, muscularis, serosa, and mesentery may also be dilated. Lymphangiectasia is recognized in the dog and may be a congenital developmental disorder or be acquired secondary to occlusion of lymphatic outflow by inflammatory or neoplastic processes.37, 58 Increased lamina propria cellularity is described in some cases, and specific elevation in the numbers of IgG plasma cells has been described. Lymphangiectasia may be accompanied by the formation of discrete microgranulomata (lipogranulomas) within the submucosa or deeper regions that generally center upon lymphatic vessels.63 These inflammatory foci contain numerous highly vacuolated macrophages (lipophages) that take up the lipid-rich chyle that leaks from affected vessels. It is more likely that these lesions are a sequel to, rather than an initiating cause of, occluded lymphatic outflow. These key lesions may only be visualized on full-thickness (as opposed to perendoscopic) biopsy. As a distinct histopathologic syndrome, some dogs with protein-losing enteropathy have prominent crypt dilation/abscessation with mild lymphatic dilation, but an absence of villus pathology or mucosal inflammatory infiltration.70
Figure 29-22.

Lymphangiectasia. In this full-thickness biopsy there is marked ballooning dilation of the villus lacteals with reduction in the height of the affected villi. There is also lymphatic dilation within the pericryptal mucosa and the submucosa. Hematoxylin and eosin stain; bar = 1 mm.
Infectious Disease
Inflammatory change within the small intestine may also arise secondary to numerous defined causes, including parasitic, protozoal, bacterial, fungal, or viral infection. One example of such change is that which accompanies parvovirus infection of the cryptal epithelia. The hallmark features of parvoviral enteritis in dogs and cats are extreme villus atrophy, crypt dilation, and distention, with characteristic epithelial necrosis and bizarre squamoid morphology of surviving cells, and minimal lamina propria inflammation (Fig. 29-23 ).5, 64 Later in the course of disease there may be crypt hypertrophy as a consequence of compensatory crypt epithelial hyperplasia/regeneration. Feline leukemia virus has been proposed as a cause of cryptal necrosis similar to that caused by parvovirus. By contrast, feline (and canine) coronavirus enteritis causes loss of enterocytes from the tips of villi rather than affecting the crypts. Antigen from all three feline viruses may be identified within intestinal tissue by immunohistochemistry.34 Crypt epithelial proliferation and mucosal erosion may occur in young pups with Campylobacter enteropathy and these bacteria may be identified within the crypt epithelial cell cytoplasm.12 By contrast, in canine peracute hemorrhagic gastroenteritis (most often affecting young animals of toy and miniature breeds and suggested to have clostridial etiology; Clostridium perfringens type A) there is hemorrhagic necrosis of the mucosa with sparing of the crypts. In both dogs and cats, clinical disease and intestinal pathology associated with “attaching and effacing” Escherichia coli (AEEC) is recognized but in many cases other concurrent intestinal pathogens are identified.65
Figure 29-23.

Parvovirus infection. Intestine taken at necropsy examination from a pup with polymerase chain reaction (PCR)-confirmed canine parvovirus infection. There is loss of villus structure and almost complete cryptal destruction. Hematoxylin and eosin stain; bar = 1 mm.
A further specific example of a relatively common small intestinal inflammatory lesion is that which accompanies FIP virus infection. In this instance, the pathology is generally serosal (rather than mucosal) and characterized by the presence of vasculocentric pyogranulomatous reactions thought to be initiated by the deposition of antigen–antibody immune complexes (Fig. 29-24 ). Granulomatous enteritis secondary to mycobacterial infection may also occur in cats and dogs following ingestion of unpasteurized bovine milk or infected small rodent prey (Fig. 29-25 ). In certain geographical areas (e.g., the southern United States), granulomatous enteritis caused by the fungus Histoplasma capsulatum is prevalent in dogs.7 Canine histoplasmosis most commonly affects the ileum and colon and organisms are prominent within the cytoplasm of infiltrating macrophages (Fig. 29-26 ). Hemorrhagic granulomatous enteritis may also occur in canine “salmon poisoning” in which dogs ingest salmon infected by the fluke Nanophyetus salminicola, which transmits the causative rickettsial organism Neorickettsia helminthoeca. Granulomas with prominent eosinophil infiltration may surround fragments of migrating Toxocara canis in the intestine of young dogs with poor husbandry. This change is generally considered an incidental finding, but has been termed canine multifocal eosinophilic gastroenteritis. The attachment of hookworms to the small intestinal mucosa may also induce local tissue damage related to the ingestion of blood by the parasite. Tapeworms also attach to the intestinal mucosa, but they generally have minimal clinical significance for the host. Although primarily a colonic infection, Tritrichomonas foetus may also infect and induce inflammation in the ileum of cats. Small intestinal giardiasis is not uncommon in young dogs and cats, but the Giardia organisms produce little intestinal pathology other than damage to the enterocyte microvillus border.
Figure 29-24.

Feline infectious peritonitis. Intestine taken at necropsy examination from a cat with feline infectious peritonitis virus infection. There are discrete pyogranulomatous foci over the serosal surface extending into the muscularis. The mucosal and submucosal structure is unaffected. Hematoxylin and eosin stain; bar = 1 mm.
Figure 29-25.

Intestinal mycobacteriosis. Section of intestine from a dog showing diffuse infiltration and aggregation of macrophages with expansive pale cytoplasm. Ziehl Neelsen staining of a serial section revealed that these cells contained large numbers of acid-fast organisms. In this dog, the primary lesion was intestinal (with secondary systemic dissemination) and thought to have occurred secondary to ingestion of an infected wild rodent. Hematoxylin and eosin stain; bar = 100 µm.
Figure 29-26.

Histoplasmosis. Section of colon from a dog showing diffuse infiltration and aggregation of macrophages containing numerous cytoplasmic organisms with morphology consistent with Histoplasma. Although primarily a large intestinal disease, this infection may also involve the ileum. Hematoxylin and eosin stain; bar = 100 µm.
Neoplastic Disease of the Small Intestine
Alimentary Lymphoma
Neoplastic disease of the small intestine remains the major differential for inflammatory disease of this organ and is not an uncommon diagnosis in dogs and cats. These tumors may be of epithelial, mesenchymal, or hemopoietic origin. A frequent small intestinal neoplasm is alimentary lymphoma, which may concurrently involve other regions of the GI tract or mesenteric lymph nodes. Alimentary lymphoma is the most common tumor of the small intestine in cats. With the advent of successful vaccination and testing programs for feline leukemia virus (FeLV) infection there has been a change in the epidemiology of feline lymphoma. This disease now occurs principally in an older cohort of cats, is more likely to be unassociated with FeLV infection, and most frequently has alimentary distribution.62 In one study from Australia (where FeLV infection is uncommon), 15 of 118 cats with lymphoma had only intestinal involvement, a further 20 cats had alimentary lymphoma with involvement of other abdominal viscera, and another 25 cats had alimentary lymphoma with concurrent involvement of nonabdominal viscera.18 In a retrospective study from California, 186 of 257 cases of feline lymphoma were recorded as having primary intestinal disease. Moreover, the incidence of intestinal lymphoma had increased in the latter 10 years of this 1983 to 2003 survey.38 Feline alimentary lymphoma may give rise to a discrete nodular mass(es) within the intestine and/or may involve diffuse infiltration of the intestinal wall without producing mass lesions. The tumor may arise at any level of the gastrointestinal tract.
Feline alimentary lymphoma is generally considered to arise within the mucosa and to infiltrate into submucosa and muscularis (Fig. 29-27 ). Three distinct morphologic/phenotypic variants are described: small-cell lymphocytic villus lymphoma, large-cell or lymphoblastic lymphoma, and large granular lymphoma. Small-cell lymphocytic villus lymphoma affects older cats and begins as an accumulation of small T lymphocytes at the base of the villus. These cells gradually extend throughout the lamina propria and into the epithelium, and eventually the infiltrate becomes transmural.6 Large-cell (lymphoblastic) lymphoma affects cats of any age and is a more aggressive, rapidly progressing, transmural tumor that forms nodular masses and metastasizes to mesenteric lymph nodes. At least a proportion of these tumors are of the B-cell phenotype. Large granular lymphoma is an aggressive metastatic form of disease involving large epitheliotropic lymphocytes with distinctive eosinophilic cytoplasmic granules that contain the molecule perforin immunohistochemically.9, 33 This finding suggested that these cells may be either cytotoxic T lymphocytes or natural killer (NK) cells, but further phenotypic investigation revealed that they are CD3+ and also express a CD8αα homodimer, and are therefore likely to be intraepithelial T lymphocytes.51 These large granular lymphocytes are also considered to be the same population as “feline globular leukocytes.” Recent immunophenotypic studies have characterized the majority of feline alimentary lymphomas as being T-cell in phenotype (some of which may be epitheliotropic), but B-cell lymphoma or mixed phenotype tumors also occur.40, 68 By contrast, other studies report a dominance of B-cell lymphoma affecting the feline alimentary tract.17 There is no clear evidence that immunophenotype is associated with survival time for feline alimentary lymphoma.46
Figure 29-27.

Alimentary lymphoma. Full-thickness biopsy from the ileum of a cat with alimentary lymphoma. In this section there is marked villus stunting with widespread infiltration of the lamina propria by a monomorphic population of small lymphocytes. These cells display epitheliotropism and also extend into the submucosa. The appearance is consistent with small-cell lymphocytic lymphoma and these are likely of the T-cell immunophenotype. Hematoxylin and eosin stain; bar = 500 µm.
The greatest challenge in the diagnosis of feline alimentary lymphoma is distinguishing early incipient neoplasia from chronic lymphoplasmacytic inflammatory disease. It is well-recognized that lymphoplasmacytic enteritis may progress to alimentary lymphoma in the cat, as is also documented for human patients with celiac disease.2, 38, 40 The microscopical distinction between lymphoid inflammation and neoplasia is very difficult, but adjunct tests such as immunohistochemistry or molecular “clonality testing” increasingly have been shown to have a role in determining whether an infiltrating population of lymphocytes is clonal (and therefore neoplastic).40, 69
Although canine alimentary lymphoma shares gross and microscopic features with the feline disease, there is no evidence for a specific etiologic agent. Canine alimentary lymphoma most commonly arises within the small intestine. The lesions may be diffuse or nodular and involve a number of segments of the gut. There are fewer data on the immunophenotype or molecular rearrangements of canine alimentary lymphomas (epitheliotropic T-cell lymphomas are more common than B-cell, mixed, or null cell tumors), and although a transition from lymphoplasmacytic enteritis to lymphoma is suggested to occur in the dog, this has not been well characterized.15 In one retrospective study of 44 cases of GI lymphoma (of which 29 involved the small intestine) there were more CD3+ T-cell tumors (n = 33) than either CD20+ B-cell tumors (n = 3) or tumors expressing neither marker (n = 8). The T-cell tumors were invariably epitheliotropic.8 Canine alimentary T-cell lymphoma may be accompanied by a significant infiltration of eosinophils, a state that must be distinguished from intestinal mast cell tumor.42
Other Round-Cell Tumors
Solitary extramedullary plasmacytomas of the small intestine are rarely identified in dogs and cats and are considered to be low-grade malignancies. The malignant plasma cells are pleomorphic and arranged in packets. Immunoglobulin light chain amyloid (AL) may be associated with the tumors. The diagnosis may be confirmed by immunohistochemical evaluation of expression of immunoglobulin heavy and light chains.49 These tumors are not associated with multiple myeloma of bone and affected animals are rarely paraproteinemic.
Uncommon examples of other intestinal round-cell tumors are recorded. Intestinal mast cell tumor is more common in cats than dogs and most frequently arises in the ileum and jejunum, respectively. These tumors may be difficult to identify when there is a prominent accompanying eosinophil infiltration or lack of metachromatic staining of mast cell cytoplasmic granules. Intestinal mast cell tumor carries a poor prognosis, with frequent metastasis and evidence of gastrointestinal ulceration.59 The rare hypereosinophilic syndrome may involve the alimentary tract and is more commonly reported in cats28 than in dogs.48
Intestinal Adenocarcinoma
A second important small intestinal neoplasm is adenocarcinoma which may also arise at other levels of the gastrointestinal tract. Most alimentary adenocarcinomas are of gastric origin in dogs, whereas the majority appear to be intestinal in cats.36, 44 Within the small intestine, these tumors generally appear as solitary annular and stenosing masses and may be extensively infiltrative and metastatic to the serosa, mesentery, and via lymphatics to mesenteric lymph nodes. Transcoelomic or hematogenous metastasis is rare. Microscopically, there is often a marked scirrhous reaction with small nests of pleomorphic tumor cells embedded within this matrix (Fig. 29-28 ). The cells may form acinar structures or small aggregates, or be individual in distribution. The classic appearance of a “signet ring cell” is consistent with the secretory nature of the neoplastic epithelia. Some adenocarcinomas display “lakes” of pale mucinous material that may be identified by the Alcian blue/PAS reaction. Occasional carcinomas have a more solid lobular appearance and lack acinar differentiation or evidence of mucin production. Some tumors have evidence of metaplastic formation of bone or cartilage. Tumor cells of adenocarcinomas would be expected to express cytokeratin but not vimentin on immunohistochemical evaluation. Benign epithelial polyps or adenomas are rare in the canine and feline small intestine.39
Figure 29-28.

Adenocarcinoma. This section of canine colonic adenocarcinoma shows obliteration of normal microarchitecture by irregular infiltrative acinar elements within a scirrhous matrix. These tumors may arise at any level of the gastrointestinal tract. Hematoxylin and eosin stain; bar = 500 µm.
Carcinoid
An intestinal carcinoid is a tumor of neuroendocrine cells of the mucosa that is rarely documented in dogs (mostly colonic) and cats (mostly ileal). These lesions are an important differential for carcinoma and distinguishing between these tumors may require immunohistochemical or electron microscopic evaluation. Grossly, carcinoids may be annular stenosing or nodular in appearance. They display similar infiltrative and metastatic behavior to adenocarcinomas. The histologic pattern is of nests or cords of cells packeted by fine bands of connective tissue stroma. The neoplastic cells have a granular, eosinophilic cytoplasm and label positively for synaptophysin and chromogranin by immunohistochemistry.54
Intestinal Mesenchymal Tumors
Stromal neoplasms also arise in the small intestine, in particular the leiomyoma or leiomyosarcoma of smooth muscle origin. These are generally solitary nodular masses that most often arise in the muscularis of the small intestine of dogs and are considered uncommon in cats. The tumors are comprised of interlacing bundles of strap-like spindle cells with abundant eosinophilic cytoplasm compatible with the tissue of origin. Leiomyosarcomas generally have greater cellular pleomorphism and mitotic activity than leiomyoma. Leiomyosarcomas may be infiltrative but late-stage metastasis to mesenteric lymph nodes and/or liver is uncommon. Other intestinal stroma may rarely give rise to neoplastic lesions such as fibrosarcoma, myxosarcoma, or hemangiosarcoma.55 Hemangiosarcoma may also metastasize to the small intestine from other primary sites. Nerve sheath tumors or tumors of ganglionated plexuses (ganglioneuroma) are also rare within the small intestine. The histogenesis of stroma cell neoplasms may be confirmed by immunohistochemical evaluation. Leiomyosarcomas will express vimentin, desmin, and muscle-specific actin (these molecules are also found in skeletal muscle) and the specific smooth muscle molecule α-smooth muscle actin. Expression of factor VIII–related antigen characterizes hemangiosarcoma.
Occasional tumors with morphology consistent with leiomyosarcoma fail to label with smooth muscle markers immunohistochemically and are classified as GISTs.3, 16 These tumors are thought to arise from the interstitial cells of Cajal or from a precursor cell that gives rise to these cells in addition to smooth muscle cells. GISTs may express immunohistochemically vimentin, S-100, neuron-specific enolase and c-kit. It would appear that many of the tumors previously diagnosed as intestinal leiomyosarcoma in fact may have been GISTs as defined by retrospective immunohistochemical evaluation.53
Miscellaneous Disorders of the Small Intestine
A variety of other disorders, many of which are relatively uncommon, may give rise to pathology within the small intestine of dogs and cats. Small intestinal inflammation might arise secondary to traumatic events or the presence of a penetrating or blocking foreign body. Intussusception of lengths of small intestine may occur and if sufficiently chronic lead to the development of adhesions and severe inflammatory responses. The cause of intussusception is often not identified, but in dogs this lesion may be secondary to inflammatory disease, parasitic infection, linear foreign bodies (e.g., string) or prior handling of the intestine during surgery. Ischemia may arise following mesenteric torsion or volvulus of lengths of the small intestine. Loops of intestine may be involved in external herniation from the abdominal cavity (e.g., diaphragmatic, umbilical, ventral, inguinal, or perineal hernia).
Proximal duodenal ulceration (peptic ulcer) is recognized most commonly in the dog and has complex pathogenesis that may result in concurrent ulceration of the pyloric antrum. There is a progression from mucosal erosion to deep ulceration with vascular thrombosis, and in some cases to perforation through the intestinal wall. Perforation may result in “silent healing” by omental adhesion and serosal granulation or may lead to hemorrhage and loss of luminal content into the peritoneum. Causative factors may include mast cell tumor leading to histamine-induced hypersecretion of gastric acid, pancreatic islet cell tumors or gastrinomas secreting excess gastrin (Zollinger-Ellison syndrome), administration of glucocorticoid or nonsteroidal antiinflammatory drugs, trauma, or major surgical intervention.
Rare examples of degeneration and inflammation of the muscularis (visceral myopathy) are reported, but the pathogenesis of this disorder is poorly understood.26 Dysautonomia is recognized in both the cat (Key-Gaskell syndrome) and dog.25, 56 The etiology of this condition is uncharacterized but the clinical presentation may include constipation and ileal impaction. Characteristic lesions are present within the neurons of autonomic ganglia, including those of the myenteric plexus. These cells may be hypereosinophilic and shrunken with nuclear pyknosis or karyorrhexis. Cytoplasmic vacuolation and lack of Nissl granules is reported, and the surrounding stroma may contain mononuclear inflammatory cells. Finally, amyloid deposition may occur within the intestine of older dogs but is considered to be an incidental finding.60
Colon
Brian Wilcock
If one were to look at the records from any surgical pathology diagnostic laboratory, the picture that emerges with respect to the pathology of the canine and feline colon is very different from the impression one might get by reading standard clinical textbooks. Except for cases in which neoplasia is suspected, 90% of colonic histopathologic assessments are done on endoscopic biopsies. Among those cases in which histologic lesions are identified, at least 95% are interpreted as either lymphoplasmacytic or eosinophilic colitis, without offering any insight into the exact etiology or pathogenesis. Colitis may occur alone or as part of generalized GI inflammatory disease, usually interpreted by default as IBD. Because it is easier and more reliable to assess changes in mucosal morphology and leukocyte numbers in colonic biopsies than in those from the small intestine, assessment of the colonic mucosa is often helpful, even in those cases in which clinical signs suggest primarily small intestinal disease. Indeed, there is not a strong correlation between the assumed site of disease based on clinical signs and where the histologic lesions are most obvious.
Although the literature describes a plethora of bacterial, fungal, and parasitic agents capable of inducing colitis in dogs and cats, proving a causal link between such infections and clinical disease remains elusive. Most of the agents described can be isolated from clinically healthy dogs and cats, and many are part of the normal flora. For most, fulfilling Koch's postulates has proven impossible, especially when it comes to the experimental reproduction of disease.1, 2 Even for those in which a causal role has been proven, the diagnosis is rarely based on histologic assessment of colonic biopsies.
Our dismal record in correlating histologic lesions with a specific infectious agent or immune phenomenon may just be temporary as new molecular techniques to better identify potentially pathogenic colonic bacteria on the basis of genotype, identify and measure toxins, and identify potential agents of disease within the actual tissue biopsies move from the research laboratory into more general diagnostic use. While we all eagerly await this diagnostic revolution, this section reflects the current reality that specific infectious diseases are rarely identified as a cause of colonic lesions in dogs and cats.
Normal Colonic Mucosa
Interpretation of suspected colonic ulcerative or inflammatory disease requires a firm grasp of the normal range of colonic histology, mucosal kinetics, and principles of GI wound healing (Box 29-1 ). The normal canine colonic mucosa is made up primarily of straight cylindrical crypts oriented perpendicular to the underlying muscularis mucosa. The crypts lie against each other, surrounded by a cell-poor lamina propria populated by stromal cells, vessels, and a sparse population of lymphocytes, plasma cells, eosinophils, and mast cells. The base of each crypt is separated from the muscularis mucosa by no more than four cellular layers, in which eosinophils are often prominent. In dogs, crypt length varies from 400 to 600 µm, and in two-dimensional histologic sections consists of two parallel columns each with about 100 simple columnar epithelial cells. The lining of the superficial three quarters of the crypts appears dominated by goblet cells, but in fact the crypts are populated by a mixture of goblet cells, neuroendocrine cells, columnar absorption of epithelium, and germinal basal cells. Goblet cells are claimed to account for only approximately 10% of the total, but the distended mucus goblets often seem to crowd out the other cells and in routine histologic sections create the visual impression of an almost pure goblet cell population (Fig. 29-29 ). The number of recognizable goblet cells in endoscopic biopsy specimens is only half that in specimens obtained at necropsy examination,3 probably because mild irritation from enemas and instruments used in preparation for colonic biopsies results in disgorgement of some of the goblet cells.
Box 29-1. The Fundamental Rules of Colonic Biopsy Interpretation.
-
•
Colonic inflammatory disease is virtually always diffuse and uniform, so numerous biopsies are unnecessary.
-
•
Because even very small decreases in absorptive efficiency can result in profound diarrhea, even very subtle colonic lesions can be clinically significant.
-
•
Because colonic ulceration heals very rapidly and usually without any residual changes, biopsies must be taken during active clinical disease so as to avoid the risk of a misleading false-negative result.
-
•
Leukocytes should not exceed four cell layers between adjacent crypts, and eosinophils should not appear in the superficial half of the mucosa.
-
•
Credible etiologic candidates are rarely seen.
Figure 29-29.

Normal canine colonic mucosa, with numerous goblet cells and a sparse population of leukocytes within the lamina propria separating adjacent crypts. Hematoxylin and eosin stain.
Mitoses are found only in the basal third of the crypts and are generally inconspicuous in routine sections. The mean mitotic index throughout the colon is 1.13 mitoses per 100 cryptal epithelial cells, or about two mitoses per crypt.3 Cells migrate from the base of the crypt to exfoliate from the luminal surface over an interval of about 4 days, representing the overall mucosal turnover time.
The crypts are separated from one another and from the muscularis mucosa by a small amount of cell-poor fibrovascular lamina propria containing no more than four layers of cells.4 Eosinophils are often particularly conspicuous between the base of the crypts and the muscularis mucosa, and staining with toluidine blue will identify moderate numbers of mast cells that are essentially unrecognizable in ordinary H&E stains. Lymphocytes and plasma cells predominate throughout the more superficial lamina propria, although they may be accompanied by substantial numbers of eosinophils within the deep half of that mucosa. Eosinophils are not found in the superficial half of the lamina propria (Fig. 29-30 ). Intraepithelial lymphocytes are present throughout, but are much less obvious than in small intestine (with a mean of 1.5 intraepithelial lymphocytes per 100 enterocytes).3
Figure 29-30.

Normal canine colonic mucosa. No more than four layers of leukocytes (lymphocytes, plasma cells, eosinophils) separate adjacent crypts from one another and from the underlying muscularis mucosa. Hematoxylin and eosin stain.
Lymphoid aggregates are uniformly distributed within the deep lamina propria and superficial submucosa. Crypts may occasionally penetrate through the muscularis mucosa and into one of these submucosal lymphoid follicles, creating what are sometimes referred to as “submucosal glands.” The follicles are particularly large in dogs and cats younger than about 2 years of age, and they can be seen from the external surface when examining the colon during exploratory surgery. They are commonly mistaken for significant lesions (like ulcers, tumor nodules, or parasitic cysts). The key to the distinction is that these lymphoid follicles are all the same size and shape, and never coalesce.
General Pathology of the Colon
The reactions of the colon to injury are the same as in the rest of the GI tract. The common lesions include ulceration, depletion of recognizable goblet cells, shortening or elongation of crypts, and changes within the lamina propria that include edema, fibrosis, and increased leukocytes. Hypertrophy of the muscularis mucosa is a fairly common lesion of unproven significance. Changes within the submucosa are much less prevalent and ordinarily are seen only as part of invasive transmural disease occurring as a sequel to primary mucosal disease (the most notable exception being submucosal vasculitis in colonic FIP infection in which the mucosa often remains normal).
Ulceration
Surface ulceration triggers a rapid (minutes-to-hours) flattening and sliding of adjacent epithelium to quickly seal the defect. Any significant surface ulceration also stimulates increased mitotic activity in the basal half of the crypts with migration of flattened, hyperchromatic, immature epithelial cells upwardly to replenish those lost (Fig. 29-31 ). Temporary increases or decreases in cryptal length reflect the transient imbalance between epithelial loss and cryptal mitotic replacement.
Figure 29-31.

Canine colonic mucosa with recent superficial ulceration healing by epithelial sliding. Following a single injury, such healing occurs within hours and leaves no residual footprints. Hematoxylin and eosin stain.
Goblet Cell Atrophy
Even the mildest surface irritation results in almost instantaneous evacuation of goblet cells, particularly from the basal half of the crypts, resulting in cryptal distention with mucus and a disappearance of visible goblet cells. In truth, the cells are still present and it is only the goblets of stored mucin that have disappeared. The goblet cells continue to rapidly produce and export mucin, but the storage goblets will only reappear once the surface irritation has resolved and mucin production once again exceeds demand. The combination of reparative epithelial flattening and mucus accumulation may cause these crypts to appear cystic (Fig. 29-32 ).
Figure 29-32.

Even mild surface injury results in evacuation of goblet cells and cryptal epithelial flattening as a prelude to regeneration. The combination creates the impression of “dilated” crypts filled with mucus. Hematoxylin and eosin stain.
Propria Edema and Fibrosis
Acute edema within the lamina propria is a common lesion that is probably just an endoscopic biopsy artifact because in most cases it is not accompanied by any other evidence of colonic disease. Significant edema, of course, can occur as an early manifestation of inflammatory disease or, rarely, as a manifestation of impaired venous or lymphatic drainage.
Propria fibrosis causing abnormal separation of the crypts or separation of the crypts from the muscularis mucosa is probably the most common lesion seen in colonic biopsies (Fig. 29-33 ). It is reasonable to assume that it is a footprint of previous inflammatory disease, but that is just an assumption. We do not know if it has any functional significance.
Figure 29-33.

Diffuse fibrosis within the colonic lamina propria, a common lesion assumed to be a footprint of previous mucosal inflammation. It has no proven functional significance. Hematoxylin and eosin stain.
Increased Propria Leukocytes
As in other portions of the GI tract, perceived increases in leukocytes within the lamina propria is the traditional basis for the diagnosis of colitis. It is worthwhile noting that colonic ulceration may occur without any significant increase in leukocytes, and there are many examples of increased leukocytes in which there is no evidence of epithelial injury (Fig. 29-34 ). Developing valid and uniform criteria for assessing the mucosal cellularity and for promoting acceptable interobserver agreement among pathologists remains problematic within the colon as in other parts of the GI tract. Part of the problem lies with incredible variation in histologic staining from laboratory to laboratory, so that recognizing eosinophils, mast cells or sometimes even plasma cells is problematic.5 Additionally, the range in leukocyte numbers among clinically healthy dogs is quite wide (although much less so than in small intestine). In the only study of its type, normal dogs had up to four layers of lymphocytes, plasma cells, and eosinophils separating adjacent crypts from one another.4 There is no published range for eosinophil numbers, but eosinophils should be virtually absent from the superficial half of the mucosa.3
Figure 29-34.

Canine eosinophilic colitis. Although eosinophils are normal in the deep half of the mucosa, they are normally absent from the superficial mucosa. The proportion of eosinophils required to classify colitis as “eosinophilic” has not been defined. Hematoxylin and eosin stain.
Additional information about normal colonic mucosal cellularity comes from two studies directed specifically at lymphocyte subpopulations. In healthy dogs, the mean number of immunoglobulin-containing cells and CD3+ T cells per linear millimeter in routine histologic sections is approximately 300. Slightly less than half are T cells.6, 7 In 11 dogs with clinically diagnosed IBD, the mean increased to 438. The proportional increase among IgG+, IgA+, and CD3+ cells was similar. In this study, only the IgM+ cells failed to increase significantly.6 There remains the fundamental question about whether an increase in leukocytes within any portion of the intestinal lamina propria should be considered “pathologic,” or simply an appropriate physiologic response to antigenic challenge.
Because economic realities preclude immunohistochemical staining and arduous cell counting for the vast majority of diagnostic samples, the identification and characterization of colitis in dogs and cats is based upon simple rules of thumb (like a maximum of four cell layers separating the crypts from one another or the muscularis mucosa)4 or on clear photographic templates illustrating acceptable and excessive cellular ranges.8
There are certainly some biopsies in which leukocytes exceed the limit of four layers separating adjacent crypts, and in which the increase in leukocytes is accompanied by other evidence of mucosal damage like edema, cryptal or surface epithelial injury, or distorted cryptal repair. The appearance of neutrophils anywhere within the lamina propria is abnormal and usually indicates current or recent ulceration. Only rarely is it an indication of invasive bacterial disease. The observation of eosinophils in the superficial third of the mucosa should also be considered an indication of genuine colitis until we have data to the contrary.
Colitis
In reflecting upon the range of lesions seen in endoscopic or full-thickness colonic biopsies from dogs and cats with a history compatible with colitis, it seems reasonable to divide those biopsies into three broad histologic categories: those with no significant histologic lesions, those with convincing lesions of active colitis characterized by increased leukocytes and/or mucosal damage, and then a large group with more controversial “residual” lesions compatible with waxing and waning colitis captured during one of its quiescent intervals. Those residual lesions include one or more of mucosal fibrosis, cryptal atrophy or tortuosity, and increased leukocytes with no evidence of active epithelial injury or vascular changes appropriate to active inflammation. Considering the waxing and waning clinical signs in many examples of canine or feline colitis and the rapidity of colonic repair, we need to pay much more attention to when the biopsies were taken relative to the last “episode” of clinical disease when assessing colonic biopsies. Lesions of mature mucosal fibrosis and mucosal atrophy are not likely to be relevant if the biopsies were taken in the midst of an acute episode of classical colitis; on the other hand, they may be extremely significant as a footprint of previous inflammatory disease if the biopsies were taken, for example, 2 weeks after the last episode (which is often the case just because of scheduling appointments with a specialist).
Classification of Colitis
There is no official convention for the classification of colitis in dogs and cats. As the vast majority of cases have no demonstrated etiologic agent, colitis is usually classified based on the predominant type and location of the cellular infiltrate.4, 8, 9, 10 The shortcomings of such classifications are several. First, most of our biopsies capture only the mucosa and do not allow assessment of submucosa or muscularis propria. Second, because the normal colonic lamina propria is populated almost exclusively by lymphocytes and plasma cells, other infiltrating cell types have little chance of becoming “predominant” even when their increase may actually be greater and more directly related to the cause of the disease. For example, there is no agreement among pathologists about how many eosinophils it takes for colitis to be classified as “eosinophilic.” This is further complicated by the fact that most biopsies are taken fairly late in the course of the disease, at which time the long-lived lymphocytes and plasma cells are almost certain to predominate even if their daily proliferation or recruitment is far less than the recruitment of eosinophils or other leukocyte types. Finally, and perhaps most importantly, there is a huge interobserver variation in how pathologists assess leukocyte numbers and other grading criteria even when using a pictorial guide.5 Unfortunately, there is no obvious solution to any of these significant shortcomings. At the moment, all we can do is acknowledge that it is indeed a dilemma, not only when making the original diagnosis, but also when trying to compare the results of different studies.
Colitis can also be classified by etiology, but that is problematic because most of the agents appearing on such lists have not actually been proven to cause colitis. Almost all of them are part of the normal flora or at least are “common” isolates from clinically healthy dogs or cats. The common assumption that the isolation of such agents, the demonstration of their DNA via PCR testing, or the presence of their toxins somehow “proves” that they are causing disease has no credibility.1, 2
Box 29-2 is a simple histologic classification that reflects the reality of what is seen by veterinary diagnostic laboratories receiving samples from primary care and specialty private veterinary clinics. Those interested in more refined grading schemes should see previously published studies.4, 8 These patterns are not mutually exclusive, in that the predominant leukocyte type may shift as the disease progresses, and a disease that is initially just mucosal may progress to submucosal or transmural colitis. Nonetheless, the classification proposed here is still useful for the vast majority of cases.
Box 29-2. Colitis Classified by Histologic Pattern.
Mucosal colitis
-
•
Lymphoplasmacytic
-
•
Eosinophilic
-
•
Granulomatous
Ulcerative colitis
Submucosal and transmural colitis
Idiopathic Lymphoplasmacytic (and Eosinophilic) Mucosal Colitis
This is garden-variety chronic episodic colitis in dogs and cats, probably accounting for at least 90% of all diagnoses made on routine colonic biopsies. The histologic diagnosis is based on seeing cryptal separation by a combination of edema, fibrosis, and a mixture of leukocytes that creates more than four layers of leucocytes separating adjacent crypts from one another and from the muscularis mucosa (Fig. 29-35 ). Ulceration is not a common feature, but when seen may take the form of shallow active ulceration, or, more commonly, superficial epithelial flattening and basophilia indicating recent ulceration in the midst of healing. Lesions are typically diffuse and uniform so that all colonic biopsies look essentially identical. A diagnosis of eosinophilic colitis can be made if eosinophils appear in the superficial half of the mucosa.
Figure 29-35.

Traditional lymphoplasmacytic mucosal colitis with an increase in mononuclear leukocytes separating adjacent crypts, mucosal edema, and subtle fibrosis. This is by far the most common pattern of colitis in dogs and cats, with no proven etiologic implications. Hematoxylin and eosin stain.
Granulomatous Mucosal Colitis
Mucosal colitis in which the predominant leukocytes are macrophages is more or less limited to histiocytic ulcerative colitis (HUC) of Boxer dogs and to histoplasmosis. HUC is a distinct disease syndrome with characteristic histologic lesions seen in young Boxers and French Bulldogs. It is a chronic, progressive, and eventually transmural disease characterized initially by shallow microscopic erosion and ulceration of the colonic surface and by an accumulation of large epithelioid macrophages containing PAS-positive cytoplasmic vacuoles between the muscularis mucosa and the base of the colonic crypts (Figure 29-36, Figure 29-37 ). Over time, the number of macrophages increases dramatically, with extension into submucosa and spread via lymphatics to occupy large portions of the draining colonic lymph nodes.11, 12 The granulomatous proliferative disease is usually more obvious than the ulceration. In the early disease, the patchy deep mucosal granulomatous infiltrates can be missed if one is looking only at shallow endoscopic biopsies. For many years, this disease was considered idiopathic and invariably fatal. More recently, the observation that most cases responded to antibiotic treatment with enrofloxacin stimulated a resurgence of interest in this disease.13 Subsequently, fluorescence in-situ hybridization (FISH) in colonic biopsies from affected dogs and subsequent genomic analysis identified specific strains of Escherichia coli capable of adhering to, invading, and replicating within colonic epithelium. These strains were not found in colonic biopsies from healthy dogs and clinical response to treatment was accompanied by disappearance of the organisms.14 Why the disease is limited almost exclusively to Boxers and related French Bulldogs remains an intriguing mystery worth solving.
Figure 29-36.

Early histiocytic ulcerative colitis in a young Boxer dog. The early lesion is usually found deep in the mucosa, associated with epithelial basophilia and flattening as evidence for ongoing superficial ulceration. Hematoxylin and eosin stain.
Figure 29-37.

More advanced histiocytic ulcerative colitis in a Boxer. There is extensive replacement of mucosal architecture by proliferating histiocytes, including spread through the muscularis mucosa and into the submucosa. Hematoxylin and eosin stain.
Histoplasmosis frequently causes diffuse granulomatous colitis either alone or as part of systemic disease. The colonic lesions are usually diffuse and large numbers of organisms can be found in macrophages throughout the mucosa. The infected cells are usually most numerous in the deep third of the mucosa, and may extend through submucosa and even muscularis propria. The diagnosis is seldom problematic because the organisms are numerous and their morphology is distinctive.
Ulcerative Colitis
Ulcerative colitis may be seen as part of several specific etiologic diseases like HUC of Boxers, protothecosis, trichuriasis, and salmonellosis. The vast majority, however, have no proven etiology.
Colonic ulceration not associated with any proven infectious agent occurs under two different histologic settings. The more prevalent is where ulceration occurs without any concurrent increase in mucosal leukocytes. This is particularly prevalent in cats. In other cases, ulceration is accompanied by mucosal changes identical to those seen in idiopathic mucosal colitis described above. It is not clear whether those cases with ulceration alone have a different pathogenesis, prognosis, or response to treatment when contrasted to those examples with concurrent inflammation. It seems worthwhile to at least document the existence of these two different histologic patterns as a stimulus for further research.
Trichuriasis can cause patchy or diffuse ulcerative colitis in dogs with particularly heavy burdens in which the infection spreads beyond the usual cecal location. The worms embed themselves in shallow tunnels in the superficial epithelium and in most cases do not penetrate into the lamina propria. Only with particularly heavy infestations is there ulceration with resulting hemorrhage and mixed fibrinous and neutrophilic inflammation. In response to the ongoing shallow ulceration there is sometimes dramatic cryptal hyperplasia and depletion of recognizable cryptal goblet cells. Perhaps as a result of deep ulceration, worms can occasionally be found embedded within the submucosa and within colonic lymphoid follicles.
T. foetus is a cause of significant, diffuse shallow chronic ulcerative colitis in young cats, especially those in crowded communal husbandry settings. The shallow ulceration is accompanied by increased superficial mucosal neutrophils, and a diffuse increase in lymphocytes and plasma cells throughout the lamina propria. There is compensatory cryptal hyperplasia. The characteristic crescent-shaped protozoa (5 × 7 µm) are seen along the surface of the surviving colonic mucosa of all affected cats, but only in about half of the histologic sections from any one cat.10 Their detection is greatly enhanced by FISH.15
Submucosal and Transmural Colitis
Biopsies in which the principal inflammatory lesions are found in the submucosa are infrequent, but important because they carry strong etiologic and prognostic significance. The most common of these is the colonic form of FIP infection, but this is also the usual pattern seen with pythiosis and occasional cases of idiopathic vasculitis and intestinal ganglioneuritis.
The colonic form of FIP is usually seen as acute severe segmental-to-diffuse hemorrhagic colitis with no other clinical evidence of FIP. The classical lesion is a necrotizing submucosal vasculitis resulting in profound submucosal edema and hemorrhage (Figure 29-38, Figure 29-39 ). As is typical for FIP in other tissues, leukocyte recruitment is variable and ranges from primarily neutrophilic to primarily granulomatous, with many cases having a mixture of virtually every leukocyte type. The key to the diagnosis is the vascular necrosis and the presence of a relatively normal overlying mucosa. Coronavirus can be demonstrated within macrophages and other leukocytes within the submucosa and in the adjacent colonic lymph node via immunohistochemistry, confirming the etiologic diagnosis. There are not enough reported cases accompanied by subsequent postmortem assessment to know the prevalence of microscopic lesions in other tissues. In the largest retrospective study, most cats initially diagnosed with FIP on the basis of intestinal lesions eventually died with clinical signs of systemic FIP.16
Figure 29-38.

The colonic form of FIP in a young cat with acute onset of hemorrhagic diarrhea. In the early stages, there is a destructive submucosal vasculitis causing massive submucosal edema with fibrin and hemorrhage. The overlying mucosa often is almost completely normal. The magnitude of the cellular infiltration and the exact composition of that cellular mixture vary from case to case (and perhaps over time). Hematoxylin and eosin stain.
Figure 29-39.

Colonic submucosa in a cat with acute hemorrhagic diarrhea. Severe edema, hemorrhage, and mixed pyogranulomatous submucosal inflammation are all suggestive of FIP, but the most specific lesion is neutrophilic leukocytoclastic submucosal vasculitis. Hematoxylin and eosin stain.
The fungus P. insidiosum causes characteristic necrotizing and granulomatous lesions anywhere in the GI tract of dogs. Lesions tend to be large, multifocal caseous nodules that are easily seen macroscopically. Lesions may be mucosal, submucosal, or transmural, but the submucosal lesions are probably the most prevalent. The fungi are numerous within such lesions, but they are difficult to see with H&E stain.17 They are readily seen with any of the special fungal stains. As this disease has strong geographic predilections and is relatively common within those specific subtropical habitats, the lesions are usually quite familiar to pathologists working in those areas.
Colonic Neoplasia
Tumors affecting the colon and cecum of dogs and cats include virtually all of those documented for the stomach and small intestine. Because the histologic appearance and almost all aspects of the behavior of these tumors are the same regardless of their location within the GI tract, there is no point in repeating all of those details here. There are a few neoplasms, however, that are either substantially more prevalent within the large intestine or that have significant differences in appearance or behavior. Those tumors that occur exclusively or predominantly in the large intestine include rectal papillary adenoma (rectal polyp), rectal plasmacytoma, papillary colonic carcinoma, and cecal GIST in dogs.
Rectal papillary adenoma (rectal polyp, rectal carcinoma in situ) is the most common of the large intestinal tumors of dogs (Table 29-2 ), but is not seen in cats. It is detected as a focal, solitary sessile or pedunculated proliferation of rectal mucosa that protrudes into the rectal lumen to cause episodic hematochezia and dyschezia, but not diarrhea. All are found in the distal 10 cm of the large intestine. A similar lesion seen more proximally is more likely to be a papillary colonic carcinoma, with a vastly different prognosis. Unlike most neoplasms, there is no apparent increase in prevalence with age and any dog older than approximately 2 years of age can be affected. There is no proven link to diet or any other husbandry factors.18, 19
Table 29-2.
Relative Prevalence of Large Intestinal Tumors in Dogs and Cats*
| Colonic Neoplasm | Dog | Cat |
|---|---|---|
| Carcinoma | 80 | 134 |
| Lymphoma† | 46 | 80 |
| Mast cell tumor | 1 | 0 |
| Rectal plasmacytoma | 97 | 0 |
| Leiomyoma‡ | 7 | 1 |
| Leiomyosarcoma§ | 15 | 8 |
| Rectal papillary adenoma | 582 | 0 |
Based upon 183,178 canine and 50,232 feline surgical biopsies from Canadian private veterinary hospitals, interpreted by a single pathologist, 1995-2009 inclusive.
Tumors limited to the large intestine, based on surgical assessment or imaging.
Predominance of endoscopic samples probably underestimates true prevalence.
Not reviewed to distinguish from gastrointestinal stromal tumor.
Source: Histovet Surgical Pathology, Guelph, Ontario, Canada.
Most samples submitted for histologic evaluation are the result of attempts at complete excision per rectum. Particularly large samples, or those arising too far from the anus, may be submitted as full-thickness samples following exploratory surgery. There is remarkably little variation in the qualitative histopathology among such samples. There is abrupt proliferation of hyperchromatic, jumbled but otherwise quite mature columnar rectal epithelium causing a two- to fourfold increase in the thickness of the epithelium. The hyperchromatic and jumbled cells cover villus-like extensions of lamina propria that extend as papillary projections into the rectal lumen (Fig. 29-40 ). A characteristic feature is that the transition from normal rectal mucosa rich in goblet cells to this hyperchromatic and jumbled epithelium devoid of goblet cells often occurs in the superficial half of the rectal mucosa. The deep half of the mucosa often remains histologically normal. There is no invasion into the lamina propria or into the submucosa. There is often some degree of mechanical or even ischemic necrosis along the surface of the lesion secondary to abrasion from feces or previous prolapse.
Figure 29-40.

Canine rectal polyp. Transition from normal mucosa into the intraluminal papillary proliferation of hyperchromatic and slightly jumbled mature colonic epithelium is typical, and predictive of surgical cure. The absence of propria or submucosal invasion by the hyperchromatic epithelial cells is critical to distinguishing this from an early papillary colonic carcinoma. Hematoxylin and eosin stain.
Surgical excision is curative in the vast majority of cases. It is essentially impossible to determine whether the few postoperative recurrences are because of incomplete excision or additional, independent polyps.
The only significant differential diagnosis is well-differentiated and early papillary colonic carcinoma. Between 1% and 2% of the diagnoses of rectal papillary adenoma/rectal polyp must subsequently be amended to papillary carcinoma on the basis of postoperative recurrence and subsequent submucosal invasion. We do not know whether this represents progression of rectal polyp to true carcinoma, or whether it was simply a mistaken initial diagnosis. The diagnosis of true carcinoma is most reliably made by seeing invasion through the muscularis mucosa and into the submucosa, but many samples are not deep enough to allow that distinction. Even shallow samples of carcinoma may, however, allow observation of invasion across the basement membrane and into the lamina propria, a behavior not seen in otherwise identical papillary adenomas. It is also helpful to remember that most colonic carcinomas arise in the more proximal colon. Rectal papillary adenomas, by definition, are limited to the distal 10 cm of the intestine.
Dysplastic repair following rectal mucosal ulceration could be confused with a portion of a rectal papillary adenoma if the sample was limited to a tiny endoscopic biopsy. Dysplastic repair should be primarily a cryptal phenomenon, giving rise to tortuous cryptal proliferation accompanied by fibrosis and increased leukocytes. It should not create a macroscopic, intraluminal mass.
Plasmacytoma is the second most common tumor of the canine large intestine. Although these tumors may occasionally occur anywhere in the mucosa or submucosa throughout the GI tract, the majority occur as a focal, solitary, and discrete nodule of atypical plasma cells within the submucosa of the rectum that can be easily detected by digital palpation.
Microscopically, they are exactly the same as the plasmacytomas more commonly found in nonintestinal locations like the ear canal, gingiva, lip, and digital skin. The tumor is often found only in the submucosa, with seemingly hesitant extension into the deep half of the overlying lamina propria. It is formed by solid packets of pleomorphic round cells with various degrees of plasmacytoid maturation. The plasmacytoid maturation is often most obvious at the periphery of the tumor. As in all plasmacytomas, the presence of scattered very large cells with hyperchromatic convoluted nuclei, or even multinucleation, is a strong diagnostic clue. The cells are typically arranged in solid endocrine-like packets of 10 to 20 cells surrounded by a delicate fibrovascular stroma (Fig. 29-41 ). In 10% to 15% of cases, there are islands of hyalinized homogenous pink material, identified as Aλ-amyloid, among the tumor cells.
Figure 29-41.
Canine rectal plasmacytoma, forming a discretely expansile mass of pleomorphic, atypical plasma cells with frequent nuclear gigantism and convolution. Hematoxylin and eosin stain.
Most tumors have discrete local growth amenable to surgical cure. A small proportion exhibits invasion into more proximal submucosa or outwardly into muscularis propria. Metastasis to regional lymph node is seen only rarely. The prognostic significance of such spread is unknown.
Differential diagnoses are malignant lymphoma and mast cell tumor. Immunohistochemical labeling for immunoglobulin is definitive for plasmacytoma, but is rarely required.
Most papillary colonic carcinomas closely resemble gastric and small intestinal carcinomas in their histologic appearance and behavior. They originate from epithelial cells in the crypts, invade across the muscularis mucosa and into the submucosa, and spread by direct extension and intralymphatic permeation through the muscularis propria. They then implant throughout the peritoneal cavity, and can also spread by lymphatic and venous dissemination to liver, lung, and any other location. They are often quite well-differentiated mucus-producing tubular carcinomas, and traditionally induce substantial scirrhous reaction. In the colon, however, approximately 25% of carcinomas are, at the time of initial diagnosis, extremely well-differentiated intraluminal papillary tumors that are seen rarely if ever in stomach or small intestine. If sampled just by shallow endoscopic biopsies, these can be mistaken for hyperplastic polyps (especially in dogs and especially if they occur in rectal mucosa where they overlap grossly and histologically with harmless rectal polyps). The key to the diagnosis of carcinoma is that these well-differentiated hyperchromatic columnar epithelial cells invade across the basement membrane and into the lamina propria (Fig. 29-42 ). In biopsies that are deep enough, one can usually detect at least some invasion into the submucosa. There is no information about whether these solitary discrete papillary carcinomas have a different prognosis from transmural invasive carcinomas.
Figure 29-42.

Papillary colonic carcinoma in a dog, with characteristic invasion of hyperchromatic and slightly jumbled epithelial cells across the basement membrane and into the lamina propria. Especially when these tumors occur in rectum, the invasion is essential to distinguishing these carcinomas from the much more prevalent entity of rectal polyp. Hematoxylin and eosin stain.
GIST is a specific histologic entity with a predilection for the muscularis propria and submucosa of the canine cecum. GISTs can occur throughout the GI tract, including adjacent mesentery. To date, GIST has not been described in cats. There are only three studies describing the histologic appearance of GIST in dogs, especially the histologic criteria for distinguishing these tumors from smooth muscle tumors.20, 21, 22 These retrospective studies, with a total of 165 canine intestinal tumors previously classified either as leiomyoma or leiomyosarcoma, reclassified 93 of the 165 as GIST based on immunohistochemical labeling. Making the distinction with ordinary histologic stains is clearly not reliable. The distinction is based on a panel of three immunohistochemical reactions: smooth muscle actin (SMA), desmin, and c-kit (CD117). GISTs are uniformly negative for expression of S-100 and desmin, and about half express c-kit. More importantly, virtually all of the smooth muscle tumors express SMA and two-thirds express desmin. None express c-kit.
In two studies, 41 of 101 tumors affected the cecum. All 41 of the spindle-cell tumors affecting the cecum were reclassified as GIST, making anatomic location alone a powerful predictor of the diagnosis.21, 22
These tumors usually begin within the muscularis propria or in the submucosa, appropriate to their suspected origin from interstitial cells of the autonomic ganglia. They exhibit a wide range of histologic appearance with a wide range in mitotic activity and the degree of invasiveness. They are easily identified as pleomorphic spindle-cell tumors, but distinguishing whether they represent leiomyoma, leiomyosarcoma, or GIST requires immunohistochemistry. Traditional cytologic criteria of malignancy (e.g., mitotic index or nuclear pleomorphism) have little impact on biologic behavior. In one study, surgical excision of small intestinal or cecal tumors in 73 dogs resulted in 80% of these dogs being tumor-free at 1 year, and 62% tumor-free at 2 years.21 A second and smaller study reported that 13 dogs with surgically excised GISTs that survived the immediate perioperative period had a mean survival of 37.4 months. Five dogs with excised leiomyosarcomas had a mean survival of 7.8 months. The difference was not statistically significant.22 There are no adequate studies reporting the efficacy of chemotherapy alone or as adjunct treatment.
It will take some time to sort out what parts of the older literature pertaining to alleged smooth muscle tumors can be transferred to the GIST classification (observations like the great majority are behaviorally benign, and the great majority are clinically silent).
Pancreas
Thomas Van Winkle
While the pancreas may be sampled routinely during necropsy examination, surgical biopsies are infrequently taken from this organ. Many of the major diseases of the pancreas, such as exocrine pancreatic insufficiency (EPI), diabetes mellitus (DM), and acute necrotizing pancreatitis (ANP), do not generally require histologic examination to either make or confirm the diagnosis. Pancreatic biopsy is useful in the diagnosis of neoplasms of the pancreas and to determine whether pancreatic enlargement is caused by inflammation or neoplasia. Many of the microscopic lesions seen in the pancreas are incidental findings and are not associated with serious clinical problems.
Pancreatic Atrophy
Atrophy of the pancreatic acinar cells can occur as a primary condition1 or be secondary to chronic inflammation and fibrosis, starvation, or duct obstruction.2, 3
Primary Pancreatic Acinar Atrophy Associated with Exocrine Pancreatic Insufficiency
Severe atrophy with loss of the majority of the pancreatic acini is an inherited condition in some canine breeds (German Shepherd dog, Rough-Coated Collie, and perhaps English Setter) that is caused by immune-mediated destruction of acinar cells and is associated with EPI.1 It may occasionally be seen in other breeds. Before the pathogenesis was understood, this lesion was usually only observed in the later stages. Early lesions associated with subclinical disease are characterized by infiltration of lymphocytes, and fewer plasma cells and macrophages, at the border of normal and disorganized atrophic parenchyma and extending into the normal parenchyma. Lymphocytes may also be present within acinar and ductal epithelium and lymphoid follicles may be present. The lymphocytes are mostly CD3+ T cells with CD8+ cells more common than CD4+ cells. There is multifocal destruction and loss of adjacent pancreatic acinar cells with individual cell necrosis associated with the lymphocytic infiltration. This stage has been called atrophic lymphocytic pancreatitis.
In later stages, dogs develop clinical EPI and have severe atrophy of the exocrine pancreatic tissue. Grossly, often only pancreatic ducts and adipose tissue are seen (Fig. 29-43 ). Histologically, only ducts, a few disorganized or normal acini, scattered lymphocytes, and islets remain, with extensive replacement of the pancreatic parenchyma by adipose tissue, but there is only limited fibrosis. Islets are usually normal histologically.
Figure 29-43.

Severe pancreatic atrophy (canine); only pancreatic ducts, blood vessels, and adipose tissue remain.
Secondary Pancreatic Atrophy
Mild pancreatic acinar atrophy is common in dogs and cats that are anorexic, starved, have specific nutritional deficiencies, or have maldigestion syndromes.2, 3 In these animals there is a generalized decrease in the size of the acinar cells, increased cytoplasmic basophilia, and zymogen granules are decreased. Cytoplasmic vacuoles may be present in acinar cells in some cases and apoptosis may occur in some conditions. Blockage of pancreatic ducts also leads to focal, regional, or diffuse decrease in acinar cell size and zymogen content. Ducts may be blocked by inflammation, fibrosis, or neoplasia. Experimental duct ligation leads to necrosis, duct dilation, acinar atrophy, secondary inflammation, and periductal fibrosis. Subsequently ductular hyperplasia may occur. Chronic pancreatitis may also lead to acinar cell atrophy associated with fibrosis. Rarely, the atrophy is sufficiently severe to lead to EPI.4
Pancreatitis
Pancreatitis is a broad term that includes all of the responses to acute and chronic damage to pancreatic acini and ducts associated with inflammation including edema, hemorrhage, necrosis, inflammatory cell infiltration, vascular dilation, and eventual fibrosis and atrophy. These lesions may be focal, multifocal, regional, or diffuse and vary from mild to severe. In the condition that is usually referred to clinically as acute pancreatitis or acute necrotizing pancreatitis, necrosis is primary and predominates and the lesion is perhaps better termed “acute pancreatic necrosis”.2 Mild to moderate acute and chronic pancreatic inflammation are common and of uncertain clinical significance in the cat5, 6 and dog.7, 8
Acute Pancreatitis
In acute pancreatitis (acute necrotizing pancreatitis or acute pancreatic necrosis), necrosis usually predominates and is accompanied by varying degrees of inflammation in dogs2, 3, 9, 10 and cats.2, 3, 11, 12 Separation of the pancreatic lobes and lobules by edema occurs, and this is associated with early acute injury to the pancreas. Histologically, edema may appear as clear spaces or pale eosinophilic fluid separating cells, lobules, or lobes. Hemorrhage is also associated with acute injury and may be focal, multifocal, or diffuse.
In moderate to severe acute pancreatitis, focal, multifocal, confluent, or diffuse swollen, friable, and yellow-tan to red areas are seen grossly (Fig. 29-44 ). Multiple white plaques of fat necrosis and mineralization (saponification) in the peripancreatic fat (Fig. 29-45 ) are commonly associated with acute necrosis and inflammation of the pancreas. Areas of saponification also may be present throughout the abdominal fat and are occasionally seen in the subcutaneous or thoracic adipose tissue. The abdominal cavity may contain a serous to serosanguineous effusion with fat droplets and there may be fibrinous adhesions between the pancreas and the small intestine, colon, mesentery, or omentum. In very severe cases of acute pancreatitis, the adjacent wall of the duodenum may be necrotic and inflamed.
Figure 29-44.

Acute pancreatitis (canine) with coagulation necrosis and hemorrhage of the pancreatic parenchyma. Cross-section of pancreas and duodenum (below).
Figure 29-45.

Acute pancreatitis (feline) with white plaques of peripancreatic fat necrosis and mineralization (saponification).
Histologically, in early acute pancreatitis, coagulation necrosis of the pancreatic parenchyma (Fig. 29-46 ) is often seen peripherally in the lobules in mild disease, but may involve the entire pancreas when severe (Fig. 29-47 ). Liquefactive necrosis may accompany or follow coagulation necrosis. Necrosis is often accompanied by peripancreatic fat saponification (Figure 29-48, Figure 29-49 ). Infiltrates of neutrophils frequently accompany both pancreatic necrosis and peripancreatic fat necrosis (Figure 29-48, Figure 29-49) and exacerbate injury to the pancreas by the release of enzymes. Septa between lobules are usually expanded by hemorrhage, fibrin, neutrophils, and macrophages. There may be local destruction of small blood vessels associated with hemorrhage, and thrombi are common in small veins and arteries in severe disease (Fig. 29-50 ) leading to further ischemic damage to the pancreas. Thrombi may extend into the portal vein from the pancreas.13
Figure 29-46.

Acute pancreatic coagulation necrosis in a dog (bottom) showing infiltration of neutrophils and hemorrhage.
Figure 29-47.

Acute coagulation necrosis of all but a few pancreatic acini (canine).
Figure 29-48.

Peripancreatic fat necrosis and mineralization (upper left) surrounded by inflammatory cells (feline).
Figure 29-49.

Necrotic and mineralized fat (above) and viable and necrotic neutrophils (below).
Figure 29-50.

Acute pancreatitis with necrosis of arterioles (upper left) and venous thrombus (upper right).
Occasionally, in both dogs and cats, neutrophils may predominate in acute pancreatitis without extensive necrosis. They may be seen in the parenchyma, in the interlobular septa, or in the pancreatic ducts. Suppurative ductal inflammation occurs in young cats,11 but less commonly in dogs.
Abscesses and/or pseudocysts may occur in acute necrotizing or suppurative pancreatitis and may be found in the pancreas or adjacent to it.14 These two conditions may be difficult to distinguish clinically and pathologically. Abscesses are localized collections of pus, which consist of neutrophils and necrotic tissue debris, and they are usually sterile. Pseudocysts are focal nonepithelial lined collections of fluid containing pancreatic enzymes, necrotic debris, and, in some cases, red blood cells and inflammatory cells. With time, both may develop peripheral granulation tissue and eventually an outer rim of mature fibrous connective tissue. Measurement of intralesional pancreatic enzymes may be necessary to distinguish abscesses from pseudocysts.14
Fibrosis and infiltrates of lymphocytes and plasma cells are seen in some dogs and cats with acute necrotizing pancreatitis, presumably because of previous bouts of necrosis and inflammation.
Acute multifocal pancreatic necrosis with minimal inflammation has been reported in association with canine parvovirus, canine distemper virus, and feline herpesvirus infections.3 Pancreatic necrosis and inflammation can also be seen with toxoplasmosis and feline infectious peritonitis, although it is rarely clinically relevant. Pancreatic necrosis and inflammation has been produced experimentally in cats and naturally in dogs with zinc toxicity.3
Chronic Pancreatitis
Chronic pancreatic inflammation may be the result of acute pancreatitis or be a chronic process not preceded by clinical evidence of an acute injury. Some degree of inflammatory cell infiltration of the pancreas with age is common and of undetermined significance.5, 7, 8 The pancreas may be grossly normal or small, firm, irregular, and nodular (Fig. 29-51 ). Peripancreatic fat saponification, pseudocysts, abscesses, and fibrous adhesions to adjacent abdominal structures may be present. Histologically, there are varying degrees of acinar atrophy and fibrosis (Fig. 29-52 ) with scattered or clustered lymphocytes and plasma cells (Figure 29-53, Figure 29-54 ) and occasionally macrophages and neutrophils. Hyperplasia of ducts is relatively common in chronic disease and some ducts may be dysplastic. Lesions may be focal, multifocal, or regional, and mild to moderate lesions are common in dogs and cats without obvious clinical pancreatic disease.
Figure 29-51.

Chronic pancreatitis (feline). The pancreas is small firm and nodular.
Figure 29-52.

Chronic pancreatitis (feline). Atrophic acini are surrounded by variably thick bands of collagen with scattered neutrophils.
Figure 29-53.

Chronic pancreatitis (feline). Atrophic acini with bands of collagen and foci of lymphocytes.
Figure 29-54.

Chronic pancreatitis with acinar atrophy, vacuolated acinar cells, fibrosis, and clusters of lymphocytes and plasma cells (feline).
Incidental Findings and Lesions of Unknown Significance
Ectopic or Accessory Pancreatic Tissue (Pancreatic Choristoma)
Small masses of normal pancreatic acinar tissue are seen rarely in ectopic sites in the abdomen. Common sites are the serosa or muscular wall of the duodenum, mesentery, stomach, spleen, liver, and gallbladder. Islets are not always identified in ectopic pancreatic tissue.
Cysts and Ductal Dilation
Cystic ducts and acini and dilated pancreatic ducts are incidental findings in older dogs and cats. Many of these animals also may have mild to moderate chronic pancreatitis and nodular hyperplasia.
Vacuoles in Acinar Cells
Clear cytoplasmic vacuoles are seen sporadically in acinar cells, particularly in the cat (see Figure 29-54, Figure 29-55 ). Epithelial vacuoles may also be seen in hyperplastic and dysplastic nodules.
Figure 29-55.

Pancreatic nodular hyperplasia (feline). Small, tan nodules of hyperplasia are scattered throughout the pancreas. A focal ductal cyst is also present.
Fat Infiltration
In older animals the pancreatic lobules may be surrounded and infiltrated by normal adipose tissue. This is particularly common in overweight animals. Fat infiltration is also common in severe pancreatic atrophy in dogs.
Hyperplasia and Neoplasia
Nodular Hyperplasia
Small (1- to 10-mm diameter) tan or tan-pink, slightly firm nodules are common in the pancreas of dogs and cats and increase in number and frequency with age (Fig. 29-55). Histologically, even smaller nodules are common. The nodules are usually not encapsulated by fibrous tissue and do not compress the adjacent pancreatic parenchyma (Fig. 29-56 ). They are usually composed of clusters of well-differentiated cells that form acini and contain variable amounts cytoplasmic zymogen granules (Fig. 29-57 ). Nodules of less-well-differentiated cells with larger nuclear to cytoplasmic ratios and scant amphophilic cytoplasm containing clear cytoplasmic vacuoles without zymogen granules have been described in cats.5 Nodules composed of ductular epithelial cells are less common in dogs and cats (Fig. 29-58 ).
Figure 29-56.

Pancreatic nodular hyperplasia (feline). An unencapsulated focal collection of well-differentiated acinar cells.
Figure 29-57.

Pancreatic nodular hyperplasia (feline). The cells in the nodule (right) are more basophilic and contain fewer cytoplasmic zymogen granules.
Figure 29-58.

Pancreatic nodular hyperplasia (feline). Nodule of ductular origin (lower right). Some normal acinar cells contain cytoplasmic vacuoles.
Adenomas
Pancreatic adenomas are rare and are composed of well-differentiated acinar or ductular epithelial cells that are encapsulated and compress the adjacent parenchyma (Fig. 29-59 ). They are grossly similar to nodules of hyperplasia, and the two lesions may be difficult to distinguish histologically.
Figure 29-59.

Pancreatic acinar adenoma composed of well-differentiated acini bordered by a fibrous capsule (bottom).
Carcinomas
Carcinomas of pancreatic acinar or ductular epithelial origin occur in cats and dogs.2, 3 They are usually firm and tan to pink in color, and may contain yellow-tan areas of necrosis, gritty white areas of mineralization, or red areas of hemorrhage. They are sometimes accompanied by inflammation and necrosis of the adjacent pancreas and by necrosis and mineralization of peripancreatic fat, which can mask the neoplasm, grossly. Carcinomas may present as a single nodule or coalescing nodules that may extend into the adjacent mesentery or invade the duodenum or liver (Fig. 29-60 ). The cells form ducts, tubules, or acini or have a solid pattern. The neoplastic cells exhibit a broad range of morphologies, from relatively well-differentiated acinar or ductular cells (Fig. 29-61 ) to poorly differentiated anaplastic polygonal cells with large nuclear-to-cytoplasmic ratios, scant amphophilic to basophilic cytoplasm, and numerous mitotic figures. In anaplastic tumors it may not be possible to determine if the tumor is of exocrine or endocrine (islet) origin by routine light microscopy. Islet cell tumors may be positive for insulin, glucagon, or somatostatin and are usually positive for chromogranin by immunohistochemistry. Carcinomas may spread into the adjacent duodenum, stomach, and liver, and also spread throughout the abdomen (carcinomatosis). Pancreatic carcinomas frequently elicit a desmoplastic response with cells surrounded by fibroblasts and collagen (Fig. 29-62 ). In poorly differentiated tumors that have spread into adjacent organs, it may be difficult to determine whether the carcinoma is of pancreatic, biliary, gastric, or intestinal origin by light microscopy.
Figure 29-60.

Pancreatic carcinoma (lower right) with multiple liver metastases.
Figure 29-61.

Pancreatic ductal carcinoma (feline).
Figure 29-62.

Pancreatic ductal carcinoma with desmoplasia (feline).
Other Primary Neoplasms
Nonepithelial primary tumors of the pancreas are rare and include fibromas, fibrosarcomas, liposarcomas, and nerve sheath tumors.3
Metastatic Neoplasms
Metastatic neoplasms that may involve the pancreas include hemangiosarcoma, lymphoma, malignant melanoma, a variety of carcinomas, and osteosarcomas.3, 18
Hepatobiliary
John M. Cullen
Normal Liver Histology
Abnormal histology of the liver can be best appreciated when the normal histologic appearance is well understood. There are a number of models that describe the structural unit of the liver.1, 2 In this section, the standard lobule is used as the structural unit of the liver. The liver is a three-dimensional structure and can be envisioned as a tightly packed cluster of grapes with each grape representing a lobule. From the two-dimensional microscopic perspective the “typical” lobule is outlined by a hexagon of portal tracts about 1 mm in diameter with a central vein (terminal hepatic venule) at its center, although some lobules form imperfect hexagons (Fig. 29-63 ). Portal tracts usually contain a branch of the portal vein and one or two branches of the hepatic artery, as well as a bile duct. In addition, the portal tract contains abundant connective tissue as well as lymphatics and nerves. However, there is normal variation in the number of bile ducts and hepatic artery branches. Usually, the portal vein profile is larger than the surface area of the bile ducts and the hepatic arteries. There is a distinct border between the portal tract connective tissue and the initial surrounding row of hepatocytes, termed the limiting plate. Between the portal tract and the central vein the hepatocytes are arranged in radial plates that are one or occasionally two cells thick. Normal hepatocytes have abundant cytoplasm that is more than three to four times the surface area of nucleus and the cytoplasm may be vacuolated to various extents. Frequently, there is a mild to moderate coarse, irregular, clear vacuolation caused by the presence of stored glycogen. Hepatocytes may vary in size in response to systemic or localized factors. Blood oxygen is highest in the periportal regions of the lobule where blood from the portal veins enters the sinusoids and lowest in the centrilobular areas. Centrilobular hepatocytes may become smaller than normal when blood oxygen levels become too low (e.g., during anemia or chronic congestion) or hepatocyte oxygen demands increase (e.g., during heat stroke). Centrilobular hepatocytes may become enlarged where there is induction of drug metabolizing enzymes as these enzymes are in the highest concentration in these hepatocytes. In older cats, the centrilobular hepatocytes often contain brown granular lipofuscin pigment. Mitotic activity of hepatocytes is rarely seen in the normal liver.
Figure 29-63.

The normal portal tract contains a portal vein, hepatic artery, and bile duct gathered within a connective tissue sleeve that is bordered by a uniform row of hepatocytes, termed the limiting plate.
Hepatic plates are separated by vascular sinusoids formed by specialized endothelial cells, evident only by their flattened nuclei along the sinusoid, and characterized by fenestrations that are evident only at the ultrastructural level. The relationship between hepatocytes and sinusoids is viewed two-dimensionally under the microscope, but is ideally envisioned in three dimensions. The portal tracts can be viewed as tree trunks and the finest branches of the distributing portal veins and the hepatic arterioles as branches that extend into the hepatic parenchyma where they open into the sinusoids. These small caliber vessels can occasionally been detected histologically. There are no divisions between normal lobules and there is ready flow of blood between them.
The sinusoids also contain Kupffer cells, actively phagocytic cells that sit on the endothelial cells within the flow of sinusoidal blood. The number and size of these cells can vary with systemic and local inflammation or other stimuli, but they are usually evident histologically due to their abundant cytoplasm. Hepatic stellate cells reside between the hepatocytes and the endothelial cells, in the space of Disse. In normal circumstances these cells can be identified histologically, because they contain lipid vacuoles with stored retinoids. They are usually more prominent in cats than in dogs. It is important to “census” the normal structures as the initial step in the slide review process because the absence of a normal structure can be clinically significant. Pathologists are trained to search for abnormalities, but may overlook the absence of a normal structure, and consequently a diagnosis, if a consistent search pattern is not used during the examination.
Gross Assessment of Liver Pathology
Gross examination of the liver may take place during laparotomy or postmortem examination. Table 29-3 summarizes the main gross pathologic changes and possible diagnoses. These disorders are described in detail in the following sections.
Table 29-3.
A Gross Morphologic Approach to Liver Pathology
| Gross Appearance | Possible Diagnoses |
|---|---|
| Uniformly small liver |
|
| Uniformly small, firm liver | Lobular dissecting hepatitis |
| Uniformly small liver with nodules | End-stage fibrosis with nodular regeneration (cirrhosis) |
| Uniformly enlarged liver |
|
| Normal-size liver: altered color |
|
| Normal-size liver: foci |
|
| Single lobe affected |
|
| Nodular liver |
|
Optimal Liver Biopsy Collection
Consultation with the pathologist is often a useful first step in the biopsy procedure; particularly when there is a clinical indication for special handling of the specimen. The optimal size of the biopsy is determined by balancing the need for sufficient tissue to enable diagnosis and the clinician's concern for the patient. Disorders with diffuse and uniform appearance require the least amount of tissue to make a diagnosis. Other disorders, particularly chronic inflammation, can vary from lobe to lobe and even within a lobe and require multiple sections for accurate assessment of the health of the liver. Wedge biopsies provide a more accurate view of most liver disorders than needle biopsies,3 but it is disappointing, at the least, for the pathologist to receive a single wedge of liver after the patient has undergone a laparotomy. Despite the apparent normality of liver at surgery, histologic evaluation is frequently useful. Multiple small wedges from several lobes are preferred over a larger section from a single lobe. Needle biopsies can be sufficient for many approaches, but multiple biopsies from more than one liver lobe are desired. In any event, properly collected and handled tissue is essential for optimal microscopic evaluation. Once collected, the liver tissue should be handled as little as possible to avoid physical distortion or loss of tissue. This is particularly true of needle biopsies. Small or fragmented biopsies can be placed into embedding bags or plastic cassettes with a screen mesh. In most circumstances, the tissue should be placed immediately into 10% neutral buffered formalin. Tissue should not be more than 0.5 to 1 cm at its greatest thickness and the ratio of formalin to tissue should be 10 : 1. If immunohistochemistry (IHC) is to be performed, the tissue should be processed within 48 hours to avoid overfixation.
If electron microscopy is required, sections should be cut with a scalpel into 1-mm pieces and then placed into an appropriate fixative such as Trump's. Electron microscopy can be useful in certain storage disorders, mitochondrial abnormalities or infectious diseases. Frozen sections are required for certain antibodies applied in IHC, particularly those used to identify various tumor cell types, as formalin fixation can destroy relevant antigens. Frozen sections can also be used for microbiology, genetic studies, and some special stains (e.g., lipid stains) more effectively than formalin-fixed samples. Frozen sections are also useful for evaluations of hepatic metals such as iron and copper. Formalin-fixed liver is also suitable for this purpose if the sample is sufficiently large (i.e., bigger than a needle biopsy)4 and, in cases of storage disorders, analysis of stored material may be possible.
Liver biopsies are stained routinely with hematoxylin and eosin (H&E), but evaluation is often enhanced by a battery of special stains. Some pathologists advise that a particular set of stains is done on all samples as part of the routine evaluation, but this step varies with pathologists and financial constraints. Table 29-4 lists histochemical stains and their targets.
Table 29-4.
Selected Special Stains Used in Diagnostic Histopathology of the Liver
| Material Stained | Stain Name(s) | Stain Appearance |
|---|---|---|
| Amyloid | Congo red | Green under polarized light |
| Glycogen | Periodic acid-Schiff (PAS) | Purple (removed with diastase treatment) |
| Lipid | Osmium | Black |
| Oil red O | Red | |
| Connective tissue/collagen | Sirius red | Deep red |
| Masson's trichrome | Blue | |
| Reticulin | Reticulin stain (Gordon and Sweet) | Black |
| Iron | Perl's Prussian blue | Deep blue |
| Copper | Rhodanine | Orange brown |
| Lipofuscin | Schmorl | Blue-green |
| PAS (diastase resistant) | Magenta | |
| Acid-fast | Red |
Circulatory Disorders
Congenital Vascular Anomalies
Normal liver function is dependent on a close interrelationship between hepatocytes and blood from the portal vein. Congenital abnormalities that lead to inadequate portal vein flow into the liver are manifested grossly as microhepatica, because of reduction in the size of hepatocytes and smaller lobules. Loss of sufficient nutrition, growth factors, and oxygen all contribute to the abnormalities of the hepatocytes. In addition to congenital vascular anomalies, starvation and anemia are should be considered when the liver is smaller than normal.
Congenital Portosystemic Shunts
A congenital portosystemic shunt is an abnormal vascular channel that allows a portion of the blood within the portal venous system to bypass the liver and to drain into the systemic circulation. Shunts occur most commonly in the dog, but are also described in cats.5 A congenital shunt can be either intra- or extrahepatic in location, but is almost always limited to a single vessel.5 Extrahepatic congenital shunts can occur between a variety of sites within the portal drainage and the systemic venous system. Extrahepatic shunts occur more often in small breeds of dog. Typically, intrahepatic portosystemic shunts involve failure of closure of the fetal ductus venosus at birth. These shunts, like the ductus venosus, are most often located in the left side of the liver. This anomaly occurs most often in large breed dogs. Regardless of the site of the shunt, affected animals are typically stunted and frequently develop signs of hepatic encephalopathy. The liver is small and microscopically displays hepatocellular and lobular atrophy.5 There is an increase in the profiles of hepatic arterioles within the portal areas, presumed to relate to a compensatory increase in systemic arterial blood flow, in response to the inadequate portal flow. There is also sometimes a proliferation of small caliber bile ducts. Portal vein profiles are smaller than normal or absent (Fig. 29-64 ). Changes in the central and sublobular veins are often overlooked or misinterpreted. Dogs have a spiral smooth muscle surrounding the hepatic veins that can contract to restrict blood flow from the liver. This muscle constricts in response to various pharmacologic agents and presumably in shock. In some instances, dogs with hypoperfusion of the portal vein, regardless of the cause, have constricted smooth muscle, leading to a small-caliber hepatic vein with prominent smooth muscle (Fig. 29-65 ). This change has been misinterpreted as “arterialization” of hepatic veins. Surrounding lymphatics are also often distended. Variable numbers of lipogranulomas, collections of vacuolated and pigmented macrophages, can be found in the parenchyma or within the portal areas. Portal vein pressure is normal in congenital shunts and ascites does not occur. At postmortem examination abnormal vascular anastomoses are often difficult to identify without the benefit of antemortem imaging studies to localize the shunting vessel. The histologic appearance of congenital portosystemic shunts and other vascular anomalies of the liver have considerable overlap as the liver has a stereotypical response to inadequate portal perfusion. Clinical data, such as the presence or absence of shunt vessels and the determination of portal vein pressure, may be needed to achieve a final diagnosis.
Figure 29-64.

Portal tracts lack a normal portal vein profile and contain an increased number of small-caliber arterioles in cases of portosystemic shunts, as well as other conditions that lead to hypoperfusion of the liver via the portal vein. Lymphatics may also be dilated.
Figure 29-65.

The spiral smooth muscle that surrounds sublobular veins can contract in cases of hepatic hypoperfusion, among other causes, increasing the prominence of the muscle, which can resemble an artery.
Disorders Associated with Portal Hypertension
Portal Vein Hypoplasia (Microvascular Dysplasia, Noncirrhotic Portal Hypertension)
Portal vein hypoplasia is a congenital vascular anomaly that occurs in dogs and occasionally in cats that is characterized by abnormally small extrahepatic or intrahepatic portal veins, diminished hepatic perfusion by portal vein blood flow and the potential for portal hypertension.5 There is considerable discussion surrounding the preferred terminology for this condition and there are several synonyms associated with this condition.6 Recently, the term portal vein hypoplasia has been recommended to identify this condition.7 Typically, affected animals have small livers, and the microscopic changes include portal vein hypoperfusion, small or absent portal veins, proliferation of hepatic arterioles, and hepatocyte atrophy. Lipogranulomas, constricted hepatic veins, and distended perivascular lymphatics may also be present. This disorder resembles portosystemic shunting histologically, but affected animals often have portal hypertension and resultant ascites. Portal fibrosis and biliary hyperplasia occur in about half of the cases. Because of the histologic similarities between portal vein hypoplasia and congenital portosystemic shunts, clinical procedures (e.g., imaging to determine the presence of a shunt vessel) are often required to make a final diagnosis.
Intrahepatic Arteriovenous Fistulas
Intrahepatic arteriovenous fistulas arise from a direct communication between the hepatic artery and the portal vein and occur in dogs and cats. The size of the vessels involved affects the degree of injury. Arteriovenous fistulas may be single or multiple and occur anywhere within the liver. Affected portions of the liver contain dilated, tortuous, pulsating vessels.8 Several histologic abnormalities are present in the hepatic artery branches, including partial elastosis, intimal hyperplasia, and smooth muscle hyperplasia with areas of degeneration and scattered disorganized elastin fibers and areas of degeneration (Fig. 29-66 ). Portal vein branch abnormalities include prominent dilation, with abnormal, thickened walls. The liver adjacent to the fistula has the typical appearance of portal hypoperfusion. Arterial shunting of blood may lead to portal hypertension or reversal of the direction of portal blood flow, and subsequent development of acquired portocaval shunts and ascites.
Figure 29-66.

A hallmark of intrahepatic arteriovenous fistulas is the presence of a large distended vein with an altered wall formed in response to the increased and abnormal blood flow.
Portal Vein Obstruction
Obstruction of the portal vein may occur by thrombosis or by compression from local inflammation (e.g., acute pancreatitis or abscess formation) or neoplastic processes that surround the vein. In the affected livers, the portal vein profiles may be reduced in diameter as a consequence of restricted flow, or may contain thrombi or emboli. Depending on the cause of the obstruction, tumor emboli or inflammatory aggregates may also be found in portal vein branches.
Impaired Hepatic Perfusion
Ischemia
Reduced blood flow to the liver leads to hepatocyte atrophy or necrosis. The rate and magnitude of blood flow or oxygen content determines the balance between necrosis and atrophy. Hepatocytes are resilient and only sudden drops in perfusion lead to acute necrosis. Acute necrosis is evident first in the centrilobular areas, as the oxygen-rich blood enters at the periportal region and progressively loses its oxygen as it travels along the sinusoid toward the central vein. Sudden loss of perfusion from shock, ruptured chordae tendineae, or hemolysis can produce generalized centrilobular necrosis (Fig. 29-67 ). This lesion is histologically very similar to acute hepatotoxicity and clinical data are often needed to clarify the pathogenesis. Random foci of ischemic necrosis are more likely attributed to localized disruption of blood flow, which can follow fibrin deposition within sinusoids during DIC.
Figure 29-67.

Acute centrilobular necrosis can occur in cases of sudden significant loss of oxygen delivery to the liver from acute anemia, blood loss, or cardiac decompensation.
Infarction of the liver is uncommon because of its dual blood supply from the hepatic artery and the portal vein. Infarcts most often occur at the distal edges of the lobes where the perfusion fields dwindle. Affected areas are sharply delineated and dark red or pale. Histologically, coagulative necrosis of hepatocytes is evident.
Disturbances of Outflow
The most common cause of impaired outflow of blood from the liver is posthepatic and occurs in chronic passive congestion of the liver caused by cardiac disease. Histologically there is distention of hepatic veins, atrophy of centrilobular hepatocytes, and an abundance of hemosiderin within Kupffer cells. With chronicity, fibrosis emanating from the central veins can become prominent. Intrahepatic causes of outflow disorders are uncommon in cats and dogs.
Incidental Vascular Disorders
Peliosis Hepatis
Peliosis hepatis is defined as a random distribution of blood-filled cystic spaces in the hepatic parenchyma (Fig. 29-68 ). Grossly, these areas appear as variably sized dark blue-black foci within the liver that vary from pinpoint to several centimeters in size. Peliosis hepatis occurs in older cats and occasionally in dogs. Peliosis hepatis can be mistaken for a vascular tumor (e.g., hemangioma, hemangiosarcoma).
Figure 29-68.

Peliosis hepatis is identified as a distended vascular space, usually a few millimeters in diameter, which may be lined by endothelium.
Biliary Disorders
Congenital Biliary Cystic Disease
Solitary Biliary Cysts
Solitary biliary cysts are uncommon in dogs and cats. They are thin walled and contain pale fluid. Histologically, the cysts are lined with a flattened single layer of biliary epithelium. It is not known if they are an acquired or a congenital disorder.
Congenital Cysts
Congenital biliary cystic diseases are a complex and potentially confusing collection of conditions of dogs and cats. In general they can all be attributed to abnormal development of the primordial biliary ductular system. The biliary tree arises from the ductal plate, an embryonic structure consisting of a two-cell-thick sheath of hepatoblasts that surround the primitive portal tract. Some cells in the ductal plate mature into the bile duct system, whereas others undergo apoptosis. Disturbances in development of this cell population give rise to a variety of biliary developmental abnormalities. Congenital biliary cystic disease is characterized by dilation of portions of the biliary tree and associated fibrosis. Similar lesions are frequently found in the renal tubules as well. Although the pattern of lesions and inheritance in domestic animals is not as clearly separated as it is in man, the WSAVA Liver Study Group7 has proposed the following classification for congenital lesions of the biliary tree:
-
1
Congenital dilation of the large and segmental bile ducts (similar to Caroli disease)
-
2
Juvenile polycystic disease/congenital hepatic fibrosis
-
3
Adult polycystic disease (including von Meyenburg complexes)
Caroli Disease
Caroli disease is thought to be caused by an early defect in the formation of the bile duct system, affecting the larger-caliber bile ducts. In man, the disorder is characterized by saccular dilations of the larger intralobular, lobar, or common bile ducts, and cystic renal lesions may occur concurrently. Affected dogs have similar lesions, although the common bile duct was not abnormal.9 Involved bile ducts often contain inspissated mucus, bile, and mineralized concretions. Histologically, the cystic bile ducts are lined by columnar epithelium and the portal tracts are fibrotic with bridging between portal tracts and proliferation of bile ducts within the areas of fibrosis. Acquired shunts may develop in affected dogs because of the extensive hepatic fibrosis.
Juvenile Polycystic Disease/Congenital Hepatic Fibrosis
Juvenile polycystic disease/congenital hepatic fibrosis can occur in dogs and cats.10 This disorder is characterized primarily by microscopic abnormalities of the bile ducts. Typically there is formation of prominent portal-to-portal bridging fibrotic tracts within which there are abnormal, often irregular, mildly dilated biliary ducts (Fig. 29-69 ). The abnormal ducts are typically tortuous and may have small papillary projections into their lumina. Portal vein profiles may be reduced in area or absent, and arteriolar proliferation may be present. Portal vein hypertension can occur. Typically, this condition is recognized early in life, particularly when portal hypertension arises, but in other cases congenital hepatic fibrosis is only an incidental finding at postmortem.
Figure 29-69.

Congenital hepatic fibrosis in dogs or cats is characterized by portal-to-portal bridging fibrous bands of connective tissue that contain abundant, often abnormal, biliary ducts.
Adult Polycystic Disease
In adult polycystic disease, the liver contains multiple unilocular or multilocular biliary cysts containing clear fluid that range from a few millimeters to several centimeters in diameter (Fig. 29-70 ). Hepatocytes are usually compressed at the margins of the cysts, or may, on occasion, be entrapped by expanding cysts. The stroma of the cyst wall consists of fibrovascular tissue with moderate amounts of collagen. Cysts are lined by normal biliary epithelium that may be simple cuboidal to flattened (Fig. 29-71 ). Another feature of affected livers is the presence of von Meyenburg complexes: discrete, usually subcapsular, fibrotic areas with small caliber bile ducts that typically have an irregular outline. They are usually smaller than a lobule. It is believed that some forms of this disorder have epithelial cells with a secretory phenotype and the production of fluid over time leads to the large cysts, while other forms do not secrete fluid and remain as the smaller von Meyenburg cysts. This would explain why cysts are not found in neonates despite the congenital nature of the disorders.
Figure 29-70.

Polycystic biliary disease produces multiple cysts throughout the parenchyma of the liver. They are usually filled with clear to straw-colored fluid.
Figure 29-71.

Congenital biliary cysts are lined by a single layer of cuboidal to flattened biliary epithelium.
The well-known biliary and renal cystic disorder of Persian cats does not have a phenotype that allows consistent classification. Affected cats with renal cysts may develop biliary lesions typical of either juvenile polycystic disease or adult polycystic disease or a combination of the two. Other breeds of cats can develop congenital hepatic fibrosis and cysts; this may also occur in dogs.
Debate continues regarding the nature of multicystic biliary lesions in the canine liver. It is likely that the majority of these lesions are congenital ductal plate disorders, rather than neoplasms. Multicystic lesions in the kidney are recognized as congenital disorders and the multicystic biliary lesions found in dogs with simultaneous renal cystic disorders are similar to lesions previously diagnosed as biliary adenomas.
Cholestasis
Impaired bile flow accompanied by the accumulation in the blood of components normally secreted in the bile (e.g., bile acids, conjugated bilirubin, cholesterol) is termed cholestasis. 11 Cholestasis is characterized microscopically by the presence of bile in the hepatic parenchyma recognized as bile plugs in the canaliculi, phagocytosed bile in Kupffer cells or other macrophages, and, on occasion, as bile granules in the cytoplasm of hepatocytes. Cholestasis is easily recognized in cytologic preparations and frozen sections, but detectable bile is often reduced in the paraffin wax embedding procedure. Bile detection can be enhanced by using special stains (e.g., Hall's stain). In dogs, bile is rarely apparent histologically in hepatocellular cytoplasm.
Intrahepatic Cholestasis
Intrahepatic cholestasis is associated with a wide spectrum of liver diseases. In general, microscopic lesions apart from the cholestasis are related to the primary hepatic disease, but cholestasis may be the only histologic abnormality.12 In acute cases, bile plugs in canaliculi and Kupffer cells may be evident, but this change is not specific for intrahepatic cholestasis (Fig. 29-72 ). Over time, bile plugs are less evident in canaliculi, but bile may be present somewhat longer in Kupffer cells.
Figure 29-72.

Acute intrahepatic cholestasis is characterized by the presence of bile plugs in the canaliculi that lie between adjacent hepatocytes.
Extrahepatic Cholestasis
Extrahepatic cholestasis can be associated with extraluminal compression of cystic or common bile ducts by tumors or local inflammatory processes. Intraluminal obstruction can arise from a variety of agents including choleliths, intraluminal neoplasia, parasites, or mucus plugs from gallbladder mucoceles. Regardless of the mechanism, the result is stasis of bile and dilation of the bile ducts proximal to the obstruction.
The characteristic microscopic lesions of acute extrahepatic cholestasis in the dog are portal tract edema and infiltration of neutrophils around the interlobular bile ducts (Fig. 29-73 ). Biliary epithelium may be degenerate or necrotic, but more often the epithelium has a reactive morphology with variable cell swelling and mild basophilia creating a somewhat disorganized appearance. In acute cases, centrilobular bile plugs are present and in severe cases, canalicular plugs can extend to the periportal region of the lobule. As cholestasis becomes more chronic, portal tracts expand as a result of fibrosis, bile duct proliferation, periductal concentric fibrosis, and an increase in pigment-laden (lipofuscin and bile) macrophages, lymphocytes, plasma cells, and neutrophils. With increasing chronicity, the bile plugs become less evident and portal-to-portal bridging fibrosis with biliary hyperplasia and eventual biliary fibrosis may develop in cases of persistent obstruction.12
Figure 29-73.

Acute extrahepatic cholestasis is characterized by portal tract edema, a light infiltrate of inflammatory cells, usually including neutrophils and degeneration or necrosis of biliary epithelium.
Inflammation
Cholangitis
Cholangitis may be classified as neutrophilic, lymphocytic, destructive, or chronic (associated with liver fluke infestation).
Acute Neutrophilic Cholangitis
Neutrophilic cholangitis (suppurative/cholangiohepatitis) is the most common type of cholangitis in dogs and cats, and more common in cats overall. The most likely pathogenesis of this lesion involves bacterial translocation from the intestine. Histologically, there is neutrophilic infiltration of the lumen or epithelium of the bile ducts (Fig. 29-74 ). In acute cases there is more edema around the bile duct and it extends into the portal tract. Neutrophils may also be found within the portal connective tissue, and neutrophilic inflammation may extend through the limiting plate leading to hepatocyte necrosis and, on occasion, to hepatic abscesses, at which point the diagnosis of cholangiohepatitis is appropriate.
Figure 29-74.

Neutrophilic cholangitis is characterized by the presence of degenerate or necrotic neutrophils within the lumen or within the wall of affected bile ducts.
Chronic Neutrophilic Cholangitis
Chronic neutrophilic cholangitis can be difficult to discern microscopically. The chronic stage is associated with a variable number of mixed inflammatory cells, neutrophils, lymphocytes, and plasma cells in the portal tracts (Fig. 29-75 ). Fibrosis and bile duct proliferation may be evident. Neutrophils persist, even in low numbers, in the lumina of the bile ducts.
Figure 29-75.

Chronic neutrophilic cholangitis retains the presence of neutrophils within the lumen of the bile ducts, but there may also be a significant number of mononuclear inflammatory cells and concentric peribiliary fibrosis may be evident.
Acute and chronic neutrophilic cholangitis occur in varying intensity and distribution. Some cases are uniform and diffuse and readily diagnosed, but in others there is an irregular distribution with only limited numbers of portal tracts affected and multiple biopsies may be required to confirm the diagnosis.
Lymphocytic Cholangitis
Lymphocytic cholangitis is characterized by infiltration the portal tracts by small lymphocytes, often associated with variable portal fibrosis, reactive biliary epithelium, and bile duct proliferation.13 Lymphocytic cholangitis is a relatively common hepatic disease in cats; the pathogenesis is unknown. Lymphocytic infiltrates centered on bile ducts or present in the biliary epithelium are evident, but in severe cases these infiltrates can bridge portal tracts (Fig. 29-76 ). Lymphoid follicle formation may occur. Centrilobular areas of the lobule are not affected. Apart from lymphocytes, occasional plasma cells and eosinophils may be present. The principal differential diagnosis for this disorder is lymphoma, and it can be difficult to discern the correct diagnosis on the basis of histologic evidence alone.
Figure 29-76.

Feline lymphocytic cholangitis is recognized by the intense lymphocytic infiltration of the portal tracts and associated biliary hyperplasia.
Destructive Cholangitis
Destructive cholangitis is characterized by necrosis or absence of biliary epithelium in smaller portal areas with infiltration of neutrophils and/or eosinophils and pigment laden macrophages (Fig. 29-77 ).14 In chronic forms portal fibrosis may develop. The cause is unknown, but destructive cholangitis may result from an idiosyncratic reaction to drugs, particularly sulfonamides. Other toxic insults and viral infection (e.g., canine distemper) also may be associated with destruction of biliary epithelium. It is not known if destruction and loss of the bile ducts is always permanent or recovery can occur.
Figure 29-77.

In destructive cholangitis the bile ducts are not evident within the portal tract and there is mononuclear cell infiltration with pigmented macrophages.
Chronic Cholangitis Associated with Liver Fluke Infestation
Several species of fluke can inhabit the bile ducts of cats and, less frequently, dogs. Chronic fluke-associated cholangitis results in dilated, fibrotic larger bile ducts. Histologically there are papillary projections and marked periductal and portal fibrosis with a slight to moderate inflammation within the ducts and portal areas (Fig. 29-78 ). Inflammatory cells within the lumina of the bile ducts are typically neutrophils and macrophages, while the portal inflammatory cells are usually neutrophils, lymphocytes and plasma cells. Eosinophils may be present, but usually only in small numbers. Typically there is no evidence of the adult flukes or eggs, but they may be present in a small proportion of cases.7 Cholangiocarcinomas have been reported in dogs and cats with chronic cholangitis caused by chronic fluke infestation.
Figure 29-78.

Fluke-associated cholangitis has a prominent dilation of bile ducts, an extensively thickened layer of connective tissue surrounding the duct, and, often, proliferation of the lining biliary epithelial cells. A moderate mononuclear cell infiltration is common.
Diseases of the Gallbladder
There are several disorders of the gallbladder that may be related, representing different stages of a single entity or separate disorders. These include cystic mucinous hyperplasia, gallbladder mucocele, and gall bladder infarction.
Cystic Mucinous Hyperplasia
Cystic mucinous hyperplasia of the gallbladder is characterized by prominent hyperplasia of the gallbladder epithelium. Well-differentiated hyperplastic epithelium forms numerous papillary projections that contain mucin and impart a honeycombed appearance to the mucosa. This change is common in older dogs, but uncommon in cats, and is of no clinical significance.
Gallbladder Mucocele
The accumulation of dark, gelatinous to semisolid bile-stained material, presumably abnormal bile or gallbladder epithelial secretions is characteristic of gallbladder mucocele. This disorder occurs in dogs and there is evidence of breed predisposition (e.g., Shetland Sheepdogs).15 The gallbladder and, occasionally, the cystic and common bile duct, may become distended with this material and cause extrahepatic cholestasis. Histologically there are fine strands of hyperplastic biliary epithelium that extend into the intraluminal material. Inflammatory changes are variable and may depend on the degree of injury or vascular compromise to the gallbladder wall caused by the expanding material within the gallbladder (Fig. 29-79 ). Inflammation can be negligible when affected gallbladders are removed early, but fibrin, neutrophilic infiltrates and acute necrosis can be evident where the gallbladder has ruptured. Adjacent liver parenchyma may display biliary hyperplasia and mild to moderate inflammatory infiltrates within the portal tracts, sometimes with reduced portal vein profiles.
Figure 29-79.

Gallbladder mucoceles are characterized by abundant, thick mucinous material within the lumen of the gallbladder. The mucosa is proliferative and may form papillary projections.
Gallbladder Infarction
Gallbladder infarction occurs in dogs and appears to be distinct from cholecystitis (see “Cholecystitis” section below) in that inflammation is not reported to be significant.16 Rather, there is acute full-thickness necrosis of the gallbladder wall, and on occasion, evidence of thrombi or degenerative changes in the cystic artery or its branches. Gallbladder rupture can be associated with infarction.
Cholecystitis
Neutrophilic Cholecystitis
Neutrophilic cholecystitis is typically associated with ascending bacterial infection from the intestine. It is common in cats and rare in dogs. Neutrophilic cholecystitis may occur in concert with neutrophilic cholangitis or as a single entity. Histologically there are neutrophils in the gallbladder lumen, as well as in the epithelium and muscularis of the gallbladder. In the acute stages only erosion and ulceration of the epithelium may be evident. Over time there is mixed inflammatory infiltration of neutrophils, lymphocytes, and plasma cells, and, in some cases, fibrosis.
Lymphoplasmacytic and Follicular Cholecystitis
This diagnosis is warranted when the lymphoplasmacytic infiltrate within the mucosa of the gallbladder exceeds the normal background content of these cells. The cause is unknown. Occasionally lymphoid follicles may be present in apparently normal gallbladder mucosa so it can be difficult to distinguish a true inflammatory condition if there is only a small amount of tissue to evaluate.
Parenchymal Disorders
Vacuolar Disorders
Cytoplasmic vacuolation of hepatocytes occurs for a variety of reasons, some physiologic and others as part of a disease process. Consequently, the diagnosis of vacuolar hepatopathy is vague and often uninformative.17 In young animals, particularly those with abnormal growth, storage disorders may cause vacuolation of hepatocytes and possibly Kupffer cells. In older animals the vacuoles almost always contain lipid or glycogen. Identification of the contents can help determine pathogenesis, particularly in storage disorders. There are distinct syndromes involving either glycogen or lipid; however, there are circumstances in which both substances are present and their relationship to the disease state of the patient is unknown. The physiologic mechanisms that lead to glycogen or to lipid accumulation are, for the most part, different. Some disorders associated with vacuole formation are discussed later.
Hepatocellular Steatosis (Lipidosis or Fatty Liver)
Abnormally increased lipid within hepatocytes is termed hepatocellular lipidosis or fatty liver. Hepatic steatosis may be part of a normal physiologic response or, in more advanced cases, a form of reversible injury. Hepatocellular steatosis can occur in a variety of disturbances of normal lipid metabolism or disease syndromes in small animals.
Regardless of pathogenesis, the gross appearance of hepatocellular lipidosis is highly characteristic. Lipid accumulation imparts a pale yellow appearance to the liver. With increasing amounts of lipid the liver becomes progressively yellow and enlarges leading to hepatomegaly. The cut surface of the liver can develop a greasy texture and the liver becomes friable. Microscopically, lipid appears as clear, round, distinct cytoplasmic vacuoles. There are two microscopic forms of hepatic lipidosis, macro- and microvesicular.
Macrovesicular steatosis is the most common form of lipid encountered and is characterized by vacuoles that are larger than the hepatocyte nucleus and tend to displace the nucleus to the periphery of the cell (Fig. 29-80 ). Typically there are only one or two vacuoles per hepatocyte. Microvesicular steatosis is characterized by multiple fine vacuoles that are smaller than the nucleus and that fill the cytoplasm without displacing the nucleus (Fig. 29-81 ). In man and rodents microvesicular lipidosis is associated with injury to mitochondria and more severe liver dysfunction than macrovesicular lipidosis, but this has not been thoroughly investigated in dogs or cats. Microvesicular steatosis is seen most often in uncontrolled diabetes mellitus in dogs and in juvenile hypoglycemia of small-breed dogs in which the vacuoles are very small and may be diffuse or centrilobular. Mixed microvesicular and microvesicular lipidosis is common in the syndrome of feline hepatic lipidosis.
Figure 29-80.

The macrovesicular form of steatosis or fatty liver has large, round, well-delineated and clear vacuoles that are larger than the hepatocyte nucleus and tend to displace the nucleus.
Figure 29-81.

Microvesicular steatosis is recognized by the presence of multiple fine vacuoles that fill the hepatocyte cytoplasm but do not displace the nucleus.
In paraffin wax–embedded and H&E-stained sections, lipid appears as a clear space because lipids are removed during processing. Other substances (e.g., glycogen and products of some storage disorders) can also appear as clear vacuoles, so it is desirable to identify the contents of clear vacuoles. Lipid can be identified by staining frozen tissue with lipid stains (see Table 29-4).
The lobular distribution of lipid vacuoles can vary from centrilobular to periportal, or, in extreme cases, the pattern is termed massive, involving all hepatocytes within the lobule. In mild cases, lipids may only accumulate in specific portions of each lobule, typically the centrilobular regions, leading to an enhanced lobular pattern. Lipid within hepatocytes should be distinguished from lipid between hepatocytes, as hepatic stellate cells can accumulate lipids, particularly in cats, and appear as cells with large single clear vacuoles that bulge into the sinusoidal space. Focal lipid accumulations, usually with foamy macrophages that also contain pigment are common in older dogs and are termed lipogranulomas.
Lipid accumulation in hepatocytes is often nonspecific; however, evaluation should include the lobular distribution and possible contributing factors, as well as the type of lipid vacuoles.
Glycogen Accumulation
Glucose is normally stored within hepatocytes as glycogen and is often present in large amounts after eating. Abnormal hepatic accumulation of glycogen is most often encountered in dogs as a result of glucocorticoid hepatopathy; however, other metabolic perturbations involving glucose regulation, including diabetes mellitus and the glycogen storage diseases, can produce similar changes. Disturbances of adrenocortical function involving steroids other than glucocorticoids, excessive progestins, and treatment with d-penicillamine are also reported to cause glycogen vacuolation.
Glucocorticoid-induced hepatocellular degeneration is a specific disorder of dogs characterized by excessive hepatic accumulation of glycogen. Excessive amounts of endogenous or exogenous glucocorticoids cause extensive swelling of hepatocytes from the accumulation of glycogen. In severe cases of glucocorticoid hepatopathy, the liver is enlarged and pale. Hepatocytes are prominently swollen with clear cytoplasm and diaphanous strands of eosinophilic cytoplasm with a central nucleus (Fig. 29-82 ). The distribution can be diffuse, zonal, or involve individual cells. Glycogen is notoriously difficult to detect in such livers, but PAS staining with or without diastase (which digests glycogen and distinguishes glycogen from nonglycogen carbohydrates) may be used. Special stains may help to identify glycogen accumulation in mild cases but, should it be necessary, frozen sections collected immediately at the time of biopsy are more useful. Other hepatic changes associated with glycogen accumulation are margination of neutrophils in sinusoids and occasional foci of extramedullary hematopoiesis.
Figure 29-82.

Excessive hepatocellular glycogen accumulation occurs most often in the presence of excess exogenous or endogenous corticosteroids, although there are other causes. Affected hepatocytes have ballooned profiles with empty cytoplasm or just wispy strands of eosinophilic cytoplasm evident.
Glycogen storage diseases type Ia and type II also lead to glycogen accumulation within hepatocytes, and such disease generally presents in young dogs.
Storage Diseases
A variety of inherited metabolic disorders, usually enzyme deficiencies, lead to excessive retention of storage of materials in hepatocytes and Kupffer cells. These materials often produce clear vacuoles, although they can have many morphologic appearances. Vacuoles can, alternatively, contain granular or hyaline material or, in some instances, cytoplasmic yellow-brown material (Fig. 29-83 ). The appearance varies with the type of substances retained. These changes are usually nonspecific, and water- or lipid-soluble materials are often lost in routine tissue processing. In such cases the liver can be evaluated using frozen sections, plastic-embedded sections, or electron microscopy. The histologic appearance of the vacuoles is generally insufficient to make a definitive diagnosis. Identification of the storage product, the enzyme deficiency, or the defective gene is required. Some storage disorders (e.g., copper and cholesterol esters) may lead to necrosis, inflammation, and cirrhosis.
Figure 29-83.

Inherited storage disorders can lead to hepatocellular and/or Kupffer cell vacuolation. In some disorders the vacuoles may appear clear, as in this kitten.
Amyloidosis
Hepatic amyloidosis occurs in dogs and cats. Amyloidosis is not a single disease entity, but a term used for various diseases that lead to the deposition of proteins that are composed of β-pleated sheets of nonbranching fibrils. Secondary or reactive amyloidosis is most common in dogs and cats and occurs as a consequence of prolonged inflammation. Inherited or familiar amyloidosis occurs in Shar Pei dogs and Abyssinian, Siamese, and other oriental breeds of cats. Histologically, all forms of amyloid appear as bright eosinophilic amorphous deposits that are usually found along the sinusoids in the space of Disse, but can be found in the portal tracts and within blood vessel walls (Fig. 29-84 ). The diagnosis can be confirmed with Congo red staining, which imparts an apple-green fluorescence when viewed under polarized light. As amyloid impairs blood flow or the access of hepatocytes to blood, hepatocellular atrophy is common, although affected livers are often enlarged as a result of the accumulation of amyloid.
Figure 29-84.

Amyloidosis. Amyloid can be recognized by its uniform pale and eosinophilic appearance. It can be deposited in the sinusoidal spaces, as seen in the left of this image, and is associated with hepatocellular atrophy.
Inflammatory Disorders of the Liver
Acute Hepatitis
Regardless of the cause, acute hepatitis is characterized by hepatocellular necrosis or apoptosis, inflammation, and possibly regeneration. The pathologist should communicate the pattern and extent of necrosis and describe the type of inflammation present. If possible, the etiology and the age of the lesion should be identified.
Acute Viral Hepatitis
Viral infections of the liver typically occur in conjunction with systemic involvement. The most clinically significant hepatic infections are discussed next.
α-Herpes Viruses
Herpes virus infections in dogs and cats typically affect neonatal animals. Hepatic lesions are multifocal necrosis with scant inflammation. Necrosis may involve the portal tracts and the connective tissue surrounding the central and sublobular veins (Fig. 29-85 ). Infrequent intranuclear inclusions of hepatocytes and biliary epithelium, which are small and eosinophilic, are diagnostic but difficult to identify.
Figure 29-85.

Neonatal puppies are susceptible to herpes virus infections that cause multifocal random necrosis, but little inflammation in the liver and other organs.
Infectious Canine Hepatitis
Infection with canine adenovirus 1 (CAV-1) is the exception to the typical pattern of random distribution of lesions with infectious disease. The virus kills endothelial cells as well as hepatocytes and it may be that this vascular component produces local ischemia and the generalized centrilobular injury and necrosis superimposed on the random foci of hepatocellular necrosis (Fig. 29-86 ). The diagnostic feature associated with infection is the presence of prominent basophilic intranuclear inclusions with a clear rim of marginated chromatin in infected hepatocytes and endothelial cells, and, occasionally, in biliary epithelial cells (Fig. 29-87 ). Foci of necrosis are acute and coagulative, rimmed with apoptotic hepatocytes. Inflammation in the parenchyma and the portal tracts is typically minimal.
Figure 29-86.

Infectious canine hepatitis. Typically, infection with canine adenovirus I produces foci of necrosis with a centrilobular to bridging distribution and variable inflammation.
Figure 29-87.

Infectious canine hepatitis. Prominent basophilic intranuclear inclusions are readily found within hepatocytes.
Coronavirus (Feline Infectious Peritonitis)
FIP can affect the liver and other tissue sites. In the liver there is a characteristic vasculitis, as well as a perivenular and subcapsular inflammatory lesion that may consist of pyogranulomatous inflammation composed of foci of necrosis and infiltration of macrophages and degenerate neutrophils rimmed with lymphocytes, although in other cases lymphocytes and plasma cells may predominate (Fig. 29-88 ). Inflammation and necrosis usually also involve the liver capsule, which has prominent adherent fibrin with infiltrations of neutrophils and macrophages. The hepatic lesions can be similar in the effusive and the noneffusive forms of the disease.
Figure 29-88.

Feline infectious peritonitis. The characteristic lesion of this disease is perivascular inflammation composed of lymphocytes, macrophages, and neutrophils in varying proportions. Capsular injury and fibrin accumulation are also typical.
Acute Bacterial Hepatitis
Most bacteremias involve the liver, and the range of bacteria that can produce septicemia and hepatic disease in dogs and cats includes Salmonella spp., Leptospira spp., Clostridium piliforme, Francisella tularensis, Nocardia asteroides, Streptococcus spp., and various mycobacteria and enteric organisms such as E. coli. Acute infections can produce random multifocal areas of necrosis with neutrophilic infiltration (Figure 29-89, Figure 29-90 ). Culture is usually needed to distinguish the etiology. Some bacterial infections have somewhat distinctive changes. Leptospira infections, depending on the serotype, can produce prominent cholestasis, individualization of hepatocytes, increased hepatocellular proliferation, mixed inflammatory reactions in portal tracts, and scattered individual necrotic hepatocytes (Fig. 29-91 ). C. piliforme infections have slender elongated bacilli arranged in tangles within the cytoplasm of viable hepatocytes at the margins of the foci of random necrosis. The organisms are readily identified with silver stains. Mycobacterial infections are generally more chronic and produce granulomatous inflammation. Acid-fast bacilli within the lesion, although several forms of acid-fast stain may be required, are diagnostic. Infection with Helicobacter canis has been associated with multiple foci of necrosis and mixed inflammatory infiltrates in one young dog.18 Silver stains are necessary to identify the organisms in the tissue. Bartonella spp. have been described in a variety of inflammatory hepatic lesions, including granulomatous hepatitis.19
Figure 29-89.

Various bacteria that can cause bacteremia may shower the liver and produce a random distribution of hepatocellular necrosis and associated inflammation, usually with neutrophils predominating.
Figure 29-90.

Yersinia pseudotuberculosis infection in a cat. Bacterial infections that produce septicemia often produce multiple, randomly distributed foci of necrosis and suppuration.
Figure 29-91.

Leptospirosis can produce a pattern of hepatocyte individualization with mild lymphocytic portal infiltration.
Acute Protozoal Hepatitis
Apicomplexa protozoa, including Toxoplasma gondii, Neospora caninum, Sarcocystis canis, and Sarcocystis neurona, can infect the liver of dogs, usually as part of a neurologic or systemic disease process.20 As in most infectious diseases, there is a random pattern of lesions in the liver. Hepatic infection with T. gondii is characterized by a random, diffuse to confluent pattern of lesions with a central area of necrosis surrounded by in a modest mixed inflammatory infiltration of neutrophils, macrophages, and other mononuclear cells (Fig. 29-92 ). Cysts containing bradyzoites and free tachyzoites may be found within and adjacent to these lesions. Hepatic lesions caused by S. canis do not occur in all infections, but include multifocal and portal inflammation, which may involve the limiting plate, with neutrophils, mononuclear cells, giant cells, and foci of necrosis within which intrahistiocytic schizonts and free merozoites can be found.
Figure 29-92.

Toxoplasma gondii infection in a cat. Infection with Toxoplasma spp. and other protozoa typically produce multiple, randomly distributed foci of necrosis and a mixed inflammatory infiltrate. The presence of cysts with 1- to 2-µm basophilic merozoites is characteristic.
Hepatic Toxicity
As the recipient of all of the blood flow from the digestive tract, the liver is centrally positioned to protect the body from endogenous and ingested injurious substances. Consequently, it is also the most common site of toxic injury. Such injury often produces a characteristic distribution of acute coagulative necrosis within the hepatic lobule, most often centrilobular (Fig. 29-93 ). This pattern of toxin-induced injury is attributed to the higher content of cytochrome P450 enzymes in this area of the lobule. Hepatic metabolism of many molecules destined for excretion usually goes through a three step process that involves oxidation of the parent molecule, conjugation with a polar molecule (often glutathione), and transport across the canalicular membrane into the bile. Hepatocellular injury can arise when the initial oxidation step leads to an excess of the oxidized (or bioactive) parent molecule. This bioactive form can bind to cellular proteins, RNA, and cell membrane lipids, causing acute toxicity, and in other circumstances bind to DNA and lead to carcinogenicity. Many naturally occurring and therapeutic hepatotoxins (e.g., acetaminophen, xylitol, aflatoxin B1) produce centrilobular to massive necrosis, depending on the dose.21, 22, 23 Cats are particularly sensitive to hepatic toxins such as acetaminophen and this is likely because of less robust antioxidant defenses and hepatic drug conjugation pathways compared with the dog.24 Other types of toxins do not need hepatic metabolic activation and can cause injury directly, often producing random or periportal patterns of necrosis. However, drug- or chemical-induced acute necrosis in the periportal or midzone of the hepatic lobule is uncommon in dogs and cats.
Figure 29-93.

Acute centrilobular necrosis is characterized by extravasated blood cells and necrotic hepatocytes. This is a very common pattern for acute hepatic toxicities of many types and is also seen with acute hemolysis, blood loss, or cardiac decompensation.
Because the lobular model does not fully account for the three-dimensional anatomy of the liver, the pattern of acute necrosis more often irregularly bridges central areas with thick zones of necrosis. The degree and extent of necrosis can vary considerably from lobe to lobe and within lobes. Inflammation may be seen, but this is typically a nonspecific response to cell injury and death. The histologic appearance of acute toxic injury is heavily dependent on time, as a single insult can be nearly resolved in 3 to 4 days, depending on the severity of the initial insult. As a result, biopsies may fail to show significant lesions if the biopsy is obtained several days after a single exposure to a toxin, even though liver enzymes may still remain elevated. Centrilobular necrosis of the liver can also be caused by vascular disease, hypoxia, and some viruses, and must be distinguished from necrosis caused by toxins.
Massive acute necrosis is the most severe form of hepatic injury and affects all hepatocytes within the lobule (Fig. 29-94 ). This pattern can occur in dogs that have ingested toxic mushrooms such as Amanita phalloides,25 blue-green algae, or as severe, possibly idiosyncratic, toxicities following drugs such as sulfonamides or trimethoprim sulfonamide in dogs and benzodiazepine in cats.26, 27 Chronic drug toxicity can produce lesions typical of chronic hepatitis with fibrosis, possibly bridging, and mononuclear cell inflammation.
Figure 29-94.

Massive necrosis involves the loss of all hepatocytes within a lobule. Several toxins, particularly in high doses, can produce this lesion.
Chronic Hepatitis
Chronic hepatitis is common in dogs, but rare in the cat. The pathogenesis remains unclear. Some cases have been associated with leptospirosis, Bartonella spp., and experimental and spontaneous CAV-1 infection, but this is a minority of cases.7 Chronic hepatitis has also been reported in dogs treated with anticonvulsant drugs such as primidone, phenytoin, and phenobarbital, and in aflatoxicosis.28 Approximately half of the cases of chronic hepatitis are linked to intrahepatic copper excess, but many cases are idiopathic.29
Histologically, chronic hepatitis is characterized by an inflammatory infiltration of mononuclear cells, lymphocytes, and macrophages, but other cell types, plasma cells, neutrophils, and eosinophils can be present in varying proportions (Fig. 29-95 ).30 Other features include apoptosis or necrosis, regeneration, and fibrosis. The proportion and distribution of these components vary widely and it is appropriate for the pathologist to include in the diagnosis the activity and stage of the disease as well as the possible cause. The activity of the disease is determined by the amount of inflammation and extent of hepatocellular apoptosis and necrosis. The stage of the disease and the prognosis may be determined by the extent and pattern of fibrosis and the presence of architectural distortion. Early fibrosis may be seen as fine septa penetrating the parenchyma from the portal tracts or along the sinusoids. This is common in association with interface hepatitis (inflammation at the limiting plate). Fibrosis is usually the result of direct activation of hepatic stellate cells that are positioned in the space of Disse or related cells in the portal tract and connective tissue around the central vein. Increased connective tissue may be present or the collapse and condensation of the reticulin network because of hepatocyte injury and loss may give the appearance of increased fibrosis. The more advanced patterns of fibrosis may include portal-to-portal, portal-to-central and central-to-central bridging, or it may dissect the lobule. Other changes seen in chronic hepatic injury or hepatitis include regeneration and regenerative nodules of hepatic parenchyma, and proliferation of ductular structures at the periphery of the parenchymal nodules and within fibrous septa. These ductular structures may represent biliary hyperplasia or, in cases of severe injury, proliferation of bipotential hepatic progenitor cells. Histochemical stains for connective tissue may be helpful in detecting the amount and pattern of fibrosis, particularly in early and mild disease.
Figure 29-95.


A, Chronic hepatitis. The hallmarks of chronic hepatitis are hepatocellular degeneration and death, fibrosis, usually in bridging bands with variable amounts of biliary hyperplasia and inflammation. Evidence of hepatocellular regeneration may be present. B, The connective tissue can be viewed more easily with special stains such as Mallory's trichrome that stains collagen blue.
Copper-Associated Hepatitis
Copper accumulation occurs in dogs and occasionally in cats. Progressive hepatic copper storage leading to inflammation and necrosis is well recognized in Bedlington Terriers because of a mutation in the COMM-D gene. Other breeds can also have elevated liver copper levels, but the disease process is not as well characterized.31 Affected breeds with apparently familial disease include the West Highland White Terrier,32 Skye Terrier,33 and Dalmatian.34 Chronic hepatitis and elevated liver copper has also be described in the Doberman Pinscher,35 Labrador Retriever,36, 37 and American and English Cocker Spaniel, and likely occurs in other breeds.
Histologically, the pattern is similar in all affected dogs. Hepatocellular copper accumulation is first evident in centrilobular hepatocytes as intracytoplasmic granules. With progressive accumulation retained copper results in hepatocellular necrosis, inflammation with copper-laden macrophages forming small aggregates, and, finally, chronic hepatitis and cirrhosis (Fig. 29-96 ). Healthy dogs with normal livers may have copper levels of 400 to 500 mg/g dry weight, but some dogs can have higher liver copper burdens without significant liver disease.
Figure 29-96.

Retained hepatocellular copper can be seen more readily when special stains such as rhodanine are used, imparting an orange tint to the copper and associated binding proteins.
Canine Idiopathic Chronic Hepatitis
Chronic hepatitis that is not associated with excessive copper retention remains a conundrum. The histology is typical of that described previously for chronic inflammation of the liver. Suggestions of breed predispositions to chronic hepatitis have been reported.31 Drug toxicity, immune-mediated disorders, α1-antitrypsin deficiency, and chronic infections may play a role, but the majority of cases are idiopathic.29, 38
Granulomatous Hepatitis
Granulomatous hepatitis can result from the presence of any persistent antigen, including infectious agents such as mycobacteria, parasites, and fungi. Some cases do not have a clear etiology and novel infectious agents such as Bartonella spp. or atypical inflammatory responses or drug reactions have been suggested.
End-Stage Liver (Cirrhosis)
The terms end-stage liver and cirrhosis each have their adherents, but debate on the proper terminology remains. The WSAVA Liver Study group recommends the use of the term cirrhosis and supports the following definition for cirrhosis: a diffuse process characterized by fibrosis with conversion of normal hepatic architecture into structurally abnormal nodules and the presence of portal-to-central vascular anastomoses.7 Bridging fibrosis is a regular feature, but fibrosis within the space of Disse also occurs and disrupts the interface between hepatocytes and the sinusoidal plasma. The pathologist should communicate to the clinician the extent and pattern of the fibrosis, the activity of the disease and, if possible, the likely etiology.
There are two morphologic categories of cirrhosis: micronodular cirrhosis with nodules less than 3 mm and regular in size, and macronodular cirrhosis with nodules greater than 3 mm and irregular in size. It is believed that micronodular cirrhosis develops from regular and diffuse injury and fibrosis. In contrast, macronodular cirrhosis develops from larger irregularly distributed areas of necrosis with secondary collapse and scarring (Fig. 29-97 ). In dogs, the histologic features also include proliferation of ductular structures and varying degrees of inflammation, bile stasis, lipidosis, and glycogen accumulation. Ascites and multiple acquired portosystemic shunts may develop when hepatic fibrosis disrupts hepatic blood flow leading to portal hypertension. Diminished hepatic function interferes with albumin synthesis, which can accentuate the formation of ascites. An idiopathic syndrome of hepatic fibrosis, unrelated to chronic injury has been reported in dogs and should be distinguished from typical cirrhosis.39
Figure 29-97.

Macronodular cirrhosis. This condition is characterized by the formation of regenerative nodules that are greater than 3 mm in diameter. Irregular fibrosis is also evident.
Cirrhosis is uncommon in cats. Affected cats may have diffuse hepatic fibrosis and disruption of the normal lobular pattern, usually as the result of chronic biliary disease, but rarely have nodules of regeneration. These cats may also have inflammation and proliferation of ductular structures.
Hepatocutaneous Syndrome (Superficial Necrolytic Dermatitis)
Hepatocutaneous syndrome is a disorder of dogs in which there is a combination of abnormalities in the liver and the skin, except in less-common cases where the skin disease is related to a glucagon-producing tumor of the pancreatic islet. Typically the hepatic lesion is a form of cirrhosis that has some atypical features. The liver, in this syndrome, is divided into multiple large confluent nodules, which are separated by prominent, enlarged hepatocytes containing clear vacuoles. Fibrous septa may be found between the nodules, although they may be less robust than in typical macronodular cirrhosis and in some cases nodules may only be separated by collapsed and condensed hepatic extracellular matrix. These septa usually contain proliferations of ductular structures and macrophages. Necrosis and inflammation are usually absent.
Lobular Dissecting Hepatitis
Lobular dissecting hepatitis occurs in young or young adult dogs as isolated cases or in groups of dogs from the same litter or kennel. Clinically, affected dogs deteriorate rapidly, but the histologic lesion is a form of cirrhosis. The liver usually has a normal size with a smooth capsular surface or may have some small nodules of regeneration. Microscopically, bands of fibroblasts (or myofibroblasts) and thin strands of extracellular matrix are seen between individual and small groups of hepatocytes that cause dissection of the original lobular architecture (Fig. 29-98 ). Connective tissue stains demonstrate the pattern of connective tissue alterations. Inflammation is usually light and hepatocellular death is not a prominent feature. The cause is unknown.
Figure 29-98.


Lobular dissecting hepatitis. A, The normal lobular architecture is disrupted by the many fine fibrous septa that divide and distort hepatic plates. B, The presence of the fibrous septa can be more readily seen as blue linear material in this Mallory's trichrome stain.
Hepatic Abscesses
Hepatic abscesses can occur as single or multiple lesions in dogs and cats. Isolated organisms are predominately of enteric origin.40, 41 Abscesses contain central areas of suppuration and the surrounding hepatocytes may be necrotic, degenerate, or relatively normal, depending on the cause and maturation of the abscess.
Nonspecific Reactive Hepatitis
Nonspecific reactive hepatitis is not a disease, but is a recognizable response of the liver to a variety of extrahepatic disease processes, especially those involving the splanchnic bed or febrile illnesses. It may also be the residuum of an earlier hepatic disease. The importance of this diagnosis is the realization that the liver is responding to a systemic problem and that there is no primary liver disease, although there may be elevated liver-related enzymes and other clinical signs. The histologic pattern of nonspecific reactive hepatitis is characterized by an inflammatory infiltrate in portal areas and in the parenchyma. Hepatocellular necrosis is not usually evident (Fig. 29-99 ). Neutrophils may predominate in a proportion of the portal areas in acute extrahepatic diseases. There is slight to marked accumulation of inflammatory cells within the sinusoids and Kupffer cells may be prominent because of hyperplasia or hypertrophy. The central vein connective tissue may have similar changes to those in the portal tracts. The chronic form of nonspecific reactive hepatitis is characterized by infiltration of mononuclear cells, plasma cells and lymphocytes, and pigmented macrophages. The connective tissue around the central and sublobular veins, as in the case of acute disease, may mimic the changes in the portal tracts. This disorder has been termed mild (neutrophilic or lymphocytic) cholangiohepatitis, which is misleading, as the disease process does not involve the hepatic parenchyma or the biliary tree as a primary component of the disease process.
Figure 29-99.


Nonspecific reactive hepatitis. This is a nonspecific response to extrahepatic inflammation or injury, usually in the gastrointestinal tract. A, Portal tracts contain a modest inflammatory infiltrate that may be composed of neutrophils or mononuclear cells (as in this case) depending on the type and duration of the condition. B, Similar changes can occur within the connective tissue surrounding the sublobular veins. Hepatocellular necrosis is not evident.
Eosinophilic Hepatitis
Eosinophilic hepatitis is of unknown cause. It can be regarded as a nonspecific reactive hepatitis particularly associated with allergic conditions and hypereosinophilic syndromes, and is more common in cats than dogs. Histologically, this condition may be present as part of a mixed inflammatory infiltrate in portal and perivenous areas and less frequently within the sinusoids. A distinct and less-common process of prominent eosinophilic hepatic inflammation is most likely associated with migrating nematode larvae or other parasitic infections. Rare drug reactions may involve an eosinophilic response, as can be seen in man.
Parasitic Helminths
The livers of dogs and cats can be infected with a variety of helminthes. Most cestode infections lead to cystic change grossly. There are no significant nematodes that infect the liver of dogs and cats, apart from Calodium hepaticum (formerly Capillaria hepatica) and these produce granulomatous reactions to the deposited eggs. Adults and eggs with typical polar caps can be seen within the lesions. Larval migration often produces tracts of acute necrosis at the early stages and encysted larvae provoke granulomas. Trematodes of clinical significance are discussed above under biliary disease.
Proliferative Disorders of the Liver
Nonneoplastic Proliferative Lesions
Hepatocellular Nodular Hyperplasia
Hepatocellular nodular hyperplasia is common in older dogs, but rare in cats. The incidence of nodular hyperplasia in dogs is age-related, becoming evident at approximately 6 years of age, without predilection for either sex or breed.42 The cause of these nodules is unknown. Nodular hyperplasia has no clinical impact, but because this change is readily detected with contemporary imaging techniques, the nodules should be distinguished from metastatic or primary hepatic neoplasms and regenerative nodules. Multiple hyperplastic nodules may occur, but often only a single mass is evident. Typically, the nodules are raised above the capsular surface and appear hemispherical. The color of the nodules can vary considerably, ranging from yellow to tan, to dark red when congested. The nodules vary in size with the smallest evident only microscopically and others as large as 3 cm in diameter. They are well demarcated from the normal parenchyma and usually compress adjacent parenchyma (Fig. 29-100 ). Hyperplastic nodules maintain a semblance of lobular architecture, but the lobular pattern is distorted, as portal tracts are separated by greater than normal and varying distances. Hepatocytes in nodular hyperplasia frequently contain lipid or glycogen vacuoles.
Figure 29-100.

Nodular hyperplasia. Most older dogs have areas of nodular hyperplasia. Typically the remainder of the liver is completely normal and there are one or several expansile masses of well-differentiated hepatocytes present.
Regenerative Nodules
Regenerative nodules occur primarily in dogs and are not age related, but arise from the proliferation of hepatocytes in response to damage and loss. Often the source of the insult is unknown. They are typically multiple and often so numerous in macronodular cirrhosis that the affected liver resembles a cluster of grapes. The nodules can be smaller than 1 cm in diameter or up to several centimeters in diameter (see Fig. 29-97). Regenerative nodules are separated by septa of collapsed hepatic stroma, variable amounts of collagen and other newly synthesized extracellular matrix, proliferated bile ducts and variable inflammation, typically composed of mononuclear cells. Nodules are typically pale red-brown to darker mahogany, but may be pale when they contain lipid. Because these lesions result from the outgrowth of surviving hepatocytes, there is usually only a single portal tract apparent in sections. Hepatocytes in regenerative nodules are well differentiated. Regenerative nodules are readily distinguished from nodular hyperplasia since regenerative nodules occur in the presence of significant injury, fibrosis, and disruption of normal hepatic parenchymal architecture.
Neoplastic Lesions: Primary Hepatic Neoplasia
Primary liver tumors can arise from epithelial (e.g., hepatocytes, biliary epithelium of bile ducts or the gallbladder), neuroendocrine, or mesenchymal elements (e.g., connective tissue and blood vessels).
Hepatocellular Adenoma
Hepatocellular adenomas are benign neoplasms that are typically single, red or brown unencapsulated masses that compress adjacent parenchyma. They are usually spherical and can be less than 1 cm in diameter, or they may be quite large, involving the majority of a liver lobe. On occasion they may be pedunculated. Small to moderate areas of hemorrhage and necrosis may occur within the center of the tumor.
Macroscopic differential diagnoses for hepatocellular adenomas include nodular hyperplasia, regenerative nodules, hepatocellular carcinoma, and metastatic masses. Histologic examination is often needed to make a final determination. Histologically, hepatocellular adenomas are compressive masses composed of well-differentiated hepatocytes that form uniform plates up to two to three cells thick. Within the mass there is usually no more than a single portal tract (Fig. 29-101 ). Adenomatous hepatocytes tend to abut normal adjacent hepatocytes at right angles. Cystic areas of necrosis, hemorrhage, or serum, as well as foci of extramedullary hematopoiesis can be present. Hepatocellular adenomas can be difficult to distinguish from hepatocellular nodular hyperplasia in biopsies because of similarity between the level of differentiation of the hepatocytes in both lesions. Unlike adenomas, nodular hyperplasia retains normal lobular architectural elements, although the portal tracts are more separated than normal. In small biopsies it is nearly impossible to distinguish regenerative nodules from hepatocellular adenomas, as many microscopic features are identical, such as the degree of differentiation of the hepatocytes and the paucity of portal tracts. However, regenerative nodules arise in a background of hepatocellular injury and are typically multiple so an appropriate clinical history can aid in the correct interpretation. Hepatocellular adenomas are most likely underdiagnosed and often confused with well-differentiated hepatocellular carcinomas because diagnostic criteria have been imprecise but the advent of newer criteria should clarify this issue.7
Figure 29-101.

Hepatocellular adenomas are characterized by well-differentiated hepatocytes that form a uniformly expansile mass that compresses adjacent parenchyma. Central necrosis may occur, as it does in this case.
Hepatocellular Carcinoma
Hepatocellular carcinomas are typically gray-white or yellow-brown masses that are subdivided into lobules by multiple fibrous bands. They are often quite friable. Hepatocellular carcinomas are often solitary, frequently involve an entire lobe, and are well demarcated, although these tumors can also form multiple nodules within the liver via intrahepatic metastasis or possibly multiple sites of origin.43 Massive forms involving the entire liver can also occur.43 Areas of necrosis and hemorrhage are common. Histologically, malignant hepatocytes can form trabecular, pseudoglandular, or solid patterns. All three patterns can be found in a single neoplasm. Trabeculae are variably thick with three or more cells forming a trabecula and there may be prominent vascular spaces between the trabeculae (Fig. 29-102 ). In the pseudoglandular pattern neoplastic cells line a space that may contain eosinophilic fluid. Solid variants are composed of sheets of neoplastic hepatocytes (Fig. 29-103 ). Neoplastic hepatocytes can range from well-differentiated to highly anaplastic spindle cells. Pleomorphic and giant cells can occur. Bile plugs may be found in canaliculi. Metastasis to a variety of sites may occur, particularly to lymph nodes within the anterior abdomen, lungs, and seeding into the tissues of the peritoneal cavity.43, 44 Intrahepatic metastasis is also possible. The rate of metastasis of hepatocellular carcinomas is an area of considerable debate. Early references suggest a relatively high rate of metastasis (more than 60%),43 although most were reported to occur in the hepatic lymph node. Other reports indicated a rate of metastasis half of this level.44 More recent surveys are not available, but the conclusion of a consensus panel of veterinary hepatic pathologists was that metastasis of hepatocellular tumors to other organs was very uncommon. In the absence of metastasis, a clear indication of malignancy, the most useful criteria of malignancy are (a) invasion by malignant hepatocytes into local veins and through the interface between the tumor mass and the normal adjacent compressed normal hepatocytes; (b) prominent hepatocellular atypia, including pleomorphism, anisokaryosis, prominent nucleoli, and giant cells; and (c) increased mitotic index.
Figure 29-102.

Hepatocellular carcinomas may have an irregular trabecular arrangement with intervening vascular channels.
Figure 29-103.

Varying sizes and shapes of neoplastic hepatocytes and their nuclei (pleomorphism) are a characteristic feature of hepatocellular carcinoma, as seen in this pulmonary metastasis of a primary hepatocellular carcinoma.
Cholangiocellular (Biliary) Adenoma
Cholangiocellular adenomas are benign tumors of biliary epithelium and are uncommon in dogs and cats. There is ongoing debate regarding the proper terminology for proliferative biliary lesions. In one new classification scheme7 the majority of multicystic biliary lesions are interpreted as congenital biliary anomalies; however, there are pathologists who consider these lesions to be benign neoplasms. When multicystic disorders of the biliary and renal epithelium occur in the same animal, they are readily identified as developmental disorders. Given the similarity between lesions found only in the liver and those found in combination with renal cysts, it is likely that the majority of multicystic biliary lesions arise from congenital malformations. In keeping with the WSAVA classification, true adenomas of the biliary ducts are discrete, firm, gray or white masses comprised of well-differentiated biliary epithelium that forms narrow tubular or ductular structures lined with cuboidal epithelium and scant intervening connective tissue.7
Cholangiocellular (Biliary) Carcinoma
Cholangiocellular carcinomas occur in dogs and cats and usually arise from the intrahepatic ducts. Biliary epithelial malignancies may form a single mass or more often, multiple masses are scattered throughout the liver, possibly as a result of intraorgan metastasis. Tumor masses are pale gray to tan and unencapsulated. Cholangiocellular carcinomas can be distinguished from hepatocellular carcinomas by their firm texture, frequent presence of umbilication, and typically widespread distribution throughout the liver.
The tumors are composed of cells that retain a resemblance to biliary epithelium. Characteristically, well-differentiated carcinomas are organized into a tubules or acini lined by cuboidal to columnar epithelium. Well-differentiated tumors often contain mucin within the lumina of the tubules (Fig. 29-104 ). Bile pigment is not a feature of these tumors. In less-well-differentiated neoplasms some acinar arrangements can be detected among solid masses of neoplastic cells. Poorly differentiated carcinomas are composed of packets or cords and areas of squamous differentiation can occur. Tumor cells typically have a clear or pale eosinophilic cytoplasm. Nuclei remain round and mitotic figures are typically abundant. The epithelial components of the tumors are usually separated by abundant fibrous connective tissue (a scirrhous response) that is responsible for their firm texture. The growth pattern of this tumor is aggressive and the margins of cholangiocarcinomas are characterized by multiple sites of invasion into the surrounding hepatic parenchyma. Multiple sites of hepatic necrosis are also common in the adjacent parenchyma.
Figure 29-104.

Biliary carcinoma is histologically typified by the presence of numerous small- to large-caliber tubular structures lined by cuboidal biliary epithelium. Dense connective tissue separates the tubular structures, imparting a firm texture to these masses.
Metastasis to extrahepatic sites is common, particularly to the adjacent lymph nodes of the anterior abdomen, lungs, or by seeding into the abdominal cavity. Metastasis into the peritoneal cavity can produce variably sized nodules within the mesentery and on the serosal surface of the abdominal viscera.
Hepatic Carcinoids
Hepatic carcinoids are uncommon in dogs and cats, and most likely originate from neuroendocrine cells that lie within the hepatic parenchyma or biliary epithelium. These tumors have an aggressive course and frequently metastasize.45, 46 They may appear as a single mass, but multiple nodules can occur, probably secondary to intrahepatic metastasis. Cells tend to be small, oval to elongate or spindle-shaped, and form ribbons or rosettes. Neoplastic cells tend to be grouped into small islands separated by fine fibrovascular stoma (Fig. 29-105 ). Immunohistochemical detection of neuroendocrine markers such as chromogranin A or glucagon, among others, can be used to confirm the diagnosis.
Figure 29-105.

Hepatic carcinoid. These tumors are characterized by their ribbon or rosette conformation composed of small to elongated cells with dark basophilic nuclei.
Primary Hepatic Neoplasms of Mesenchymal Origin
Any of the cellular constituents of the liver can give rise to primary neoplasms. However, as a result of the relatively high frequency of metastatic spread of malignant tumors to the liver, a careful and thorough necropsy examination, as well as a thorough review of the history to check for, among other issues, the evidence of previous surgeries, must be performed to ensure that the tumor in question is indeed a primary mass. The most common primary mesenchymal neoplasm of the liver is hemangiosarcoma, but hemangioma, fibrosarcoma, leiomyosarcoma, and osteosarcomas are also recognized. Myelolipomas are discrete, nodular tumors with a thin capsule composed of lipocytes and myeloid elements that occur in cats.
Hematopoietic tumors, particularly lymphoma, occur in the liver. Lymphoma can infiltrate and enlarge the liver imparting a pale discoloration. Microscopically, lymphoma is characterized by infiltrates of neoplastic lymphocytes into the portal tract connective tissue and around the central and sublobular veins (Fig. 29-106 ). With advancing disease the neoplastic lymphocytes extend into the parenchyma. Usually there is no evidence of biliary proliferation in lymphoma that can help distinguish this tumor from feline lymphocytic cholangitis. Other hematopoietic neoplasms, including myeloid and erythroid neoplasia, malignant histiocytosis, and mast cell tumors can be found in the liver, although neoplastic cells are more likely to collect along the sinusoids, rather than within the portal tracts.
Figure 29-106.

Lymphoma in the liver is manifested as dense lymphoid accumulations within and expanding the portal tracts, and occasionally involving the connective tissue around the central and sublobular veins. In advanced cases, neoplastic lymphocytes expand into the parenchyma.
Metastatic Tumors
The liver is one of the two most common sites for metastasis for a large variety of malignant tumors. Distinguishing metastatic neoplasms from primary tumors can be difficult, particularly in the case of poorly differentiated epithelial tumors. For example, exocrine pancreatic and mammary tumors can resemble primary cholangiocarcinoma. It is important to ensure that a thorough postmortem examination is done, or when evaluating a biopsy, that the complete history is available to determine whether masses have been removed previously.
References
Stomach
- 1.Dellman HD, Eurell JA. ed 5. Lippincott Williams & Wilkins; Philadelphia: 1998. Textbook of Veterinary Histology. p 179. [Google Scholar]
- 2.Samuelson DA. Elsevier; Philadelphia: 2007. Textbook of Veterinary Histology. p 323. [Google Scholar]
- 3.Fox LE, Rosenthal RC, Twedt DC. Plasma histamine and gastrin concentrations in 17 dogs with mast cell tumors. J Vet Intern Med. 1990;4:242. doi: 10.1111/j.1939-1676.1990.tb03116.x. [DOI] [PubMed] [Google Scholar]
- 4.Howard EB, Sawa TR, Nielsen SW. Mastocytoma and gastroduodenal ulceration. Gastric and duodenal ulcers in dogs with mastocytoma. Pathol Vet. 1969;6:146. doi: 10.1177/030098586900600205. [DOI] [PubMed] [Google Scholar]
- 5.Reimer ME, Johnston SA, Leib MS. The gastroduodenal effects of buffered aspirin, carprofen, and etodolac in healthy dogs. J Vet Intern Med. 1999;13:472. doi: 10.1892/0891-6640(1999)013<0472:tgeoba>2.3.co;2. [DOI] [PubMed] [Google Scholar]
- 6.Sennello KA, Leib MS. Effects of deracoxib or buffered aspirin on the gastric mucosa of healthy dogs. J Vet Intern Med. 2006;20:1291. doi: 10.1892/0891-6640(2006)20[1291:eodoba]2.0.co;2. [DOI] [PubMed] [Google Scholar]
- 7.Webb C, Twedt DC. Canine gastritis. Vet Clin North Am Small Anim Pract. 2003;33:969. doi: 10.1016/S0195-5616(03)00052-4. [DOI] [PMC free article] [PubMed] [Google Scholar]
- 8.Davis M, Willard M, Williamson K. Temporal relationship between gastrointestinal protein loss, gastric ulceration or erosion, and strenuous exercise in racing Alaskan sled dogs. J Vet Intern Med. 2006;20:835. doi: 10.1892/0891-6640(2006)20[835:trbgpl]2.0.co;2. [DOI] [PubMed] [Google Scholar]
- 9.Peters RM, Goldstein RE, Erb HN. Histopathologic features of canine uremic gastropathy: a retrospective study. J Vet Intern Med. 2005;19:315. doi: 10.1892/0891-6640(2005)19[315:hfocug]2.0.co;2. [DOI] [PubMed] [Google Scholar]
- 10.Van der Gaag I. The histological appearance of peroral gastric biopsies in clinically healthy and vomiting dogs. Can J Vet Res. 1988;52:67. [PMC free article] [PubMed] [Google Scholar]
- 11.Kapadia CR. Gastric atrophy, metaplasia, and dysplasia: a clinical perspective. J Clin Gastroenterol. 2003;36(5 Suppl):S29. doi: 10.1097/00004836-200305001-00006. [DOI] [PubMed] [Google Scholar]
- 12.Southorn EP: An improved approach to the histologic assessment of canine chronic gastritis. DVSc Thesis, University of Guelph, 2004.
- 13.Wiinberg B, Spohr A, Dietz HH. Quantitative analysis of inflammatory and immune responses in dogs with gastritis and their relationship to Helicobacter spp. infection. J Vet Intern Med. 2005;19:4. doi: 10.1892/0891-6640(2005)19<4:qaoiai>2.0.co;2. [DOI] [PubMed] [Google Scholar]
- 14.Day MJ, Bilzer T, Mansell J. Histopathological standards for the diagnosis of gastrointestinal inflammation in endoscopic biopsy samples from the dog and cat: a report from the World Small Animal Veterinary Association Gastrointestinal Standardization Group. J Comp Pathol. 2008;138:S1. doi: 10.1016/j.jcpa.2008.01.001. [DOI] [PubMed] [Google Scholar]
- 15.Happonen I, Saari S, Castren L. Occurrence and topographical mapping of gastric Helicobacter-like organisms and their association with histological changes in apparently healthy dogs and cats. J Vet Med A Physiol Pathol Clin Med. 1996;43:305. doi: 10.1111/j.1439-0442.1996.tb00457.x. [DOI] [PubMed] [Google Scholar]
- 16.Hermanns W, Kregel K, Breuer W. Helicobacter-like organisms: histopathological examination of gastric biopsies from dogs and cats. J Comp Pathol. 1995;112:307. doi: 10.1016/s0021-9975(05)80083-0. [DOI] [PubMed] [Google Scholar]
- 17.Lee A, Krakowka S, Fox JG. Role of Helicobacter felis in chronic canine gastritis. Vet Pathol. 1992;29:487. doi: 10.1177/030098589202900601. [DOI] [PubMed] [Google Scholar]
- 18.Norris CR, Marks SL, Eaton KA. Healthy cats are commonly colonized with Helicobacter heilmannii that is associated with minimal gastritis. J Clin Microbiol. 1999;37:189. doi: 10.1128/jcm.37.1.189-194.1999. [DOI] [PMC free article] [PubMed] [Google Scholar]
- 19.Shabestari AS, Mohammadi M, Jamshidi S. Assessment of chronic gastritis in pet dogs and its relation with Helicobacter-like organisms. Pak J Biol Sci. 2008;11:1443. doi: 10.3923/pjbs.2008.1443.1448. [DOI] [PubMed] [Google Scholar]
- 20.Simpson KW, McDonough PL, Strauss-Ayali D. Helicobacter felis infection in dogs: effect on gastric structure and function. Vet Pathol. 1999;36:237. doi: 10.1354/vp.36-3-237. [DOI] [PubMed] [Google Scholar]
- 21.Simpson KW, Strauss-Ayali D, Straubinger RK. Helicobacter pylori infection in the cat: evaluation of gastric colonization, inflammation and function. Helicobacter. 2001;6:1. doi: 10.1046/j.1523-5378.2001.00010.x. [DOI] [PubMed] [Google Scholar]
- 22.Takemura LS, Camargo PL, Alfieri AA. Helicobacter spp. in cats: association between infecting species and epithelial proliferation within the gastric lamina propria. J Comp Pathol. 2009;141:127. doi: 10.1016/j.jcpa.2009.01.002. [DOI] [PubMed] [Google Scholar]
- 23.Yamasaki K, Suematsu H, Takahashi T. Comparison of gastric lesions in dogs and cats with and without gastric spiral organisms. J Am Vet Med Assoc. 1998;212:529. [PubMed] [Google Scholar]
- 24.Lidbury JA, Suchodolski JS, Steiner JM. Gastric histopathologic abnormalities in dogs: 67 cases (2002-2007) J Am Vet Med Assoc. 2009;234:1147. doi: 10.2460/javma.234.9.1147. [DOI] [PubMed] [Google Scholar]
- 25.Qvigstad G, Kolbjornsen O, Skancke E. Gastric neuroendocrine carcinoma associated with atrophic gastritis in the Norwegian Lundehund. J Comp Pathol. 2008;139:194. doi: 10.1016/j.jcpa.2008.07.001. [DOI] [PubMed] [Google Scholar]
- 26.Theisen SK, LeGrange SN, Johnson SE. Physaloptera infection in 18 dogs with intermittent vomiting. J Am Anim Hosp Assoc. 1998;34:74. doi: 10.5326/15473317-34-1-74. [DOI] [PubMed] [Google Scholar]
- 27.Hargis AM, Prieur DJ, Blanchard JL. Prevalence, lesions, and differential diagnosis of Ollulanus tricuspis infection in cats. Vet Pathol. 1983;20:71. doi: 10.1177/030098588302000108. [DOI] [PubMed] [Google Scholar]
- 28.Miller DL, Liggett A, Radi ZA. Gastrointestinal cryptosporidiosis in a puppy. Vet Parasitol. 2003;115:199. doi: 10.1016/s0304-4017(03)00237-1. [DOI] [PubMed] [Google Scholar]
- 29.Berryessa NA, Marks SL, Pesavento PA. Gastrointestinal pythiosis in 10 dogs from California. J Vet Intern Med. 2008;22:1065. doi: 10.1111/j.1939-1676.2008.0123.x. [DOI] [PubMed] [Google Scholar]
- 30.Miller RI. Gastrointestinal phycomycosis in 63 dogs. J Am Vet Med Assoc. 1985;186:473. [PubMed] [Google Scholar]
- 31.MacDonald TT, Gordon JN. Bacterial regulation of intestinal immune responses. Gastroenterol Clin North Am. 2005;34:401. doi: 10.1016/j.gtc.2005.05.012. [DOI] [PubMed] [Google Scholar]
- 32.Macpherson AJ, Hapfelmeier S, McCoy KD. The armed truce between the intestinal microflora and host mucosal immunity. Semin Immunol. 2007;19:57. doi: 10.1016/j.smim.2007.04.001. [DOI] [PubMed] [Google Scholar]
- 33.Wagner RD. Effects of microbiota on GI health: gnotobiotic research. Adv Exp Med Biol. 2008;635:41. doi: 10.1007/978-0-387-09550-9_4. [DOI] [PubMed] [Google Scholar]
- 34.Leib MS, Saunders GK, Moon ML. Endoscopic diagnosis of chronic hypertrophic pyloric gastropathy in dogs. J Vet Intern Med. 1993;7:335. doi: 10.1111/j.1939-1676.1993.tb01028.x. [DOI] [PubMed] [Google Scholar]
- 35.Head KW, Cullen JM, Dubielzig RR. Armed Forces Institute of Pathology; Washington DC: 2003. Histological classification of tumors of the alimentary system of domestic animals. p 75. [Google Scholar]
- 36.Head KW, Else RW, Dubielzig RR. Tumors in Domestic Animals. ed 4. Iowa State Press; Ames: 2002. Tumors of the alimentary tract. [Google Scholar]
- 37.Pohlman LM, Higginbotham ML, Welles EG. Immunophenotypic and histologic classification of 50 cases of feline gastrointestinal lymphoma. Vet Pathol. 2009;46:259. doi: 10.1354/vp.46-2-259. [DOI] [PubMed] [Google Scholar]
- 38.Coyle KA, Steinberg H. Characterization of lymphocytes in canine gastrointestinal lymphoma. Vet Pathol. 2004;41:141. doi: 10.1354/vp.41-2-141. [DOI] [PubMed] [Google Scholar]
- 39.Lurie DM, Milner RJ, Suter SE. Immunophenotypic and cytomorphologic subclassification of T-cell lymphoma in the boxer breed. Vet Immunol Immunopathol. 2008;125:102. doi: 10.1016/j.vetimm.2008.05.009. [DOI] [PubMed] [Google Scholar]
- 40.Ozaki K, Yamagami T, Nomura K. T-cell lymphoma with eosinophilic infiltration involving the intestinal tract in 11 dogs. Vet Pathol. 2006;43:339. doi: 10.1354/vp.43-3-339. [DOI] [PubMed] [Google Scholar]
- 41.Steinberg H, Dubielzig R, Thomson J. Primary gastrointestinal lymphosarcoma with epitheliotropism in three Shar-Peis and one Boxer dog. Vet Pathol. 1995;32:423. doi: 10.1177/030098589503200413. [DOI] [PubMed] [Google Scholar]
- 42.Culbertson R, Branam JE, Rosenblatt LS. Esophageal/gastric leiomyoma in the laboratory beagle. J Am Vet Med Assoc. 1983;183:1168. [PubMed] [Google Scholar]
- 43.Patnaik AK, Hurvitz AI, Johnson GF. Canine gastrointestinal neoplasms. Vet Pathol. 1977;14:547. doi: 10.1177/030098587701400602. [DOI] [PubMed] [Google Scholar]
- 44.Frost D, Lasota J, Miettinen M. Gastrointestinal stromal tumors and leiomyomas in the dog: a histopathologic, immunohistochemical, and molecular genetic study of 50 cases. Vet Pathol. 2003;40:42. doi: 10.1354/vp.40-1-42. [DOI] [PubMed] [Google Scholar]
- 45.Maas CP, ter Haar G, van der Gaag I. Reclassification of small intestinal and cecal smooth muscle tumors in 72 dogs: clinical, histologic, and immunohistochemical evaluation. Vet Surg. 2007;36:302. doi: 10.1111/j.1532-950X.2007.00271.x. [DOI] [PubMed] [Google Scholar]
Intestine
- 1.Allenspach K, Wieland B, Grone A, Gaschen F. Chronic enteropathies in dogs: evaluation of risk factors for negative outcome. J Vet Intern Med. 2007;21:700. doi: 10.1892/0891-6640(2007)21[700:ceideo]2.0.co;2. [DOI] [PubMed] [Google Scholar]
- 2.Avery PR, Avery AC. Molecular methods to distinguish reactive and neoplastic lymphocyte expansions and neoplastic lymphocyte expansions and their importance in transitional neoplastic states. Vet Clin Pathol. 2004;33:196. doi: 10.1111/j.1939-165x.2004.tb00374.x. [DOI] [PubMed] [Google Scholar]
- 3.Bettini G, Morini M, Marcato PS. Gastrointestinal spindle cell tumours in the dog: histological and immunohistochemical study. J Comp Pathol. 2003;129:283. doi: 10.1016/s0021-9975(03)00046-x. [DOI] [PubMed] [Google Scholar]
- 4.Breitschwerdt EB, Ochoa R, Barta M. Clinical and laboratory characterization of basenjis with immunoproliferative small intestinal disease. Am J Vet Res. 1984;45:267. [PubMed] [Google Scholar]
- 5.Carman PS, Povey RC. Pathogenesis of canine parvovirus-2 in dogs: histopathology and antigen identification in tissues. Res Vet Sci. 1985;38:141. [PubMed] [Google Scholar]
- 6.Carreras JK, Goldschmidt M, Lamb M. Feline epitheliotropic intestinal malignant lymphoma: 10 cases (1997-2000) J Vet Intern Med. 2003;17:326. doi: 10.1111/j.1939-1676.2003.tb02456.x. [DOI] [PubMed] [Google Scholar]
- 7.Clinkenbeard KD, Cowell RL, Tyler RD. Disseminated histoplasmosis in dogs: 12 cases (1981-1986) J Am Vet Med Assoc. 1988;193:1443. [PubMed] [Google Scholar]
- 8.Coyle KA, Steinberg H. Characterization of lymphocytes in canine gastrointestinal lymphoma. Vet Pathol. 2004;41:141. doi: 10.1354/vp.41-2-141. [DOI] [PubMed] [Google Scholar]
- 9.Darbes J, Majzoub M, Breuer W, Hermanns W. Large granular lymphocyte leukemia/lymphoma in six cats. Vet Pathol. 1998;35:370. doi: 10.1177/030098589803500506. [DOI] [PubMed] [Google Scholar]
- 10.Day MJ. Biopsy handling, processing and interpretation. In: Hall E, Williams D, Simpson J, editors. BSAVA Manual of Canine and Feline Gastroenterology. ed 2. BSAVA; 2005. [Google Scholar]
- 11.Day MJ, Bilzer T, Mansell J. International standards for the histopathological evaluation of gastric, duodenal, and colonic biopsies in the dog and cat: A report from the World Small Animal Veterinary Association Gastrointestinal Standardization Group. J Comp Pathol. 2008;138:S1. doi: 10.1016/j.jcpa.2008.01.001. [DOI] [PubMed] [Google Scholar]
- 12.Dillon AR, Boosinger TR, Blevins WT. Campylobacter enteritis in dogs and cats. Comp Cont Educ Pract Vet. 1987;9:1176. [Google Scholar]
- 13.Evans SE, Bonczynski JJ, Broussard JD. Comparison of endoscopic and full-thickness biopsy specimens for diagnosis of inflammatory bowel disease and alimentary tract lymphoma in cats. J Am Vet Med Assoc. 2006;229:1447. doi: 10.2460/javma.229.9.1447. [DOI] [PubMed] [Google Scholar]
- 14.Flesja K, Yri T. Protein-losing enteropathy in Lundehunds. J Small Anim Pract. 1977;18:11. doi: 10.1111/j.1748-5827.1977.tb05819.x. [DOI] [PubMed] [Google Scholar]
- 15.French RA, Seitz SE, Valli VEO. Primary epitheliotropic alimentary T-cell lymphoma with hepatic involvement in a dog. Vet Pathol. 1996;33:349. doi: 10.1177/030098589603300315. [DOI] [PubMed] [Google Scholar]
- 16.Frost D, Lasota G, Miettinen M. Gastrointestinal stromal tumours and leiomyomas in the dog: a histopathologic, immunohistochemical and molecular genetic study of 50 cases. Vet Pathol. 2003;40:42. doi: 10.1354/vp.40-1-42. [DOI] [PubMed] [Google Scholar]
- 17.Gabor LJ, Canfield PJ, Malik R. Immunophenotypic and histological characterization of 109 cases of feline lymphosarcoma. Aust Vet J. 1999;77:436. doi: 10.1111/j.1751-0813.1999.tb12085.x. [DOI] [PubMed] [Google Scholar]
- 18.Gabor LJ, Malik R, Canfield PJ. Clinical and anatomical features of lymphosarcoma in 118 cats. Aust Vet J. 1998;76:725. doi: 10.1111/j.1751-0813.1998.tb12300.x. [DOI] [PubMed] [Google Scholar]
- 19.Garcia-Sancho M, Rodriguez-Franco F, Sainz A. Evaluation of clinical, macroscopic, and histopathologic response to treatment in nonhypoproteinemic dogs with lymphocytic-plasmacytic enteritis. J Vet Intern Med. 2007;21:11. doi: 10.1892/0891-6640(2007)21[11:eocmah]2.0.co;2. [DOI] [PubMed] [Google Scholar]
- 20.German A, Bland PW, Hall EJ, Day MJ. Expression of major histocompatibility complex class II antigens in the canine intestine. Vet Immunol Immunopathol. 1998;61:171. doi: 10.1016/s0165-2427(97)00144-x. [DOI] [PubMed] [Google Scholar]
- 21.German AJ, Hall EJ, Day MJ. Analysis of leucocyte subsets in the canine intestine. J Comp Pathol. 1999;120:129. doi: 10.1053/jcpa.1998.0262. [DOI] [PubMed] [Google Scholar]
- 22.German AJ, Hall EJ, Day MJ. Characterization of immune cell populations within the duodenal mucosa of dogs with enteropathies. J Vet Intern Med. 2001;15:14. doi: 10.1892/0891-6640(2001)015<0014:icpwtd>2.3.co;2. [DOI] [PubMed] [Google Scholar]
- 23.German AJ, Hall EJ, Day MJ. Chronic intestinal inflammation and intestinal disease in dogs. J Vet Intern Med. 2003;17:8. doi: 10.1892/0891-6640(2003)017<0008:ciiaid>2.3.co;2. [DOI] [PubMed] [Google Scholar]
- 24.German AJ, Hall EJ, Moore PF. Analysis of the distribution of lymphocytes expressing αβ and γδ T cell receptors and expression of mucosal addressin cell adhesion molecule-1 in the canine intestine. J Comp Pathol. 1999;121:249. doi: 10.1053/jcpa.1999.0328. [DOI] [PubMed] [Google Scholar]
- 25.Harkin KR, Andrews GA, Nietfeld JC. Dysautonomia in dogs: 65 cases (1993-2000) J Am Vet Med Assoc. 2002;220:633. doi: 10.2460/javma.2002.220.633. [DOI] [PubMed] [Google Scholar]
- 26.Harvey AM, Hall EJ, Day MJ. Chronic intestinal pseudo-obstruction caused by visceral myopathy in a domestic shorthair cat. J Vet Intern Med. 2005;19:111. doi: 10.1892/0891-6640(2005)19<111:cipiac>2.0.co;2. [DOI] [PubMed] [Google Scholar]
- 27.HogenEsch H, Felsburg PJ. Immunohistology of Peyer's patches in the dog. Vet Immunol Immunopathol. 1992;30:147. doi: 10.1016/0165-2427(92)90135-d. [DOI] [PubMed] [Google Scholar]
- 28.Huibregtse BA, Turner JL. Hypereosinophilic syndrome and eosinophilic leukemia: a comparison of 22 hypereosinophilic cats. J Am Anim Hosp Assoc. 1994;30:591. [Google Scholar]
- 29.Jergens AE, Moore FM, Haynes JS, Miles KG. Idiopathic inflammatory bowel disease in dogs and cats: 84 cases (1987-1990) J Am Vet Med Assoc. 1992;201:1603. [PubMed] [Google Scholar]
- 30.Jergens AE, Moore FM, Kaiser MS. Morphometric evaluation of immunoglobulin A-containing and immunoglobulin G-containing cells and T cells in duodenal mucosa from healthy dogs and from dogs with inflammatory bowel disease or nonspecific gastroenteritis. Am J Vet Res. 1996;57:697. [PubMed] [Google Scholar]
- 31.Jergens AE, Schreiner CA, Frank DE. A scoring index for disease activity in canine inflammatory bowel disease. J Vet Intern Med. 2003;17:291. doi: 10.1111/j.1939-1676.2003.tb02450.x. [DOI] [PubMed] [Google Scholar]
- 32.Johnston KL, Swift NC, Forster-van Hijfte M. Comparison of the bacterial flora of the duodenum in healthy cats and cats with signs of gastrointestinal tract disease. J Am Vet Med Assoc. 2001;218:48. doi: 10.2460/javma.2001.218.48. [DOI] [PubMed] [Google Scholar]
- 33.Kariya K, Konno A, Ishida T. Perforin-like reactivity in four cases of lymphoma of large granular lymphocytes in the cat. Vet Pathol. 1997;34:156. doi: 10.1177/030098589703400210. [DOI] [PubMed] [Google Scholar]
- 34.Kipar A, Kremendahl J, Jackson ML, Reinacher M. Comparative examination of cats with feline leukaemia virus-associated enteritis and other relevant forms of feline enteritis. Vet Pathol. 2001;38:359. doi: 10.1354/vp.38-4-359. [DOI] [PubMed] [Google Scholar]
- 35.Kleinschmidt S, Meneses F, Nolte I, Hewicker-Trautwein M. Retrospective study on the diagnostic value of full-thickness biopsies from the stomach and intestines of dogs with chronic gastrointestinal disease symptoms. Vet Pathol. 2006;43:1000. doi: 10.1354/vp.43-6-1000. [DOI] [PubMed] [Google Scholar]
- 36.Kosovsky JE, Matthiesen DT, Patnaik AK. Small intestinal adenocarcinoma in cats: 32 cases (1978-1985) J Am Vet Med Assoc. 1988;192:233. [PubMed] [Google Scholar]
- 37.Kull PA, Hess RS, Craig LE. Clinical, clinicopathologic, radiographic, and ultrasonographic characteristics of intestinal lymphangiectasis in dogs: 17 cases (1996-1998) J Am Vet Med Assoc. 2001;219:197. doi: 10.2460/javma.2001.219.197. [DOI] [PubMed] [Google Scholar]
- 38.Louwerens M, London CA, Pedersen NC, Lyons LA. Feline lymphoma in the post-feline leukemia virus era. J Vet Intern Med. 2005;19:329. doi: 10.1892/0891-6640(2005)19[329:flitpl]2.0.co;2. [DOI] [PubMed] [Google Scholar]
- 39.MacDonald JM, Mullen HS, Moroff SD. Adenomatous polyps of the duodenum in cats: 18 cases (1985-1990) J Am Vet Med Assoc. 1993;202:647. [PubMed] [Google Scholar]
- 40.Moore PF, Woo JC, Vernau W. Characterization of feline T cell receptor gamma (TCRG) variable region genes for the molecular diagnosis of feline intestinal T cell lymphoma. Vet Immunol Immunopathol. 2005;106:167. doi: 10.1016/j.vetimm.2005.02.014. [DOI] [PubMed] [Google Scholar]
- 41.Munster M, Horauf A, Bilzer T. Assessment of disease severity and outcome of dietary, antibiotic, and immunosuppressive interventions by use of the canine IBD activity index in 21 dogs with inflammatory bowel disease. Berl Munch Tierarztl Wochenschr. 2006;119:493. [PubMed] [Google Scholar]
- 42.Ozaki K, Yamagami T, Nomura K, Narama I. T-cell lymphoma with eosinophilic infiltration involving the intestinal tract in 11 dogs. Vet Pathol. 2006;43:339. doi: 10.1354/vp.43-3-339. [DOI] [PubMed] [Google Scholar]
- 43.Ozaki K, Yamagami T, Nomura K. Mast cell tumors of the gastrointestinal tract in 39 dogs. Vet Pathol. 2002;39:557. doi: 10.1354/vp.39-5-557. [DOI] [PubMed] [Google Scholar]
- 44.Paoloni MC, Penninck DG, Moore AS. Ultrasonographic and clinicopathologic findings in 21 dogs with intestinal adenocarcinoma. Vet Radiol Ultrasound. 2002;43:562. doi: 10.1111/j.1740-8261.2002.tb01050.x. [DOI] [PubMed] [Google Scholar]
- 45.Papasouliotis K, Sparkes AH, Werrett G. Assessment of the bacterial flora of the proximal part of the small intestine in healthy cats, and the effect of sample collection method. Am J Vet Res. 1998;59:48. [PubMed] [Google Scholar]
- 46.Patterson-Kane JC, Perrins Kugler B, Francis K. The possible prognostic significance of immunophenotype in feline alimentary lymphoma: a pilot study. J Comp Pathol. 2004;130:220. doi: 10.1016/j.jcpa.2003.09.008. [DOI] [PubMed] [Google Scholar]
- 47.Paulsen DB, Buddington KK, Buddington RK. Dimensions and histologic characteristics of the small intestine of dogs during postnatal development. Am J Vet Res. 2003;64:618. doi: 10.2460/ajvr.2003.64.618. [DOI] [PubMed] [Google Scholar]
- 48.Perkins MC, Watson ADJ. Successful treatment of hypereosinophilic syndrome in a dog. Aust Vet J. 2001;79:686. doi: 10.1111/j.1751-0813.2001.tb10671.x. [DOI] [PubMed] [Google Scholar]
- 49.Platz SJ, Breuer W, Pfleghaar S. Prognostic value of histopathological grading in canine extramedullary plasmacytomas. Vet Pathol. 1999;36:23. doi: 10.1354/vp.36-1-23. [DOI] [PubMed] [Google Scholar]
- 50.Polvi A, Garden OA, Houlston RS. Genetic susceptibility to gluten sensitive enteropathy in Irish setter dogs is not linked to the major histocompatibility complex. Tissue Antigens. 1998;52:543. doi: 10.1111/j.1399-0039.1998.tb03085.x. [DOI] [PubMed] [Google Scholar]
- 51.Roccabianca P, Vernau W, Caniatti M, Moore PF. Feline large granular lymphocyte (LGL) lymphoma with secondary leukemia: primary intestinal origin with predominance of a CD3/CD8αα phenotype. Vet Pathol. 2006;43:15. doi: 10.1354/vp.43-1-15. [DOI] [PubMed] [Google Scholar]
- 52.Roccabianca P, Woo JC, Moore PF. Characterization of the diffuse mucosal associated lymphoid tissue of feline small intestine. Vet Immunol Immunopathol. 2000;75:27. doi: 10.1016/S0165-2427(00)00181-1. [DOI] [PMC free article] [PubMed] [Google Scholar]
- 53.Russell KN, Mehler SJ, Skorupskin KA. Clinical and immunohistochemical differentiation of gastrointestinal stromal tumors from leiomyosarcomas in dogs: 42 cases (1990-2003) J Am Vet Med Assoc. 2007;230:1329. doi: 10.2460/javma.230.9.1329. [DOI] [PubMed] [Google Scholar]
- 54.Sako T, Uchida E, Okamoto M. Immunohistochemical evaluation of a malignant intestinal carcinoid in a dog. Vet Pathol. 2003;40:212. doi: 10.1354/vp.40-2-212. [DOI] [PubMed] [Google Scholar]
- 55.Sharpe A, Cannon MJ, Lucke VM, Day MJ. Intestinal haemangiosarcoma in the cat: clinical and pathological features of four cases. J Small Anim Pract. 2000;41:411. doi: 10.1111/j.1748-5827.2000.tb03235.x. [DOI] [PubMed] [Google Scholar]
- 56.Sharpe NJH, Nash AS, Griffiths IR. Feline dysautonomia (the Key-Gaskell syndrome): a clinical and pathological study of forty cases. J Small Anim Pract. 1984;25:599. [Google Scholar]
- 57.Sonea IM, Jergens AE, Sacco RE. Flow cytometric analysis of colonic and small intestinal mucosal lymphocytes obtained by endoscopic biopsy in the healthy dog. Vet Immunol Immunopathol. 2000;77:103. doi: 10.1016/s0165-2427(00)00230-0. [DOI] [PubMed] [Google Scholar]
- 58.Suter MM, Palmer DG, Schenk H. Primary intestinal lymphangiectasia in three dogs: a morphological and immunopathological investigation. Vet Pathol. 1985;22:123. doi: 10.1177/030098588502200205. [DOI] [PubMed] [Google Scholar]
- 59.Takahashi T, Kadosawa T, Nagase M. Visceral mast cell tumors in dogs: 10 cases (1982-1997) J Am Vet Med Assoc. 2000;216:222. doi: 10.2460/javma.2000.216.222. [DOI] [PubMed] [Google Scholar]
- 60.Tani Y, Uchida K, Uetsuka K. Amyloid deposits in the gastrointestinal tract of aging dogs. Vet Pathol. 1997;34:415. doi: 10.1177/030098589703400505. [DOI] [PubMed] [Google Scholar]
- 61.Vaden SL, Sellon RK, Melgarejo LT. Evaluation of intestinal permeability and gluten sensitivity in soft-coated wheaten terriers with familial protein-losing enteropathy, protein-losing nephropathy, or both. Am J Vet Res. 2000;61:518. doi: 10.2460/ajvr.2000.61.518. [DOI] [PubMed] [Google Scholar]
- 62.Vail DM, Moore AS, Ogilvie GK, Volk LM. Feline lymphoma (145 cases): proliferation indices, cluster of differentiation 3 immunoreactivity, and their association with prognosis in 90 cats. J Vet Intern Med. 1998;12:349. doi: 10.1111/j.1939-1676.1998.tb02134.x. [DOI] [PubMed] [Google Scholar]
- 63.Van Kruiningen HJ, Lees GE, Hayden DW. Lipogranulomatous lymphangitis in canine intestinal lymphangiectasia. Vet Pathol. 1984;21:377. doi: 10.1177/030098588402100403. [DOI] [PubMed] [Google Scholar]
- 64.Van Vuuren M, Steinel A, Goosen T. Feline panleukopenia virus revisited: molecular characteristics and pathological lesions associated with three recent isolates. J S Afr Vet Assoc. 2000;71:140. doi: 10.4102/jsava.v71i3.702. [DOI] [PubMed] [Google Scholar]
- 65.Wales AD, Woodward MJ, Pearson GR. Attaching-effacing bacteria in animals. J Comp Pathol. 2005;132:1. doi: 10.1016/j.jcpa.2004.09.005. [DOI] [PMC free article] [PubMed] [Google Scholar]
- 66.Waly N, Gruffydd-Jones TJ, Stokes CR, Day MJ. The distribution of leucocyte subsets in the small intestine of normal cats. J Comp Pathol. 2001;124:172. doi: 10.1053/jcpa.2000.0450. [DOI] [PubMed] [Google Scholar]
- 67.Waly NE, Stokes CR, Gruffydd-Jones TJ, Day MJ. Immune cell populations in the duodenal mucosa of cats with inflammatory bowel disease. J Vet Intern Med. 2004;18:816. doi: 10.1892/0891-6640(2004)18<816:icpitd>2.0.co;2. [DOI] [PubMed] [Google Scholar]
- 68.Waly NE, Gruffydd-Jones TJ, Stokes CR, Day MJ. Immunohistochemical diagnosis of alimentary lymphomas and severe intestinal inflammation in cats. J Comp Pathol. 2005;133:253. doi: 10.1016/j.jcpa.2005.05.004. [DOI] [PubMed] [Google Scholar]
- 69.Werner JA, Woo JC, Vernau W. Characterization of feline immunoglobulin heavy chain variable region genes for the molecular diagnosis of B-cell neoplasia. Vet Pathol. 2005;42:596. doi: 10.1354/vp.42-5-596. [DOI] [PubMed] [Google Scholar]
- 70.Willard MD, Helman G, Fradkin JM. Intestinal crypt lesions associated with protein-losing enteropathy in the dog. J Vet Intern Med. 2000;14:298. doi: 10.1892/0891-6640(2000)014<0298:iclawp>2.3.co;2. [DOI] [PubMed] [Google Scholar]
- 71.Willard MD, Jergens AE, Duncan RD. Interobserver variation among histopathologic evaluations of intestinal lesions from dogs and cats. J Am Vet Med Assoc. 2002;220:1177. doi: 10.2460/javma.2002.220.1177. [DOI] [PubMed] [Google Scholar]
- 72.Willard MD, Lovering SL, Cohen ND, Weeks BR. Quality of tissue specimens obtained endoscopically from the duodenum of dogs and cats. J Am Vet Med Assoc. 2001;219:474. doi: 10.2460/javma.2001.219.474. [DOI] [PubMed] [Google Scholar]
- 73.Woo JC, Roccabianca P, van Stijn A, Moore PF. Characterization of a feline homologue of the αE integrin subunit (CD103) reveals high specificity for intra-epithelial lymphocytes. Vet Immunol Immunopathol. 2002;85:9. doi: 10.1016/s0165-2427(01)00394-4. [DOI] [PubMed] [Google Scholar]
- 74.Yamasaki K, Suematsu H, Takahashi T. Comparison of gastric and duodenal lesions in dogs and cats with and without lymphocytic-plasmacytic enteritis. J Am Vet Med Assoc. 1996;209:95. [PubMed] [Google Scholar]
Colon
- 1.Marks SL, Kather EJ. Bacterial-associated diarrhea in the dog: A critical appraisal. Vet Clin North Am Small Anim Pract. 2003;33:1029. doi: 10.1016/s0195-5616(03)00091-3. [DOI] [PubMed] [Google Scholar]
- 2.Weese JS. Bacterial enteritis in dogs and cats: Diagnosis, therapy and zoonotic potential. Vet Clin North Am Small Anim Pract. 2011;41:287. doi: 10.1016/j.cvsm.2010.12.005. [DOI] [PubMed] [Google Scholar]
- 3.Spinato MT, Barker IK, Houston DM. A morphometric study of the canine colon: Comparison of control dogs and cases of colonic disease. Can J Vet Res. 1990;54:477. [PMC free article] [PubMed] [Google Scholar]
- 4.Roth L, Walton AM, Leib MS, Burrows CF. A grading system for lymphocytic plasmacytic colitis in dogs. J Vet Diagn Invest. 1990;2:257. doi: 10.1177/104063879000200401. [DOI] [PubMed] [Google Scholar]
- 5.Willard MD, Mansell J, Fosgate GT. Effect of sample quality on the sensitivity of endoscopic biopsy for detecting gastric and duodenal lesions in dogs and cats. J Vet Intern Med. 2008;22:1084. doi: 10.1111/j.1939-1676.2008.0149.x. [DOI] [PubMed] [Google Scholar]
- 6.Jergens AE, Gamet Y, Moore FM. Colonic lymphocyte and plasma cell populations in dogs with lymphocytic-plasmacytic colitis. Am J Vet Res. 1999;60:515. [PubMed] [Google Scholar]
- 7.Jergens AE, Gamet Y, Niyo Y. Immunohistochemical characterization of immunoglobulin-containing cells and T cells in the colonic mucosa of healthy dogs. Am J Vet Res. 1998;59:552. [PubMed] [Google Scholar]
- 8.Day MJ, Bilzer T, Mansell J. Histopathological standards for the diagnosis of gastrointestinal inflammation in endoscopic biopsy samples from the dog and cat: A report from the world small animal veterinary association gastrointestinal standardization group. J Comp Pathol. 2008;138(Suppl 1):S1. doi: 10.1016/j.jcpa.2008.01.001. [DOI] [PubMed] [Google Scholar]
- 9.Dennis JS, Kruger JM, Mullaney TP. Lymphocytic/plasmacytic colitis in cats: 14 cases (1985-1990) J Am Vet Med Assoc. 1993;202:313. [PubMed] [Google Scholar]
- 10.Yaeger MJ, Gookin JL. Histologic features associated with Tritrichomonas foetus-induced colitis in domestic cats. Vet Pathol. 2005;42:797. doi: 10.1354/vp.42-6-797. [DOI] [PubMed] [Google Scholar]
- 11.Gomez JA, Russell SW, Trowbridge JO. Canine histiocytic ulcerative colitis. an ultrastructural study of the early mucosal lesion. Am J Dig Dis. 1977;22:485. doi: 10.1007/BF01072500. [DOI] [PubMed] [Google Scholar]
- 12.Russell SW, Gomez JA, Trowbridge JO. Canine histiocytic ulcerative colitis. the early lesion and its progression to ulceration. Lab Invest. 1971;25:509. [PubMed] [Google Scholar]
- 13.Hostutler RA, Luria BJ, Johnson SE. Antibiotic-responsive histiocytic ulcerative colitis in 9 dogs. J Vet Intern Med. 2004;18:499. doi: 10.1892/0891-6640(2004)18<499:ahucid>2.0.co;2. [DOI] [PubMed] [Google Scholar]
- 14.Mansfield CS, James FE, Craven M. Remission of histiocytic ulcerative colitis in boxer dogs correlates with eradication of invasive intramucosal Escherichia coli. J Vet Intern Med. 2009;23:964. doi: 10.1111/j.1939-1676.2009.0363.x. [DOI] [PubMed] [Google Scholar]
- 15.Gookin JL, Stone MR, Yaeger MJ. Fluorescence in situ hybridization for identification of Tritrichomonas foetus in formalin-fixed and paraffin-embedded histological specimens of intestinal trichomoniasis. Vet Parasitol. 2010;172:139. doi: 10.1016/j.vetpar.2010.04.014. [DOI] [PubMed] [Google Scholar]
- 16.Harvey CJ, Lopez JW, Hendrick MJ. An uncommon intestinal manifestation of feline infectious peritonitis: 26 cases (1986-1993) J Am Vet Med Assoc. 1996;209:1117. [PubMed] [Google Scholar]
- 17.Helman RG, Oliver J., 3rd Pythiosis of the digestive tract in dogs from Oklahoma. J Am Anim Hosp Assoc. 1999;35:111. doi: 10.5326/15473317-35-2-111. [DOI] [PubMed] [Google Scholar]
- 18.Holt PE, Lucke VM. Rectal neoplasia in the dog: A clinicopathological review of 31 cases. Vet Rec. 1985;116:400. doi: 10.1136/vr.116.15.400. [DOI] [PubMed] [Google Scholar]
- 19.Seiler RJ. Colorectal polyps of the dog: A clinicopathologic study of 17 cases. J Am Vet Med Assoc. 1979;174:72. [PubMed] [Google Scholar]
- 20.Frost D, Lasota J, Miettinen M. Gastrointestinal stromal tumors and leiomyomas in the dog: A histopathologic, immunohistochemical, and molecular genetic study of 50 cases. Vet Pathol. 2003;40:42. doi: 10.1354/vp.40-1-42. [DOI] [PubMed] [Google Scholar]
- 21.Maas CP, ter Haar G, van der Gaag I, Kirpensteijn J. Reclassification of small intestinal and cecal smooth muscle tumors in 72 dogs: Clinical, histologic, and immunohistochemical evaluation. Vet Surg. 2007;36:302. doi: 10.1111/j.1532-950X.2007.00271.x. [DOI] [PubMed] [Google Scholar]
- 22.Russell KN, Mehler SJ, Skorupski KA. Clinical and immunohistochemical differentiation of gastrointestinal stromal tumors from leiomyosarcomas in dogs: 42 cases (1990-2003) J Am Vet Med Assoc. 2007;230:1329. doi: 10.2460/javma.230.9.1329. [DOI] [PubMed] [Google Scholar]
Pancreas
- 1.Wiberg ME, Saari SAM, Westermarck E. Exocrine pancreatic atrophy in German Shepherd dogs and rough-coated collies: An end result of lymphocytic pancreatitis. Vet Pathol. 1999;36:530. doi: 10.1354/vp.36-6-530. [DOI] [PubMed] [Google Scholar]
- 2.Cullen JM. Liver, biliary system, and exocrine pancreas. In: McGavin MD, Zachary JF, editors. Pathologic Basis of Veterinary Disease. ed 4. Mosby; St. Louis: 2007. p. 393. [Google Scholar]
- 3.Charles JA. Pancreas. In: Maxie MG, editor. ed 5. Vol. 2. Saunders; Philadelphia: 2007. p. 389. (Jubb, Kennedy, and Palmer's Pathology of Domestic Animals). [Google Scholar]
- 4.Steiner JM, Williams DA. Serum feline trypsinlike immunoreactivity in cats with exocrine pancreatic insufficiency. J Vet Intern Med. 2000;14:627. doi: 10.1892/0891-6640(2000)014<0627:sftiic>2.3.co;2. [DOI] [PubMed] [Google Scholar]
- 5.De Cock HE, Forman MA, Farver TB. Prevalence and histopathologic characteristics of pancreatitis in cats. Vet Pathol. 2007;44:39. doi: 10.1354/vp.44-1-39. [DOI] [PubMed] [Google Scholar]
- 6.Ferreri JA, Hardam E, Kimmel SE. Clinical differentiation of feline acute necrotizing and chronic nonsuppurative pancreatitis. J Am Vet Med Assoc. 2003;223:469. doi: 10.2460/javma.2003.223.469. [DOI] [PubMed] [Google Scholar]
- 7.Newman SJ, Steiner JM, Woosley K. Histologic assessment and grading of the exocrine pancreas in the dog. J Vet Diagn Invest. 2006;18:115. doi: 10.1177/104063870601800119. [DOI] [PubMed] [Google Scholar]
- 8.Newman S, Steiner J, Woosley K. Localization of pancreatic inflammation and necrosis in dogs. J Vet Intern Med. 2004;18:488. doi: 10.1892/0891-6640(2004)18<488:lopian>2.0.co;2. [DOI] [PubMed] [Google Scholar]
- 9.Hess RS, Saunders HM, Van Winkle TJ. Clinical, clinicopathologic, radiologic and ultrasonographic abnormalities in dogs with fatal acute pancreatitis: 70 cases (1986-1995) J Am Vet Med Assoc. 1998;213:665. [PubMed] [Google Scholar]
- 10.Hess RS, Kass PH, Shofer FS. Evaluation of risk factors for fatal acute pancreatitis in dogs. J Am Vet Med Assoc. 1999;214:46. [PubMed] [Google Scholar]
- 11.Hill RC, Van Winkle TJ. Retrospective study of acute pancreatitis in the cat: 40 cases (1976-89) J Vet Intern Med. 1993;7:25. doi: 10.1111/j.1939-1676.1993.tb03165.x. [DOI] [PubMed] [Google Scholar]
- 12.Saunders HM, VanWinkle TJ, Drobatz K. Ultrasonographic and radiographic findings in cats with clinical, necropsy, and histologic evidence of pancreatic necrosis. J Am Vet Med Assoc. 2002;221:1724. doi: 10.2460/javma.2002.221.1724. [DOI] [PubMed] [Google Scholar]
- 13.Van Winkle TJ, Bruce E. Thrombosis of the portal vein in eleven dogs. Vet Pathol. 1993;30:28. doi: 10.1177/030098589303000104. [DOI] [PubMed] [Google Scholar]
- 14.VanEnkevort BA, O’Brien RT, Young KM. Pancreatic pseudocysts in 4 dogs and 2 cats: ultrasonographic and clinicopathologic findings. J Vet Intern Med. 1999;13:30. [PubMed] [Google Scholar]
- 15.Newman SJ, Steiner JM, Woosley K. Correlation of age and incidence of pancreatic exocrine nodular hyperplasia in the dog. Vet Pathol. 2005;42:510. doi: 10.1354/vp.42-4-510. [DOI] [PubMed] [Google Scholar]
- 16.Head KW, Else RW, Dubielzig RR. Tumors of the Alimentary Tract. In: Meuten DJ, editor. Tumors of Domestic Animals. ed 5. Iowa State Press; Ames: 2002. p. 478. [Google Scholar]
- 17.Head KW, Cullen JM, Dubielzig RR. Histologic Classification of Tumors of the Alimentary System of Domestic Animals. Air Force Institute of pathology; Washington, DC: 2003. Histologic classification of tumors of the pancreas of domestic animals; p. 111. [Google Scholar]
- 18.Steiner JM, Newman SJ, Xenoulis PG. Histologic findings and minimally-invasive serum markers in dogs with neoplasia involving the pancreas. J Vet Intern Med. 2007;21:650. [Google Scholar]
Hepatobiliary
- 1.Malarkey DE, Johnson K, Ryan L. New insights into functional aspects of liver morphology. Toxicol Pathol. 2005;33:27. doi: 10.1080/01926230590881826. [DOI] [PubMed] [Google Scholar]
- 2.Matsumoto T, Kawakami M. The unit-concept of hepatic parenchyma—a re-examination based on angioarchitectural studies. Acta Pathol Jpn. 1982;32(Suppl 2):285. [PubMed] [Google Scholar]
- 3.Cole TL, Center SA, Flood SN. Diagnostic comparison of needle and wedge biopsy specimens of the liver in dogs and cats. J Am Vet Med Assoc. 2002;220:1483. doi: 10.2460/javma.2002.220.1483. [DOI] [PubMed] [Google Scholar]
- 4.Johnston AN, Center SA, McDonough SP. Influence of biopsy specimen size, tissue fixation, and assay variation on copper, iron, and zinc concentrations in canine livers. Am J Vet Res. 2009;70:1502. doi: 10.2460/ajvr.70.12.1502. [DOI] [PubMed] [Google Scholar]
- 5.van den Ingh TS, Rothuizen J, Meyer HP. Circulatory disorders of the liver in dogs and cats. Vet Q. 1995;17:70. doi: 10.1080/01652176.1995.9694536. [DOI] [PubMed] [Google Scholar]
- 6.Shermerhorn T, Center SA, Dykes NL. Characterization of a hepatoportal microvascular dysplasia in a kindred of cairn terriers. J Vet Intern Med. 1996;10:219. doi: 10.1111/j.1939-1676.1996.tb02053.x. [DOI] [PubMed] [Google Scholar]
- 7.Rothuizen J, Bunch SE, Charles J. Elsevier Saunders; Philadelphia: 2006. Standards for Clinical and Histological Diagnosis of Canine and Feline Liver Diseases (WSAVA) [Google Scholar]
- 8.Moore PF, Whiting PG. Hepatic lesions associated with intrahepatic arterioportal fistulae in dogs. Vet Pathol. 1986;23:57. doi: 10.1177/030098588602300109. [DOI] [PubMed] [Google Scholar]
- 9.Gorlinger S, Rothuizen J, Bunch S. Congenital dilatation of the bile ducts (Caroli's disease) in young dogs. J Vet Intern Med. 2003;17:28. doi: 10.1892/0891-6640(2003)017<0028:cdotbd>2.3.co;2. [DOI] [PubMed] [Google Scholar]
- 10.Zandvliet MM, Szatmari V, van den Ingh T. Acquired portosystemic shunting in two cats secondary to congenital hepatic fibrosis. J Vet Intern Med. 2005;19:765. doi: 10.1892/0891-6640(2005)19[765:apsics]2.0.co;2. [DOI] [PubMed] [Google Scholar]
- 11.Portmann BC, Nakanuma Y. Diseases of the bile ducts. In: McSween RNM, Burt AD, Portmann BC, editors. Pathology of the Liver. Churchill Livingstone; London: 2002. p. 435. [Google Scholar]
- 12.van den Ingh TS, Rothuizen J, van den Brom WE. Extrahepatic cholestasis in the dog and the differentiation of extrahepatic and intrahepatic cholestasis. Vet Q. 1986;8:150. doi: 10.1080/01652176.1986.9694034. [DOI] [PubMed] [Google Scholar]
- 13.Prasse KW, Mahaffey EA, DeNovo R. Chronic lymphocytic cholangitis in three cats. Vet Pathol. 1982;19:99. doi: 10.1177/030098588201900201. [DOI] [PubMed] [Google Scholar]
- 14.van den Ingh TS, Rothuizen J, van Zinnicq Bergman HM. Destructive cholangiolitis in seven dogs. Vet Q. 1988;10:240. doi: 10.1080/01652176.1988.9694179. [DOI] [PubMed] [Google Scholar]
- 15.Aguirre AL, Center SA, Randolph JF. Gallbladder disease in shetland sheepdogs: 38 cases (1995-2005) J Am Vet Med Assoc. 2007;231:79. doi: 10.2460/javma.231.1.79. [DOI] [PubMed] [Google Scholar]
- 16.Holt DE, Mehler S, Mayhew PD. Canine gallbladder infarction: 12 cases (1993-2003) Vet Pathol. 2004;41:416. doi: 10.1354/vp.41-4-416. [DOI] [PubMed] [Google Scholar]
- 17.Sepesy LM, Center SA, Randolph JF. Vacuolar hepatopathy in dogs: 336 cases (1993-2005) J Am Vet Med Assoc. 2006;229:246. doi: 10.2460/javma.229.2.246. [DOI] [PubMed] [Google Scholar]
- 18.Fox JG, Drolet R, Higgins R. Helicobacter canis isolated from a dog liver with multifocal necrotizing hepatitis. J Clin Microbiol. 1996;34:2479. doi: 10.1128/jcm.34.10.2479-2482.1996. [DOI] [PMC free article] [PubMed] [Google Scholar]
- 19.Gillespie TN, Washabau RJ, Goldschmidt MH. Detection of Bartonella henselae and Bartonella clarridgeiae DNA in hepatic specimens from two dogs with hepatic disease. J Am Vet Med Assoc. 2003;222:47. doi: 10.2460/javma.2003.222.47. [DOI] [PubMed] [Google Scholar]
- 20.Dubey JP, Chapman JL, Rosenthal BM. Clinical Sarcocystis neurona, Sarcocystis canis, Toxoplasma gondii, and Neospora caninum infections in dogs. Vet Parasitol. 2006;137:36. doi: 10.1016/j.vetpar.2005.12.017. [DOI] [PubMed] [Google Scholar]
- 21.Villar D, Buck WB, Gonzalez JM. Ibuprofen, aspirin and acetaminophen toxicosis and treatment in dogs and cats. Vet Hum Toxicol. 1998;40:156. [PubMed] [Google Scholar]
- 22.Dunayer EK, Gwaltney-Brant SM. Acute hepatic failure and coagulopathy associated with xylitol ingestion in eight dogs. J Am Vet Med Assoc. 2006;229:1113. doi: 10.2460/javma.229.7.1113. [DOI] [PubMed] [Google Scholar]
- 23.Newberne PM, Butler WH. Acute and chronic effects of aflatoxin on the liver of domestic and laboratory animals: A review. Cancer Res. 1969;29:236. [PubMed] [Google Scholar]
- 24.Savides MC, Oehme FW, Nash SL. The toxicity and biotransformation of single doses of acetaminophen in dogs and cats. Toxicol Appl Pharmacol. 1984;74:26. doi: 10.1016/0041-008x(84)90266-7. [DOI] [PubMed] [Google Scholar]
- 25.Puschner B, Rose HH, Filigenzi MS. Diagnosis of amanita toxicosis in a dog with acute hepatic necrosis. J Vet Diagn Invest. 2007;19:312. doi: 10.1177/104063870701900317. [DOI] [PubMed] [Google Scholar]
- 26.Trepanier LA. Idiosyncratic toxicity associated with potentiated sulfonamides in the dog. J Vet Pharmacol Ther. 2004;27:129. doi: 10.1111/j.1365-2885.2004.00576.x. [DOI] [PubMed] [Google Scholar]
- 27.Twedt DC, Diehl KJ, Lappin MR. Association of hepatic necrosis with trimethoprim sulfonamide administration in 4 dogs. J Vet Intern Med. 1997;11:20. doi: 10.1111/j.1939-1676.1997.tb00068.x. [DOI] [PubMed] [Google Scholar]
- 28.Bunch SE. Hepatotoxicity associated with pharmacologic agents in dogs and cats. Vet Clin North Am Small Anim Pract. 1993;23:659. doi: 10.1016/s0195-5616(93)50311-x. [DOI] [PubMed] [Google Scholar]
- 29.Poldervaart JH, Favier RP, Penning LC. Primary hepatitis in dogs: A retrospective review (2002-2006) J Vet Intern Med. 2009;23:72. doi: 10.1111/j.1939-1676.2008.0215.x. [DOI] [PubMed] [Google Scholar]
- 30.Boisclair J, Dore M, Beauchamp G. Characterization of the inflammatory infiltrate in canine chronic hepatitis. Vet Pathol. 2001;38:628. doi: 10.1354/vp.38-6-628. [DOI] [PubMed] [Google Scholar]
- 31.Thornburg LP. A perspective on copper and liver disease in the dog. J Vet Diagn Invest. 2000;12:101. doi: 10.1177/104063870001200201. [DOI] [PubMed] [Google Scholar]
- 32.Thornburg LP, Shaw D, Dolan M. Hereditary copper toxicosis in West Highland white terriers. Vet Pathol. 1986;23:148. doi: 10.1177/030098588602300207. [DOI] [PubMed] [Google Scholar]
- 33.Haywood S, Rutgers HC, Christian MK. Hepatitis and copper accumulation in Skye terriers. Vet Pathol. 1988;25:408. doi: 10.1177/030098588802500602. [DOI] [PubMed] [Google Scholar]
- 34.Webb CB, Twedt DC, Meyer DJ. Copper-associated liver disease in Dalmatians: a review of 10 dogs (1998-2001) J Vet Intern Med. 2002;16:665. doi: 10.1892/0891-6640(2002)016<0665:cldida>2.3.co;2. [DOI] [PubMed] [Google Scholar]
- 35.Mandigers PJ, van den Ingh TS, Bode P. Association between liver copper concentration and subclinical hepatitis in doberman pinschers. J Vet Intern Med. 2004;18:647. doi: 10.1892/0891-6640(2004)18<647:ablcca>2.0.co;2. [DOI] [PubMed] [Google Scholar]
- 36.Smedley R, Mullaney T, Rumbeiha W. Copper-associated hepatitis in Labrador retrievers. Vet Pathol. 2009;46:484. doi: 10.1354/vp.08-VP-0197-S-FL. [DOI] [PubMed] [Google Scholar]
- 37.Hoffmann G, Heuven HC, Leegwater PA. Heritabilities of copper-accumulating traits in Labrador retrievers. Anim Genet. 2008;39:454. doi: 10.1111/j.1365-2052.2008.01722.x. [DOI] [PubMed] [Google Scholar]
- 38.Watson PJ. Chronic hepatitis in dogs: A review of current understanding of the aetiology, progression and treatment. Vet J. 2003;167:228. doi: 10.1016/S1090-0233(03)00118-7. [DOI] [PubMed] [Google Scholar]
- 39.Rutgers HC, Haywood S, Kelly DF. Idiopathic hepatic fibrosis in 15 dogs. Vet Rec. 1993;133:115. doi: 10.1136/vr.133.5.115. [DOI] [PubMed] [Google Scholar]
- 40.Farrar ET, Washabau RJ, Saunders HM. Hepatic abscesses in dogs: 14 cases (1982-1994) J Am Vet Med Assoc. 1996;208:243. [PubMed] [Google Scholar]
- 41.Sergeeff JS, Armstrong PJ, Bunch SE. Hepatic abscesses in cats: 14 cases (1985-2002) J Vet Intern Med. 2004;18:295. doi: 10.1892/0891-6640(2004)18<295:haicc>2.0.co;2. [DOI] [PubMed] [Google Scholar]
- 42.Bergman JR. Nodular hyperplasia in the liver of the dog: An association with changes in the ito cell population. Vet Pathol. 1985;22:427. doi: 10.1177/030098588502200501. [DOI] [PubMed] [Google Scholar]
- 43.Patnaik AK, Hurvitz AI, Lieberman PH. Canine hepatocellular carcinoma. Vet Pathol. 1981;18:427. doi: 10.1177/030098588101800402. [DOI] [PubMed] [Google Scholar]
- 44.Bastianello SS. A survey on neoplasia in domestic species over a 40-year period from 1935 to 1974 in the Republic of South Africa. VI. Tumours occurring in dogs. Onderstepoort J Vet Res. 1983;50:199. [PubMed] [Google Scholar]
- 45.Patnaik AK, Lieberman PH, Erlandson RA. Hepatobiliary neuroendocrine carcinoma in cats: a clinicopathologic, immunohistochemical, and ultrastructural study of 17 cases. Vet Pathol. 2005;42:331. doi: 10.1354/vp.42-3-331. [DOI] [PubMed] [Google Scholar]
- 46.Patnaik AK, Lieberman PH, Hurvitz AI. Canine hepatic carcinoids. Vet Pathol. 1981;18:445. doi: 10.1177/030098588101800404. [DOI] [PubMed] [Google Scholar]
